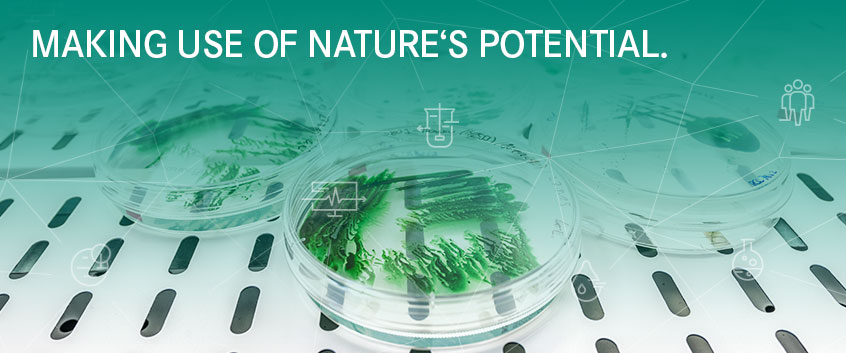
MAKING USE OF NATURE&rsquo;S POTENTIAL

Research Unit
Sustainable Ecotechnologies
- In order to produce resource- and energy-efficiently, cycles must be closed.
- The consumption of fossil organic and scarce inorganic raw materials must be reduced and fossil energy sources must be replaced by renewable energies.
- Harmful substances must not enter the environment unhindered. Where this does happen, technologies must be available to eliminate them.
- Urban infrastructure must adapt our cities to the conditions of a warmer climate.
Sustainable Circular Economy – The focus here is on sustainable biotechnological production of energy sources (hydrogen, biogas, liquid fuels) and chemical building blocks for the polymer, chemical and pharmaceutical industries from renewable resources. Processes are used that require minimal land use. At the same time, biotechnological options are being developed to minimize anthropogenic emissions in the spirit of a circular bioeconomy.
This research direction creates and bundles the RU's biotechnological know-how and strives for technology maturity that allows transfer to business and industrial players. The integration of industrial partners mainly takes place via established networks and joint third-party funded projects (see e.g. RWTec). It will be systematically expanded with the help of the UFZ's Knowledge and Technology Transfer Department in order to ensure access to research and development results for companies.
Creating a climate-resilient, low-impact, and stressor-minimized human environment in rural and urban areas requires knowledge of the behavior of chemicals in natural and engineered systems as well as technologies for their removal. Climate-resilient, energy- and water-efficient cities require technologies that close local water cycles and improve microclimate while reducing the energy demand of urban infrastructures.
The development and implementation of such technologies requires the early involvement of practice partners from politics, administration and (municipal) companies. Successful examples (see e.g. Leipzig BlauGrün) serve as a model for future co-design processes along this research direction.
The research directions are organized in the integration platform (IP) 'Tapping nature's potential - TapNature' (IP TapNature) and contribute to Topics 7, 5 and 9 of the current research program 'Changing Earth: Sustaining our Future'.
News
Highlights from the Research Unit

Consortium of Helmholtz-Centre for Environmental Research GmbH – UFZ and Deutsches Biomasse Forschungszentrum – DBFZ will collaborate with Cosun Beet Company to further develop the Capraferm® process and realize project idea of turning waste to value by converting beet leaves into carboxylic acids.
Further information
SmartManure - Coupling circular economy principles with environmental hazard management for liquid manure-based sustainable agriculture CLEANER - Fostering pollutant-sink functions of Blue-Green Infrastructures
FATE - Fate and effects of antibiotics from sources to sinks
finished: STROMER - Sustainable Transformation by Electrochemical Reactions
2026 (92)
Two-bilayer polyelectrolyte multilayered nanofiltration membranes for highly efficient removal of PFAS from water
J. Membr. Sci. 744 , art. 125180
10.1016/j.memsci.2026.125180
Plant cover rather than species richness drives nematode community structure and function on extensive and semi-intensive roof greening [Data set]
Zenodo
10.5281/zenodo.18487303
Plant cover rather than species richness drives nematode community structure and function on extensive and semi-intensive roof greening
Basic Appl. Ecol. 91 , 74 - 84
10.1016/j.baae.2026.01.007
Microbial electrosynthesis reshapes energy metabolism and physiology in Clostridium ljungdahlii
Microb. Biotechnol. 19 (6), e70398
10.1111/1751-7915.70398
HVRLocator: A computationally efficient tool for identifying hypervariable regions in 16S rRNA big datasets
GigaScience 15 , giag040
10.1093/gigascience/giag040
Conversion of CO2 into valuable products: engineering the PirC-PGAM switch in cyanobacteria to direct carbon flux into desired products
Microb. Cell. Fact. 25 , art. 128
10.1186/s12934-026-03033-7
Assessment of biocide emissions from façade coatings with organic binders: Testing an innovative sprinkler system for time-resolved leaching experiments
J. Hazard. Mater. Adv. 22 , art. 101144
10.1016/j.hazadv.2026.101144
Cross-feeding drives degradation of phthalate ester plasticizers in a bacterial consortium
Front. Microbiol. 16 , art. 1757196
10.3389/fmicb.2025.1757196
Cross-feeding drives degradation of phthalate ester plasticizers in a bacterial consortium [dataset]
figshare
10.6084/m9.figshare.31042420
Enhancing sulfate-rich wastewater treatment through polyvinyl alcohol -immobilized sulfidogenic granules: Optimization of reactor configuration and bioaugmentation strategies
J. Environ. Chem. Eng. 14 (2), art. 121731
10.1016/j.jece.2026.121731
Regulating interfacial electron flow in Cu2S@Co3S4 Core–Shell heterostructures promoting H2O2 activation for singlet oxygen generation to efficiently degrade tetracycline
Sep. Purif. Technol. 394, Part 3 , art. 137618
10.1016/j.seppur.2026.137618
Urban blocks enable data-reduced, hydraulically sound planning for combined sewer overflow mitigation
Water Res. X 30 , art. 100466
10.1016/j.wroa.2025.100466
UrbanWaterBlocks: A python tool for block-based urban water management
Sust. Cities Soc. 140 , art. 107244
10.1016/j.scs.2026.107244
UrbanWaterBlocks
Version: v0.1 Zenodo
10.5281/zenodo.17396242
Soil microbial metabolism: Insights from heat, CO2 emission and isotope analysis using a novel macrocalorespirometer
Soil Biol. Biochem. 212 , art. 109994
10.1016/j.soilbio.2025.109994
Rising temperature and atmospheric CO2 combine to antagonistically alter Cd mobility and biogeochemistry in an agricultural soil
Environ. Pollut. 390 , art. 127508
10.1016/j.envpol.2025.127508
In-situ product recovery in microfluidic bioreactors
Curr. Opin. Biotechnol. 99 , art. 103498
10.1016/j.copbio.2026.103498
How mutagenesis and laboratory conditions affect the genome of the metal-resistant bacterium Cupriavidus metallidurans strain CH34
J. Bacteriol. 208 (5), e00121-26
10.1128/jb.00121-26
Mechanistic insights into iron sulfide surface-mediated homolytic peroxydisulfate cleavage and high-valent iron-oxo formation in water
Chem. Eng. J. 527 , art. 171796
10.1016/j.cej.2025.171796
Efficient removal of perchlorate by a quaternary ammonium-functionalized hydrogel: Performance and mechanisms
J. Environ. Chem. Eng. 14 (3), art. 122169
10.1016/j.jece.2026.122169
Transport and survival of marine tracer phages in topsoil at field conditions
Environ. Sci. Technol. 60 (1), 677 - 687
10.1021/acs.est.5c12252
Harnessing the Co-Fe synergy: A novel Co-doped FeOCl for peracetic acid activation to efficiently degrade carbamazepine
Colloid Surf. A-Physicochem. Eng. Asp. 742, Part 1 , art. 140410
10.1016/j.colsurfa.2026.140410
A One Health perspective on bacterial extracellular vesicles as mediators of antimicrobial resistance spread
ISME Commun. 6 (1), ycag052
10.1093/ismeco/ycag052
Mitigating tetracyclines in struvite recovery from swine wastewater by respectively applying unactivated and activated peroxymonosulfate oxidation
J. Hazard. Mater. 501 , art. 140795
10.1016/j.jhazmat.2025.140795
Utilization of phosphate-responsive promoters for auto-inducible management of biotechnological processes based on cyanobacteria
Metab. Eng. Commun. 22 , e00278
10.1016/j.mec.2026.e00278
Dataset for "Deciphering guanidine assimilation and riboswitch-based gene regulation in cyanobacteria for synthetic biology applications"
Zenodo
10.5281/zenodo.20529017
Integrating electrochemical and microbial processes for CO2 conversion at scale
Curr. Opin. Chem. Eng. 51 , art. 101221
10.1016/j.coche.2025.101221
Scaling up electrochemical CO2 reduction to formate through comparative reactor analysis
Ind. Chem. Mater. 4 , 260 - 275
10.1039/D5IM00056D
Engineering cyanobacteria for high-yield photosynthetic isoprene production with long-term phenotypic stability
Plant Biotechnol. J. 24 (3), 1014 - 1030
10.1111/pbi.70395
Biodegradable polybutylene adipate terephthalate (PBAT) microplastics cause more toxic effects on winter wheat in the presence of Trichoderma citrinoviride and 2,4-D than low-density polyethylene (LDPE)
Agronomy-Basel 16 (2), art. 182
10.3390/agronomy16020182
Exploring ectoine production from methanol, formate, and electrochemically produced formate by Methyloligella halotolerans
Eng. Life Sci. 26 (1), e70063
10.1002/elsc.70063
Rapid growth of thermophilic bacteria during a high-temperature aquifer thermal energy storage (HT-ATES) field experiment
Water Res. 288, Part A , art. 124599
10.1016/j.watres.2025.124599
Sequential exposure to anoxic/oxic conditions leads to biotransformation and reduced sitagliptin toxicity in urban hyporheic zones
J. Hazard. Mater. 504 , art. 141299
10.1016/j.jhazmat.2026.141299
Proteomic data of Nitratidesulfovibrio vulgaris Hildenborough
PRoteomics IDEntifications Database (PRIDE)
10.6019/PXD068774
Physiological characterization of anaerobic cometabolic transformation of sulfamethoxazole by Nitratidesulfovibrio vulgaris Hildenborough
Appl. Microbiol. Biotechnol. 110 , art. 129
10.1007/s00253-026-13792-3
A simulation-based case study on integrating photovoltaic energy supply with electrochemical CO2 reduction
Front. Energy Res. 14 , art. 1720659
10.3389/fenrg.2026.1720659
Electrifying food fermentations to promote sustainability
Trends Biotechnol. 44 (2), 303 - 314
10.1016/j.tibtech.2025.07.001
Developing an E. coli heterologous expression system for characterizing a marine debrominase from Roseobacter sp.
Appl. Environ. Microb. 92 (4), e01980-25
10.1128/aem.01980-25
Long-term operational strategy of microalgal-bacterial granular sludge towards strengthened sulfadiazine antimicrobial resistance control
J. Hazard. Mater. 504 , art. 141277
10.1016/j.jhazmat.2026.141277
Microalgae-mediated shaping of bacterial communities enhances antibiotic removal and antibiotic resistance control
Bioresour. Technol. 441 , art. 133577
10.1016/j.biortech.2025.133577
Direct real-time determination of photosynthetic efficiency by photo-calorespirometry using Synochocystis sp. PCC 6803 as model cyanobacterium
Bioresour. Technol. 439 , art. 133226
10.1016/j.biortech.2025.133226
Structural basis of membrane potential coupled vectorial CO2 hydration by the DAB2 complex in chemolithoautotrophs
Nat. Commun. 17 , art. 4071
10.1038/s41467-026-72558-7
A double-staining automated flow cytometry method for real-time monitoring of bacteria in continuous bioreactors
npj Syst. Biol. Appl. 12 , art. 47
10.1038/s41540-026-00694-3
Biocalorimetry for the biotechnological use of natural and synthetic macromolecules
Appl. Microbiol. Biotechnol. 110 , art. 147
10.1007/s00253-026-13871-5
Root organic exudate stimulation of greenhouse gases is offset by radial oxygen loss in mineral-dominated anoxic wetland soil
Geoderma 465 , art. 117658
10.1016/j.geoderma.2025.117658
Root exudate-induced priming of CO2 and CH4 in a thawing permafrost peatland
Soil Biol. Biochem. 216 , art. 110110
10.1016/j.soilbio.2026.110110
A data-driven machine learning platform for natural products discovery from the microbiome using integrative multiomics
Planta Med. 92 (03), 352 - 352
10.1055/s-0045-1815276
Isotopic composition (δ18O, δ2H) of the Indian Summer Monsoon in Southern Oman: A model-aided process interpretation
J. Hydrol. Reg. Stud. 64 , art. 103172
10.1016/j.ejrh.2026.103172
Experimental results of a High-Temperature-ATES field test: Induced convection, heat conduction and groundwater flow as efficiency-reducing processes
Geothermics 140 , art. 103734
10.1016/j.geothermics.2026.103734
Source-dependent structuring of hydrogen-oxidising bacterial community composition during enrichment and isolation from freshwater environments.
Microorganisms 14 (6), art. 1221
10.3390/microorganisms14061221
Low-head dam removal restores biofilm structure but not function in a temperate stream
Int. Rev. Hydrobiol. 111 (1), e70027
10.1002/iroh.70027
Endogenous versus exogenous redox-mediators in anaerobic bioelectrochemical systems: A comparative study with Pseudomonas putida
ChemElectroChem 13 (10), e70226
10.1002/celc.70226
Soil protist diversity enhances prokaryotic diversity, and regulates dominant prokaryotes and the abundance of key nitrogen cycling genes
Soil Biol. Biochem. 212 , art. 110014
10.1016/j.soilbio.2025.110014
Isotopic fractionation and masking effects during biotransformation of chlorinated ethanes
Environ. Sci. Technol. 60 (22), 15940 - 15951
10.1021/acs.est.5c14089
The concentration determines reaction efficiency of hetero-coupling of bio-based medium chain carboxylic acids by Kolbe electrolysis
ChemSusChem 19 (10), e70753
10.1002/cssc.70753
Thermal waters of the Western Bohemian Massif (Germany): geothermometry, origin and circulation
Geothermics 139 , art. 103677
10.1016/j.geothermics.2026.103677
Graphite granules as microbial electrodes: Determining the relevant surface area
J. Environ. Chem. Eng. 14 (2), art. 121897
10.1016/j.jece.2026.121897
From roads to water organisms? – Sequential extraction indicates high bioavailability of Cd, Zn and Pb from tire and road wear particles from a highway tunnel and go-kart tracks
Sci. Total Environ. 1012 , art. 181231
10.1016/j.scitotenv.2025.181231
Evaluation of H2 supplementation in in situ biomethanation using fed-batch reactors for paper industry wastewater treatment
Front. Microbiol. 17 , art. 1786024
10.3389/fmicb.2026.1786024
Experimental optimization and process modelling of the selective electrochemical hydrogenation of phenol to cyclohexanol using a non-noble metal catalyst
Chem. Eng. J. 537 , art. 176358
10.1016/j.cej.2026.176358
Making Waves:terminology and metrics for electrosorption of trace organic compounds
Water Res. 302 , art. 126164
10.1016/j.watres.2026.126164
A two-step electrochemical approach for an efficient destruction of short-chain PFAS in water
Chem. Eng. J. 531 , art. 172856
10.1016/j.cej.2026.172856
Low-cost thermistor electrodes for numbering-up thermodynamic studies on electroactive biofilms
Electrochem. Commun. 188 , art. 108188
10.1016/j.elecom.2026.108188
Slow and context-dependent: Responses to grassland extensification across a comprehensive set of ecosystem attributes
Agric. Ecosyst. Environ. 401 , art. 110277
10.1016/j.agee.2026.110277
Python code for the calculation of kinetic parameters
OPARA
10.25532/OPARA-1031
Biofunneling hydrogenated phenols into adipic acid using recombinant Pseudomonas taiwanensis VLB120
Cell Rep. Phys. Sci. 7 (2), art. 103069
10.1016/j.xcrp.2025.103069
Air emissions during destruction of PFAS-containing materials
Nat. Rev. Earth Environ. 7 (2), 181 - 198
10.1038/s43017-025-00755-x
Testing the biodegradability of difficult compounds: a future challenge for the OECD/ISO standardization
Appl. Microbiol. Biotechnol. 110 (1), art. 122
10.1007/s00253-026-13798-x
DestinE-Climate-DT/BA: v0.5.6 - GMD paper reference release
Version: v0.5.6 Zenodo
10.5281/zenodo.18755253
Ligand-specific activation trajectories dictate GPCR signalling in cells
Nature 650 , 1053 - 1062
10.1038/s41586-025-09963-3
Synechocystis sp. PCC 6803 shows high cell cycle dynamics reflected by an extraordinary genome copy number variation
Microb. Cell. Fact. 25 , art. 113
10.1186/s12934-026-02982-3
Data set for "Synechocystis sp. PCC 6803 shows high cell cycle dynamics reflected by an extraordinary genome copy number variation" [Data set]
Zenodo
10.5281/zenodo.16778049
Mineral nutrient acquisition under stress: Sensing, signaling, and transportation
Plant Sci. 368 , art. 113166
10.1016/j.plantsci.2026.113166
Corrigendum to “Carbon and energy utilization in microbial cell extracts from soil” [Eur. J. Soil Biol. 124 (2025) 103713]
Eur. J. Soil Biol. 128 , art. 103801
10.1016/j.ejsobi.2025.103801
The small protein SbtC is a functional component of the CO2 concentrating mechanism in Synechocystis sp. PCC 6803
Plant Physiol. 201 (1), kiag246
10.1093/plphys/kiag246
Decoding microbial reductive dechlorination of 209 polychlorinated biphenyl congeners through experiment-aided quantum chemistry and machine learning
Environ. Sci. Technol. 60 (17), 13099 - 13108
10.1021/acs.est.5c16226
Temporal decoupling of metal(loid) binding and microbial adaptation in arsenic and cadmium contaminated soils under changing climate
J. Hazard. Mater. 501 , art. 140787
10.1016/j.jhazmat.2025.140787
Establishment of a single-cell minimal medium: A case study for microfluidic cultivation of Corynebacterium glutamicum
Biotechnol. Bioeng. 123 (6), 1648 - 1660
10.1002/bit.70203
Weather forecast driven irrigation of green roofs improves their thermal and hydrological performance
Sci. Total Environ. 1028 , art. 181690
10.1016/j.scitotenv.2026.181690
When biosurfactants compete with pollutants: Rhamnolipid production and moisture-dependent performance in hydrocarbon-degrading environments
J. Hazard. Mater. 514 , art. 142455
10.1016/j.jhazmat.2026.142455
Integration of human microbiota (SIHUMIx) and zebrafish models reveals microbiome-mediated host responses to azoxystrobin
Toxicol. Sci. 209 (4), kfag022
10.1093/toxsci/kfag022
Dataset for Integration of human microbiota (SIHUMIx) and zebrafish models reveals microbiome-mediated host responses to azoxystrobin (v.2) [Data set]
Zenodo
10.5281/zenodo.18433571
Restoration of deuterium marker for multi-isotope mapping of cellular metabolic activity
Sci. Rep. 16 , art. 883
10.1038/s41598-025-33762-5
A novel approach for calorespirometry: Integrating a CO2 sensor into an isothermal microcalorimeter for simultaneous measurement of microbial heat evolution and mineralization
Soil Biol. Biochem. 214 , art. 110043
10.1016/j.soilbio.2025.110043
Theoretical approach to calculate carbon use efficiency of cellulose turnover in soil systems, exemplified at calorespirometric data from artificial soil under various environmental conditions
Soil Biol. Biochem. 218 , art. 110146
10.1016/j.soilbio.2026.110146
Microbial electro synthesis from CO2 and methanol — methanol-assisted microbial electrosynthesis
Curr. Opin. Chem. Eng. 52 , art. 101244
10.1016/j.coche.2026.101244
Comparative effects of monochromatic red and broad-spectrum white light on biophotovoltaics: Stability, efficiency, and application potential
Bioelectrochemistry 168 , art. 109164
10.1016/j.bioelechem.2025.109164
Effects of plant growth promoting rhizobacteria on acid soil Se bioavailability and Se biofortification in pak choi (Brassica rapa ssp. chinensis)
Plant Soil 520 , 1589 - 1604
10.1007/s11104-026-08342-9
Temperature-driven microbial dynamics and functional shifts in a pilot-scale partial nitrification/anammox reactor treating low-ammonium rare earth tailwater
J. Environ. Chem. Eng. 14 (1), art. 120740
10.1016/j.jece.2025.120740
Stable function, dynamic phylotypes: microdiversity as a reservoir for resilience in dehalococcoides
Environ. Sci. Technol. 60 (4), 3364 - 3373
10.1021/acs.est.5c14525
Functional and structural insights into cyanobacterial CO2 concentrating mechanisms: from compartmentalization to regulation
Plant J. 126 (5), e70974
10.1111/tpj.70974
Rapid allocation of freshly added organic nitrogen to particulate organic matter in ectomycorrhiza- but not arbuscular mycorrhiza-dominated forests
Soil Biol. Biochem. 212 , art. 109999
10.1016/j.soilbio.2025.1099992025 (166)
Microbial biopsy data [Data set]
Zenodo
10.5281/zenodo.14919103
Bacterial colony biopsies: Spatial discrimination of heterogeneous cell types by cytometric fingerprinting
Methods Ecol. Evol. 16 (5), 972 - 987
10.1111/2041-210x.70022
Mesoporous silica nanoparticles for rapid removal of PFOA: Impact of surface functional groups on adsorption efficiency and adsorbent regeneration
Environ. Pollut. 383 , art. 126796
10.1016/j.envpol.2025.126796
Draft genome sequences of Pseudomonas chengduensis strain BW1 and Sphingobium sp. strain MK2 isolated from oil sands process-affected water
Microbiol. Resour. Ann. 14 (2), e00677-24
10.1128/mra.00677-24
Benefits of immobilized bacteria in bioremediation of sites contaminated with toxic organic compounds
Microorganisms 13 (1), art. 155
10.3390/microorganisms13010155
Hydrochar from agricultural waste as a biobased support matrix enhances bacterial degradation of diethyl phthalate
Molecules 30 (5), art. 1167
10.3390/molecules30051167
Hydrochars from agricultural and forestry waste designed to achieve multipurpose matrices: Modeling and optimization of process parameters
Results Eng. 28 , art. 108252
10.1016/j.rineng.2025.108252
Drastic variations in chemical composition of organic inputs: Implications for organic fertilization
Environ. Sci. Technol. 59 (31), 16463 - 16477
10.1021/acs.est.5c06493
Foam formation during anaerobic digestion of sugar beet silage: causes and countermeasures
Bioresour. Technol. 437 , art. 133180
10.1016/j.biortech.2025.133180
Temperature-associated effects on methanogenesis and microbial reductive dechlorination of trichloroethene in contaminated aquifer sediments
Front. Water 7 , art. 1566161
10.3389/frwa.2025.1566161
Sulfidic toluene mineralization by aquifer microbial communities at different temperatures
FEMS Microbiol. Ecol. 101 (8), fiaf079
10.1093/femsec/fiaf079
Rethinking water resources: Harnessing The Gambia River with pressure-driven membrane processes for sustainable supply
Sci. Total Environ. 997 , art. 180158
10.1016/j.scitotenv.2025.180158
Cyanobacterial biofilms: from natural systems to applications
Trends Biotechnol. 43 (2), 318 - 332
10.1016/j.tibtech.2024.08.005
Intermittent flow paths in biofilms grown in a microfluidic channel
Adv. Water Resour. 203 , art. 105018
10.1016/j.advwatres.2025.105018
Data for: Intermittent flow paths in biofilms grown in a microfluidic channel, V1
DaRUS
10.18419/DARUS-4314
Enhancing urban resilience: Stormwater retention and evapotranspiration performance of green roofs under extreme rainfall events
Land 14 (5), art. 977
10.3390/land14050977
Stable isotope reference materials and scale definitions — Outcomes of the 2024 IAEA experts meeting
Rapid Commun. Mass Spectrom. 39 (14), e10018
10.1002/rcm.10018
Deciphering the transfer of antimicrobial resistance genes in the urban water cycle from water source to reuse: a review
Environ. Int. 201 , art. 109584
10.1016/j.envint.2025.109584
Integrating experiments and machine learning modeling to assess the half-wave potentials of antibiotics
ACS ES&T Eng. 5 (12), 3400 - 3412
10.1021/acsestengg.5c00569
Moisture governs diesel biodegradation in sand soil – polystyrene microplastic have a negligible impact
J. Hazard. Mater. 498 , art. 139907
10.1016/j.jhazmat.2025.139907
Decoupling of heat and CO2 release during decomposition of cellulose and its building blocks in soil
Soil Biol. Biochem. 206 , art. 109801
10.1016/j.soilbio.2025.109801
Exploring the influence of building morphology on surface temperatures: A multi-city analysis in Europe
Build. Environ. 282 , art. 113274
10.1016/j.buildenv.2025.113274
Regeneration of the adsorption properties of hydrophobic zeolites for the treatment of diclofenac by Fenton-like process: Influence of Fenton catalyst location
Sep. Purif. Technol. 379, Part 2 , art. 134557
10.1016/j.seppur.2025.134557
Alternate wetting and drying limits arsenic in porewater and rice grain under severe future climate conditions
Environ. Sci. Technol. 59 (42), 22796 - 22806
10.1021/acs.est.5c03552
Investigating the factors influencing antibiotic use practices and their association with antimicrobial resistance awareness among poultry farmers in Enugu State, Nigeria
Antimicrob. Steward. Healthc. Epidemiol. 5 (1), e236
10.1017/ash.2025.10141
Different transcriptional impacts of prophage within the rhizobia-legume symbiosis
Symbiosis 96 , 249 - 260
10.1007/s13199-025-01075-w
Climate change may impair the transition to a fully renewable energy system: A German case study
Energy 338 , art. 138684
10.1016/j.energy.2025.138684
Resolving spatiotemporal dynamics in bacterial multicellular populations: approaches and challenges
Microbiol. Mol. Biol. Rev. 89 (1), e00138-24
10.1128/mmbr.00138-24
Exploring benzene mineralization by anaerobes isolated from denitrifying enrichment cultures
Anaerobe 94 , art. 102979
10.1016/j.anaerobe.2025.102979
Linking extreme light availability to cellular function in algae-dominated communities on the Greenland Ice Sheet
FEMS Microbiol. Ecol. 101 (10), fiaf095
10.1093/femsec/fiaf095
Co-inoculation with Bacillus thuringiensis RZ2MS9 and rhizobia improves the soybean development and modulates soil functional diversity
FEMS Microbiol. Ecol. 101 (2), fiaf013
10.1093/femsec/fiaf013
Catchments amplify reservoir thermal response to climate warming
Water Resour. Res. 61 (1), e2023WR036808
10.1029/2023WR036808
Rhizosphere bacterial community in re-used cover crop root channels initiate responses against drought
PRoteomics IDEntifications Database (PRIDE)
qPCR datasets of the quantification of bacterial communities in the maize-reused cover crop root channels subjected to drought stress in three different soil types found in Germany [Data set]
Zenodo
10.5281/zenodo.14917325
Nitrous oxide is the main product during nitrate reduction by a novel lithoautotrophic iron(II)-oxidizing culture from an organic-rich paddy soil
Appl. Environ. Microb. 91 (1), e01262-24
10.1128/aem.01262-24
Emerging roles of nanoparticles in sustainable agriculture
Plant Nano Biol. 13 , art. 100197
10.1016/j.plana.2025.100197
The zebrafish microbiome has the capacity to bioactivate PFOS precursor compounds
Toxicol. Lett. 411 (Supplement), S176
10.1016/j.toxlet.2025.07.425
Compartment-specific effect of sulfamethoxazole at low μg/L concentrations on microbial nitrogen assimilation in a river system
Water Res. X 28 , art. 100390
10.1016/j.wroa.2025.100390
Hydrocarbons, hydrogen, and organic acids generation by ball milling and batch incubation of sedimentary rocks
Appl. Geochem. 178 , art. 106160
10.1016/j.apgeochem.2024.106160
Tracking assimilation of microbial biomass, leaf litter and artificially created soil organic matter by soil fauna using multi-resource stable isotope labelling
Eur. J. Soil Biol. 126 , art. 103752
10.1016/j.ejsobi.2025.103752
Editorial
Appl. Microbiol. Biotechnol. 109 (1), art. 95
10.1007/s00253-025-13488-0
Disentangling the microbial genomic traits associated with aromatic hydrocarbon degradation in a jet fuel-contaminated aquifer
Biodegradation 36 , art. 7
10.1007/s10532-024-10100-6
Impacts of fertilization on metal(loid) transfer from soil to wheat in a long-term fertilization experiment – using 87Sr/86Sr isotopes as metal(loid) tracer
Environ. Int. 205 , art. 109851
10.1016/j.envint.2025.109851
Data from: Long-term fertilization impacts on metal(loid) transfer from soil to wheat in a 120-year fertilization experiment - using 87Sr/86Sr isotopes as metal(loid) tracer
Duke Research Data Repository
10.7924/r40293w8x
Cyclic lipopeptides as selective anticancer agents: In vitro efficacy on B16F10 mouse melanoma cells
Anti-Cancer Agents Med. Chem. 25 (12), 873 - 882
10.2174/0118715206351208250102114944
timohouben/sm-module: Final Release
Version: v1.0 Zenodo
10.5281/zenodo.14871758
Digital Soil Moisture Mapping - Data accompanying Houben et al. 2025, Vadose Zone Journal [Data set]
Zenodo
10.5281/zenodo.14871615
Machine-learning based spatiotemporal prediction of soil moisture in a grassland hillslope
Vadose Zone J. 24 (2), e70011
10.1002/vzj2.70011
Optimising medium chain carboxylate production in xylan mixed-culture monofermentation
Bioresour. Technol. 420 , art. 132124
10.1016/j.biortech.2025.132124
Deciphering guanidine assimilation and riboswitch-based gene regulation in cyanobacteria for synthetic biology applications
Proc. Natl. Acad. Sci. U.S.A. 122 (49), e2519335122
10.1073/pnas.2519335122
On assessing the energy efficiency of bioelectrochemical systems for cathodic synthesis and remediation
J. Power Sources 652 , art. 237631
10.1016/j.jpowsour.2025.237631
Sources and fate of dissolved sulphate, carbonate, and nitrate in groundwater of the temperate climate zone: a high-resolution multi-isotope (H, C, O, S) study in north-eastern Germany
Isot. Environ. Health Stud. 61 (1), 20 - 41
10.1080/10256016.2025.2461474
Structural insights into the substrate recognition of ginsenoside glycosyltransferase Pq3-O-UGT2
Adv. Sci. 12 (11), art. 2413185
10.1002/advs.202413185
Discovery of comprehensive sets of chemical constituents as markers of PFAS sources through a nontarget screening and machine learning approach
Environ. Sci. Technol. 59 (42), 22852 - 22865
10.1021/acs.est.5c07560
Short read lengths recover ecological patterns in 16S rRNA gene amplicon data
Mol. Ecol. Resour. 25 (6), e14102
10.1111/1755-0998.14102
Regional collaborative data harmonization: Building the next generation of global observations
Soil Ecol. Lett. 7 (4), art. 250354
10.1007/s42832-025-0354-7
Microbial cellulose production using ocean water: sustainable and cost-effective?
Trends Biotechnol. 43 (8), 1823 - 1824
10.1016/j.tibtech.2025.07.009
Gas diffusion electrodes enable enhanced energy efficiency of electrochemical CO2 reduction in natural brine-inspired electrolytes
J. CO2 Util. 102 , art. 103268
10.1016/j.jcou.2025.103268
Supporting data for "Integrating comparative genomics and risk classification by assessing virulence, antimicrobial resistance, and plasmid spread in microbial communities with gSpreadComp"
GigaScience Database
10.5524/102699
Integrating comparative genomics and risk classification by assessing virulence, antimicrobial resistance, and plasmid spread in microbial communities with gSpreadComp
GigaScience 14 , giaf072
10.1093/gigascience/giaf072
A comprehensive view on the fate of 15N isotope-labeled nitrite in model systems for cured and heated sausages
Food Chem. 493, Part 2 , art. 145755
10.1016/j.foodchem.2025.145755
Spatial and temporal patterns of Gammarus sp. in lowland streams analyzed through amino acid isotope analysis
Int. Rev. Hydrobiol. 110 (2), 151 - 165
10.1002/iroh.70024
Integrated effects of microbial culture and nitrogen application on phytoremediation, physiology and growth of maize in glyphosate-contaminated soil
Int. J. Phytoremediat. 27 (7), 991 - 1003
10.1080/15226514.2025.2464625
Carbon-efficient waste upcycling: combining syngas fermentation and chain elongation with synthetic consortia
Curr. Opin. Biotechnol. 94 , art. 103321
10.1016/j.copbio.2025.103321
De novo peptide databases enable protein-based stable isotope probing of microbial communities with up to species-level resolution
Environ. Microbiome 20 , art. 111
10.1186/s40793-025-00767-6
PyExpress - Automating Workflows for 3D Point Cloud Reconstruction of Image Data
Version: 1.0.0 Zenodo
10.5281/zenodo.14245920
Surrogate model for: "Numerical investigation of preferential flow paths in enzymatically induced calcite precipitation supported by Bayesian model analysis"
DaRUS
10.18419/DARUS-4654
Numerical investigation of preferential flow paths in enzymatically induced calcite precipitation supported by Bayesian model analysis
Transp. Porous Media 152 (12), art. 105
10.1007/s11242-025-02240-x
Model for: "Numerical investigation of preferential flow paths in enzymatically induced calcite precipitation supported by Bayesian model analysis"
DaRUS
10.18419/DARUS-4653
Leaf litter material limits the elimination of organic micropollutants in redox-differentiated lab-scale bank filtration columns
Sci. Total Environ. 993 , art. 179979
10.1016/j.scitotenv.2025.179979
A novel geometry-informed drag term formulation for pseudo-3D Stokes simulations with varying apertures
Adv. Water Resour. 195 , art. 104860
10.1016/j.advwatres.2024.104860
Reducing oxygen stress and improving hydrogen availability boosts microbial electrosynthesis by Clostridium ljungdahlii
ChemSusChem 18 (21), e202501118
10.1002/cssc.202501118
Cover Feature: Reducing oxygen stress and improving hydrogen availability boosts microbial electrosynthesis by Clostridium ljungdahlii (ChemSusChem 21/2025)
ChemSusChem 18 (21), e70262
10.1002/cssc.70262
Development of a 13C and 34S isotope analysis method for sulfadimidine and its potential to trace contaminant transformation in groundwater systems
Anal. Chem. 97 (7), 4014 - 4020
10.1021/acs.analchem.4c05625
Pseudogemmobacter sonorensis sp. nov., a new alphaproteobacterium isolated from the slime flux of a tree (Populus fremontii) in the Sonoran Desert (Arizona, USA)
Int. J. Syst. Evol. Microbiol. 75 (7), art. 006859
10.1099/ijsem.0.006859
Metabolic pathways for biotransformation of benzalkonium compounds in fungal- and bacteria-based biofilm reactors
J. Hazard. Mater. 496 , art. 139494
10.1016/j.jhazmat.2025.139494
Removal of antibiotic and disinfectant compounds from digested pig manure by an aerobic hybrid biofilm process
Sci. Total Environ. 982 , art. 179600
10.1016/j.scitotenv.2025.179600
The electricity generation landscape of bioenergy in Germany
Energies 18 (6), art. 1497
10.3390/en18061497
Effects of climate change on wind power generation: A case study for the German Bight
Energies 18 (13), art. 3287
10.3390/en18133287
Effects of defined organic layers on the fluorescence lifetime of plastic materials
Anal. Bioanal. Chem. 417 , 3651 - 3663
10.1007/s00216-025-05888-y
Engineering O2-tolerant chimeric hydrogenases optimized for ferredoxin coupling in Synechocystis sp. PCC 6803
ACS Synth. Biol. 14 (11), 4478 - 4495
10.1021/acssynbio.5c00494
Spatiotemporal dynamics of ammonium monooxygenase (amoA) genes in sediments of the aquaculture area in the Yellow Sea Cold Water Mass
Reg. Stud. Mar. Sci. 89 , art. 104298
10.1016/j.rsma.2025.104298
Anaerobic mineralization of 13C-labeled biomass by thermophilic microorganisms from aquifer sediments
Environ. Technol. Innov. 40 , art. 104547
10.1016/j.eti.2025.104547
Feasibility study of machine learning to explore relationships between antimicrobial resistance and microbial community structure in global wastewater treatment plant sludges
Bioresour. Technol. 417 , art. 131878
10.1016/j.biortech.2024.131878
Exploration of ammonia stripping coupled adsorption-membrane filtration process for treating kitchen waste biogas slurry
Environ. Res. 274 , art. 121318
10.1016/j.envres.2025.121318
Experimental Dataset on the Characterization of a new Photo-Calorespirometry Setup
Mendeley Data
10.17632/56s83cx3mp.1
Experimental dataset on the characterization of a new photo-calorespirometry setup
Data Brief 63 , art. 112157
10.1016/j.dib.2025.112157
Spatial-economic scenarios to increase resilience to urban flooding
Water Res. X 26 , art. 100284
10.1016/j.wroa.2024.100284
Sulfamethoxazole transformation by heat-activated persulfate: Linking transformation products patterns with carbon and nitrogen isotope fractionation
Environ. Sci. Technol. 59 (11), 5704 - 5714
10.1021/acs.est.4c09732
Flow Cytometry data of Synechocystis sp. PCC 6803 features up to 100+ genome copies and high cell cycle dynamics in response to environmental conditions [Data set]
Zenodo
10.5281/zenodo.17241600
A double-staining automated flow cytometry method for real-time monitoring of bacteria in continuous bioreactors
Zenodo
10.5281/zenodo.16418399
Co-expression of auxiliary genes enhances the activity of a heterologous O2-tolerant hydrogenase in the cyanobacterium Synechocystis sp. PCC 6803
Biotechnol. Biofuels Bioprod. 18 , art. 41
10.1186/s13068-025-02634-5
Spatial dynamics of residential heat pump integration and its potential role in the energy transition of German municipalities
Energy 332 , art. 136918
10.1016/j.energy.2025.136918
The landscape of the renewable electricity supply - municipal contributions to Germany’s energy transition
Renew. Energy 240 , art. 122172
10.1016/j.renene.2024.122172
Multi-element isotope fractionation analysis to investigate the photosensitized reactions of humic substance with 3-chloroaniline
Water Res. 282 , art. 123633
10.1016/j.watres.2025.123633
Carbon, hydrogen, nitrogen and chlorine isotope fractionation during 3-chloroaniline transformation in aqueous environments by direct photolysis, TiO2 photocatalysis and hydrolysis
Water Res. 273 , art. 122956
10.1016/j.watres.2024.122956
Tree infiltration trenches in the City of Leipzig – Experiences from four years of operation
Land 14 (7), art. 1315
10.3390/land14071315
Research green roof in Leipzig, Germany
Ecol. Eng. 220 , art. 107729
10.1016/j.ecoleng.2025.107729
Water–energy–food–ecosystem nexus: how to frame and how to govern
Sustain. Sci. 20 (6), 2313 - 2334
10.1007/s11625-025-01691-x
A virus aerosol chamber study: The impact of UVA, UVC, and H2O2 on airborne viral transmission
Environ. Health 3 (6), 648 - 658
10.1021/envhealth.4c00215
Effects of a novel Paraburkholderia phage IPK on the phenanthrene degradation efficiency of the PAH-degrading strain Paraburkholderia caledonica Bk
Biodegradation 36 (5), art. 86
10.1007/s10532-025-10181-x
The future of anaerobic digestion: challenges and opportunities
Bioengineering 12 (5), art. 524
10.3390/bioengineering12050524
Democratising artificial intelligence for pandemic preparedness and global governance in Latin American and Caribbean countries
Microb. Biotechnol. 18 (10), e70256
10.1111/1751-7915.70256
Engineering a photoautotrophic microbial coculture toward enhanced biohydrogen production
Environ. Sci. Technol. 59 (1), 337 - 348
10.1021/acs.est.4c08629
Benefits and challenges of upcoming microbial plant protection applications sustaining planetary health
iScience 28 (10), art. 113557
10.1016/j.isci.2025.113557
Raw_data_qPCR_Protist_diversity [Data set]
Zenodo
10.5281/zenodo.14647026
Long-term organic fertilization shields soil prokaryotes from metal stress while mineral fertilization exacerbates it
Environ. Pollut. 382 , art. 126747
10.1016/j.envpol.2025.126747
Biochar cathodes for bioelectrochemical systems: understanding the effect of material heterogeneity on performance for abiotic hydrogen evolution reaction
ChemElectroChem 12 (20), e202500008
10.1002/celc.202500008
Living with the incoherent: Practical insights on implementing European restoration policies for biodiversity policy integration
Ambio 54 , 1635 - 1647
10.1007/s13280-025-02180-2
Performance of textile-based water-storage mats treating municipal wastewater on urban rooftops for climate resilient cities
Clean Technol. 7 (3), art. 75
10.3390/cleantechnol7030075
Structure of the ATP-driven methyl-coenzyme M reductase activation complex
Nature 642 , 814 - 821
10.1038/s41586-025-08890-7
Identifying the drivers of microbial community changes and interactions in polluted coastal sediments
Environ. Microbiome 20 , art. 117
10.1186/s40793-025-00785-4
Recent advances in adsorptive removal of hazardous VOCs by metal-organic-framework-based materials
Chem. Eng. J. 505 , art. 159257
10.1016/j.cej.2025.159257
Upstream considerations for gas fermentation processes
Curr. Opin. Biotechnol. 95 , art. 103337
10.1016/j.copbio.2025.103337
3D-printed add-on allows using commercially available rotating disc electrodes in tilted position
Electrochem. Commun. 170 , art. 107854
10.1016/j.elecom.2024.107854
Reactivation and long-term stabilization of the [NiFe] Hox hydrogenase of Synechocystis sp. PCC6803 by glutathione after oxygen exposure
J. Biol. Chem. 301 (1), art. 108086
10.1016/j.jbc.2024.108086
Exploring and increased acetate biosynthesis in Synechocystis PCC 6803 through insertion of a heterologous phosphoketolase and overexpressing phosphotransacetylase
Metab. Eng. 88 , 250 - 260
10.1016/j.ymben.2025.01.008
Towards a better understanding of sorption of persistent and mobile contaminants to activated carbon: Applying data analysis techniques with experimental datasets of limited size
Water Res. 274 , art. 123032
10.1016/j.watres.2024.123032
Comment to “Role of MnO2 as an activator of molecular oxygen for singlet oxygen production” published by Zhai et al. in Separation and Purification Technology (2024)
Sep. Purif. Technol. 376, Part 3 , art. 134091
10.1016/j.seppur.2025.134091
Bioavailability and phyto-extractability of metals in a peat-amended agricultural soil under climate stress
J. Environ. Manage. 394 , art. 127167
10.1016/j.jenvman.2025.127167
Inherent differential microbial assemblages and functions associated with corals exhibiting different thermal phenotypes
Sci. Adv. 11 (3), eadq2583
10.1126/sciadv.adq2583
Roles of acyl carrier proteins in ladderane fatty acid producing-organisms
Biochim. Biophys. Acta-Gen. Subj. 1869 (3), art. 130763
10.1016/j.bbagen.2025.130763
Understanding the electron pathway fluidity of Synechocystis in biophotovoltaics
Plant J. 121 (2), e17225
10.1111/tpj.17225
Investigation of acetate uptake kinetics of mature Geobacter sulfurreducens biofilms in continuous bioelectrochemical systems reveals unexpected challenges
Bioelectrochemistry 165 , art. 108978
10.1016/j.bioelechem.2025.108978
Data and code for the manuscript 'Schreiner et al. (2026). Slow and context-dependent: Responses to grassland extensification across a comprehensive set of ecosystem attributes'. Version 5
Biodiversity Exploratories Information System (BExIS)
10.71615/bexis.32032
Thermal enhanced electrokinetic bacterial transport in porous media
Environ. Sci. Technol. 59 (3), 1683 - 1692
10.1021/acs.est.4c07954
Metal-tainted soils: a hidden threat to agriculture and health
Trends Plant Sci. 30 (9), 918 - 920
10.1016/j.tplants.2025.07.004
Going beyond improving soil health: cover plants as contaminant removers in agriculture
Trends Plant Sci. 30 (5), 539 - 552
10.1016/j.tplants.2025.01.009
A novel polydopamine-loaded copper sulfide (CuS@PDA) for activating H2O2 to eliminate tetracycline via 1O2 dominated oxidation pathway
J. Water Process Eng. 71 , art. 107223
10.1016/j.jwpe.2025.107223
Assessing to act: A water-energy-food-ecosystem (WEFE) nexus governance assessment for the Inkomati-Usuthu river basin in South Africa
Environ. Sci. Policy 164 , art. 103986
10.1016/j.envsci.2025.103986
Long-term effects of manure addition on soil organic matter molecular composition: Carbon transformation as a major driver of energetic potential
Soil Biol. Biochem. 205 , art. 109755
10.1016/j.soilbio.2025.109755
Refining the amino reactivity-based identification of respiratory sensitizers
Chem. Res. Toxicol. 38 (6), 1046 - 1060
10.1021/acs.chemrestox.4c00545
Enhanced aerobic bioremediation of an aquifer heavily contaminated with a mixture of chlorobenzenes and hexachlorocyclohexanes at the Sardas landfill (Spain)
J. Hazard. Mater. 484 , art. 136717
10.1016/j.jhazmat.2024.136717
Deciphering the energy use channels in soil organic matter: Impacts of long-term manure addition and necromass revealed by LC-FT-ICR-MS
Soil Biol. Biochem. 208 , art. 109857
10.1016/j.soilbio.2025.109857
Uptake, localization and dissolution of barium sulfate nanoparticles in human lung cells explored by the combination of ICP-MS, TEM and NanoSIMS
J. Trace Elem. Med. Biol. 89 , art. 127650
10.1016/j.jtemb.2025.127650
Response of antibiotic resistance genes expression and mediating role of viral community to antibiotics and heavy metals in anaerobic digestion
Chem. Eng. J. 509 , art. 161396
10.1016/j.cej.2025.161396
Dataset for "Engineering O2-tolerant chimeric hydrogenases optimized for ferredoxin coupling in Synechocystis sp. PCC 6803" [Data set]
Zenodo
10.5281/zenodo.15839120
Towards net zero land biotechnology: an assessment of biogenic feedstock potential for selected bioprocesses in Germany
Biotechnol. Biofuels Bioprod. 18 , art. 69
10.1186/s13068-025-02673-y
Fractionating proteins with nitrite-reducing activity in “Candidatus Kuenenia stuttgartiensis” strain CSTR1
Front. Microbiol. 16 , art. 1483703
10.3389/fmicb.2025.1483703
Evaluation of single chamber electrochemical reduction of CO2 to formate for application under biocompatible conditions
J. CO2 Util. 97 , art. 103136
10.1016/j.jcou.2025.103136
Carbon and energy utilization in microbial cell extracts from soil
Eur. J. Soil Biol. 124 , art. 103713
10.1016/j.ejsobi.2025.103713
The necessity of multi-parameter normalization in cyanobacterial research: A case study of the PsbU in Synechocystis sp. PCC 6803 using CRISPRi
J. Biol. Chem. 301 (11), art. 110763
10.1016/j.jbc.2025.110763
heatmap figure drawing
Zenodo
10.5281/zenodo.14609579
Riverine antibiotic resistome along an anthropogenic gradient
Front. Microbiol. 16 , art. 1516033
10.3389/fmicb.2025.1516033
Ultrafast degradation of Cu(II)-EDTA by peroxymonosulfate activated with polyoxometalate clusters intercalated layered double hydroxides: Simultaneous decomplexation and resourcelization
Colloid Surf. A-Physicochem. Eng. Asp. 707 , art. 135835
10.1016/j.colsurfa.2024.135835
Heterotrophic nitrate reduction potential of an aquifer microbial community from psychrophilic to thermophilic conditions
Sci. Total Environ. 967 , art. 178716
10.1016/j.scitotenv.2025.178716
The TonB-dependent transport system facilitates the uptake of inorganic metal mediators in Pseudomonas putida KT2440 in a bioelectrochemical system
Microb. Biotechnol. 18 (8), e70206
10.1111/1751-7915.70206
Rebuttal to correspondence on "DC electric fields promote biodegradation of waterborne naphthalene in biofilter systems"
Environ. Sci. Technol. 59 (40), 21761 - 21762
10.1021/acs.est.5c12499
Combining microcosm biodegradation and reactive transport modeling to explore the feasibility of ATES-bioremediation approaches
Front. Water 7 , art. 1499448
10.3389/frwa.2025.1499448
Coupling energy balance and carbon flux during cellulose degradation in arable soils
Soil Biol. Biochem. 202 , art. 109691
10.1016/j.soilbio.2024.109691
Carbonyl-induced reduction from Co(III) to Co(II) in CoxSy enables sulfate radical-dominated peroxymonosulfate activation
Environ. Sci.-Nano 12 (10), 4567 - 4578
10.1039/d5en00632e
Virus-host interactions driving the transfer of antibiotic resistance genes in a river-reservoir system under heavy rainfall
J. Hazard. Mater. 494 , art. 138605
10.1016/j.jhazmat.2025.138605
High-throughput screening of microbial reductive dechlorination of polychlorinated biphenyls: Patterns in reactivity and pathways
Environ. Sci. Technol. 59 (15), 7712 - 7721
10.1021/acs.est.4c13917
Identification of key species and molecular mechanisms driving conjugative transfer of antibiotic resistance genes in swine manure-derived bacterial communities
J. Hazard. Mater. 497 , art. 139638
10.1016/j.jhazmat.2025.139638
Neglected role of virus-host interactions driving antibiotic resistance genes reduction in an urban river receiving treated wastewater
Water Res. 282 , art. 123627
10.1016/j.watres.2025.123627
Experimental access to cellulose oxidation and the dynamics of microbial carbon and energy use in artificial soil under varying temperature, water content, and C/N ratio
Soil Biol. Biochem. 203 , art. 109717
10.1016/j.soilbio.2025.109717
Isolation of Dehalococcoides mccartyi strain (NIT-OBY) and identification of a reductive dehalogenase dechlorinating cis-1,3-dichloropropene but not trans-1,3-dichloropropene to non-toxic propene
J. Hazard. Mater. 495 , art. 138996
10.1016/j.jhazmat.2025.138996
Multi-element compound-specific stable isotope analysis (2H, 13C, 15N, 33/34S) to characterize the mechanism of sulfate and hydroxyl radical reaction and photolysis of benzothiazole
Water Res. 279 , art. 123479
10.1016/j.watres.2025.123479
Genome deletions and rewiring of the transcriptome underlying high antimonite resistance in Achromobacter sp. SMAs-55
Int. J. Mol. Sci. 26 (1), art. 107
10.3390/ijms26010107
Molecular dynamics of photosynthetic electron flow in a biophotovoltaic system
Environ. Sci. Ecotechnol. 23 , art. 100519
10.1016/j.ese.2024.100519
The impact of redox mediators on the electrogenic and physiological properties of Synechocystis sp. PCC 6803 in a biophotovoltaic system
ChemSusChem 18 (13), e202402543
10.1002/cssc.202402543
Differential catalytic mechanism induced by selective adsorption of pollutants in metal clusters decorated single atom catalyst mediated heterogeneous Fenton-like reaction
J. Hazard. Mater. 491 , art. 138029
10.1016/j.jhazmat.2025.138029
The chemolithoautotrophic bacterium CB1MN can utilize hydrogen and sulfur as electron donors with ferric iron as electron acceptor
Int. Biodeterior. Biodegrad. 198 , art. 105988
10.1016/j.ibiod.2024.105988
Innovative PN/A process optimization with dual intensification strategies for nitrogen removal from rare earth tailwater
ACS ES&T Wat. 5 (5), 2502 - 2511
10.1021/acsestwater.5c00058
Microbial cooperative molecular strategies enabling 1,2-dichloroethane detoxification in low pH aquifers
Environ. Sci. Technol. 59 (33), 17655 - 17665
10.1021/acs.est.5c03012
Understanding the mechanism of microplastic-associated antibiotic resistance genes in aquatic ecosystems: Insights from metagenomic analyses and machine learning
Water Res. 268, Part A , art. 122570
10.1016/j.watres.2024.1225702024 (175)
Investigating sediment sources using compound-specific stable isotopes and conventional fingerprinting methods in an agricultural loess catchment
Catena 246 , art. 108336
10.1016/j.catena.2024.108336
Genome-centric analyses of 165 metagenomes show that mobile genetic elements are crucial for the transmission of antimicrobial resistance genes to pathogens in activated sludge and wastewater
Microbiol. Spectr. 12 (3), e02918-23
10.1128/spectrum.02918-23
Variovorax sp. strain P1R9 applied individually or as part of bacterial consortia enhances wheat germination under salt stress conditions
Sci. Rep. 14 , art. 2070
10.1038/s41598-024-52535-0
Sequential anaerobic-aerobic treatment enhances sulfamethoxazole removal: From batch cultures to observations in a large-scale wastewater treatment plant
Environ. Sci. Technol. 58 (28), 12609 - 12620
10.1021/acs.est.4c00368
Microbe-assisted rhizodegradation of hydrocarbons and growth enhancement of wheat plants in hydrocarbons contaminated soil
Int. J. Environ. Sci. Technol. 21 (3), 3169 - 3184
10.1007/s13762-023-05174-3
Electrical-energy storage into chemical-energy carriers by combining or integrating electrochemistry and biology
Energy Environ. Sci. 17 (11), 3682 - 3699
10.1039/D3EE01091K
Enhanced wheat productivity in saline soil through the combined application of poultry manure and beneficial microbes
BMC Plant Biol. 24 , art. 423
10.1186/s12870-024-05137-x
Microbial activity, community composition and degraders in the glyphosate-spiked soil are driven by glycine formation
Sci. Total Environ. 907 , art. 168206
10.1016/j.scitotenv.2023.168206
Nitrogen-fertilizer addition to an agricultural soil enhances biogenic non-extractable residue formation from 2-13C,15N-glyphosate
Sci. Total Environ. 918 , art. 170643
10.1016/j.scitotenv.2024.170643
BioDeepfuse: a hybrid deep learning approach with integrated feature extraction techniques for enhanced non-coding RNA classification
RNA Biol. 21 (1), 1 - 12
10.1080/15476286.2024.2329451
Generating colloidal Fe/C composites via hydrothermal carbonization – A critical study
Sep. Purif. Technol. 335 , art. 126082
10.1016/j.seppur.2023.126082
High performance of the metal organic framework CPO-27 for toxic gas capture (NO2)
Eur. J. Inorg. Chem. 27 (29), e202400253
10.1002/ejic.202400253
Strategies found not to be suitable for stabilizing high steroid hydroxylation activities of CYP450 BM3-based whole-cell biocatalysts
PLOS One 19 (9), e0309965
10.1371/journal.pone.0309965
Efficiency aspects of regioselective testosterone hydroxylation with highly active CYP450-based whole-cell biocatalysts
Microb. Biotechnol. 17 (1), e14378
10.1111/1751-7915.14378
Evaluation of the robustness under alkanol stress and adaptability of members of the new genus Halopseudomonas
Microorganisms 12 (11), art. 2116
10.3390/microorganisms12112116
Exploring engineered vesiculation by Pseudomonas putida KT2440 for natural product biosynthesis
Microb. Biotechnol. 17 (1), e14312
10.1111/1751-7915.14312
Adsorption of uranium (VI) complexes with polymer-based spherical activated carbon
Water Res. 249 , art. 120825
10.1016/j.watres.2023.120825
Modeling urban stormwater and irrigation management with coupled blue-green infrastructure in the context of climate change
Blue-Green Syst. 6 (1), 100 - 113
10.2166/bgs.2024.101
Stable isotope probing-nanoFTIR for quantitation of cellular metabolism and observation of growth-dependent spectral features
Small 20 (36), art. 2400289
10.1002/smll.202400289
Microbial electrochemistry and technology capacity building challenges—focus on Latin America & Caribbean and Africa
J. Solid State Electrochem. 28 (3-4), 1023 - 1039
10.1007/s10008-023-05761-x
Integrating viruses into soil food web biogeochemistry
Nat. Microbiol. 9 (8), 1918 - 1928
10.1038/s41564-024-01767-x
Ex-situ electrochemical characterisation of fixed-bed denitrification biocathodes: A promising strategy to improve bioelectrochemical denitrification
Chemosphere 347 , art. 140699
10.1016/j.chemosphere.2023.140699
Pasture-crop rotations modulate the soil and rhizosphere microbiota and preserve soil structure supporting oat cultivation in the Pampa biome
Soil Biol. Biochem. 195 , art. 109451
10.1016/j.soilbio.2024.109451
In situ anchoring of bimetal (Cu, Fe) sulfides featured by sulfur vacancy and phosphorus doping within porous carbon nanocubes derived from Prussian blue analogs to activate peroxymonosulfate for the efficient degradation of organic pollutants
Chem. Eng. J. 498 , art. 155252
10.1016/j.cej.2024.155252
Back flux during anaerobic oxidation of butane supports archaea-mediated alkanogenesis
Nat. Commun. 15 , art. 9628
10.1038/s41467-024-53932-9
Energetics of archaeal anaerobic oxidation of butane
figshare
10.6084/m9.figshare.25499440.v1
Microbial diversity and oil biodegradation potential of northern Barents Sea sediments
J. Environ. Sci. 146 , 283 - 297
10.1016/j.jes.2023.12.010
Waste-to-Energy technologies for municipal solid waste management: Bibliometric review, life cycle assessment, and energy potential case study
J. Clean Prod. 480 , art. 143993
10.1016/j.jclepro.2024.143993
Unbalanced predatory communities and a lack of microbial degraders characterize the microbiota of a highly sewage-polluted Eastern-Mediterranean stream
FEMS Microbiol. Ecol. 100 (6), fiae069
10.1093/femsec/fiae069
Influence of the 3D architecture and surface roughness of SiOC anodes on bioelectrochemical system performance: a comparative study of freeze-cast, 3D-printed, and tape-cast materials with uniform composition
Mater. Renew. Sustain. Energy 13 (1), 81 - 96
10.1007/s40243-023-00253-4
Integrated induction of silver resistance determinants and production of extracellular polymeric substances in Cupriavidus metallidurans BS1 in response to silver ions and silver nanoparticles
Chemosphere 366 , art. 143503
10.1016/j.chemosphere.2024.143503
Microbial electricity-driven anaerobic phenol degradation in bioelectrochemical systems
Environ. Sci. Ecotechnol. 17 , art. 100307
10.1016/j.ese.2023.100307
Proton motive force generation in Dehalococcoides mccartyi strain CBDB1 through intracellular proton uptake during organohalide respiration
FEBS Open Bio 14 (S2), 199 - 200
10.1002/2211-5463.13837
Laccase-mediated degradation of petroleum hydrocarbons in historically contaminated soil
Chemosphere 348 , art. 140733
10.1016/j.chemosphere.2023.140733
Cable bacteria skeletons as catalytically active electrodes
Angew. Chem.-Int. Edit. 63 (6), e202312647
10.1002/anie.202312647
Climate induced microbiome alterations increase cadmium bioavailability in agricultural soils with pH below 7
Commun. Earth Environ. 5 , art. 637
10.1038/s43247-024-01794-w
Biocalorimetry-aided monitoring of fungal pretreatment of lignocellulosic agricultural residues
Appl. Microbiol. Biotechnol. 108 (1), art. 394
10.1007/s00253-024-13234-y
Effect of model methanogens on the electrochemical activity, stability, and microbial community structure of Geobacter spp. dominated biofilm anodes
npj Biofilms Microbiomes 10 , art. 17
10.1038/s41522-024-00490-z
Author correction: Effect of model methanogens on the electrochemical activity, stability, and microbial community structure of Geobacter spp. dominated biofilm anodes
npj Biofilms Microbiomes 10 , art. 41
10.1038/s41522-024-00513-9
Tapping the potential of Dehalococcoides mccartyi's respiratory complex as a 'power plant' to supply production strains with ATP
FEBS Open Bio 14 (S2), 136 - 137
10.1002/2211-5463.13837
Reductive dehalogenase of Dehalococcoides mccartyi strain CBDB1 reduces cobalt-containing metal complexes enabling anodic respiration
Front. Microbiol. 15 , art. 1457014
10.3389/fmicb.2024.1457014
Submarine groundwater discharge into a semi-enclosed coastal bay of the southern Baltic Sea: A multi-method approach
Oceanologia 66 (1), 111 - 138
10.1016/j.oceano.2024.01.001
Sources, compositions, spatio-temporal distributions, and human health risks of bioaerosols: A review
Atmos. Res. 305 , art. 107453
10.1016/j.atmosres.2024.107453
BioPrediction-RPI: Democratizing the prediction of interaction between non-coding RNA and protein with end-to-end machine learning
Comp. Struct. Biotechnol. J. 23 , 2267 - 2276
10.1016/j.csbj.2024.05.031
Leaching of tire particles and simultaneous biodegradation of leachables
Water Res. 253 , art. 121322
10.1016/j.watres.2024.121322
Design, calibration and testing of a novel isothermal calorespirometer prototype
Thermochim. Acta 738 , art. 179785
10.1016/j.tca.2024.179785
GOTM model setup and climate projections for Rappbode Reservoir
Zenodo
10.5281/zenodo.14191748
Linking the transcriptome to physiology: response of the proteome of Cupriavidus metallidurans to changing metal availability
Metallomics 16 (12), mfae058
10.1093/mtomcs/mfae058
Improving waste management strategies in the food sector: case studies from Spain, Tunisia and Hong Kong
J. Mater. Cycles Waste Manag. 26 (4), 2265 - 2277
10.1007/s10163-024-01965-z
A guide for JHM authors focusing on advanced oxidation and reduction processes for environmental applications
J. Hazard. Mater. 476 , art. 135263
10.1016/j.jhazmat.2024.135263
Editorial from the new Editor-in-Chief Matthias Gehre
Isot. Environ. Health Stud. 60 (3), 227 - 228
10.1080/10256016.2024.2357209
P3D-BRNS v1.0.0: a three-dimensional, multiphase, multicomponent, pore-scale reactive transport modelling package for simulating biogeochemical processes in subsurface environments
Geosci. Model Dev. 17 (2), 881 - 898
10.5194/gmd-17-881-2024
Mycelia migratory bacteria in compost and compost–amended rhizosphere soil in a table grape orchard
J. Soil Sci. Plant Nutr. 24 (3), 4666 - 4680
10.1007/s42729-024-01862-2
Granulation compared to co-application of biochar plus mineral fertilizer and its impacts on crop growth and nutrient leaching
Sci. Rep. 14 , art. 16555
10.1038/s41598-024-66992-0
Arsenic immobilization and greenhouse gas emission depend on quantity and frequency of nitrogen fertilization in paddy soil [Data set]
Zenodo
10.5281/zenodo.10679656
Arsenic immobilization and greenhouse gas emission depend on quantity and frequency of nitrogen fertilization in paddy soil
Heliyon 10 (16), e35706
10.1016/j.heliyon.2024.e35706
Editorial overview: Analytical Biotechnology: It's all about getting smaller
Curr. Opin. Biotechnol. 85 , art. 103029
10.1016/j.copbio.2023.103029
Microbial electrosynthesis: opportunities for microbial pure cultures
Trends Biotechnol. 42 (8), 1035 - 1047
10.1016/j.tibtech.2024.02.004
Editorial letter of VSI: European scent of ISMET
Bioelectrochemistry 160 , art. 108772
10.1016/j.bioelechem.2024.108772
DC electric fields promote biodegradation of waterborne naphthalene in biofilter systems
Environ. Sci. Technol. 58 (41), 18234 - 18243
10.1021/acs.est.4c02924
In vitro anticancer studies of a small library of cyclic lipopeptides against the human cervix adenocarcinoma HeLa cells
J. Serb. Chem. Soc. 89 (4), 471 - 484
10.2298/JSC240109018H
Optimization of the ex situ biomethanation of hydrogen and carbon dioxide in a novel meandering plug flow reactor: Start-up phase and flexible operation
Bioengineering 11 (2), art. 165
10.3390/bioengineering11020165
Perspectives of compound-specific isotope analysis of organic contaminants for assessing environmental fate and managing chemical pollution
Nat. Water 2 (1), 14 - 30
10.1038/s44221-023-00176-4
Glycolate as alternative carbon source for Escherichia coli
J. Biotechnol. 381 , 76 - 85
10.1016/j.jbiotec.2024.01.001
Continuous-flow stable sulfur isotope analysis of organic and inorganic compounds by EA-MC-ICPMS
Anal. Chem. 96 (21), 8510 - 8517
10.1021/acs.analchem.4c00439
Assessing the ecological risks and spatial distribution of heavy metal contamination at solid waste dumpsites
Eurasian Soil Sci. 57 (7), 1277 - 1296
10.1134/S1064229324700303
Assessing the electrochemical CO2 reduction reaction performance requires more than reporting coulombic efficiency
Adv. Energy Sustain. Res. 5 (6), art. 2400031
10.1002/aesr.202400031
Non-extractable residues (NER) in persistence assessment: effect on the degradation half-life of chemicals
Environ. Sci. Eur. 36 , art. 206
10.1186/s12302-024-01025-1
Datathons: fostering equitability in data reuse in ecology
Trends Microbiol. 32 (5), 415 - 418
10.1016/j.tim.2024.02.010
Synthesis of recovery patterns in microbial communities across environments
Microbiome 12 , art. 79
10.1186/s40168-024-01802-3
Delivery of small hydrophilic molecules across the stratum corneum: Identification of model systems and parameters to study topical delivery of free amino acids
Int. J. Pharm. 661 , art. 124372
10.1016/j.ijpharm.2024.124372
Assessing energy fluxes and carbon use in soil as controlled by microbial activity - A thermodynamic perspective A perspective paper
Soil Biol. Biochem. 193 , art. 109403
10.1016/j.soilbio.2024.109403
Gibbs energy or enthalpy - What is relevant for microbial C-turnover in soils? A letter to Wang & Kuzyakov, GBC, 2023
Glob. Change Biol. 30 (2), e17183
10.1111/gcb.17183
Rapid consumption of dihydrogen injected into a shallow aquifer by ecophysiologically different microbes
Environ. Sci. Technol. 58 (1), 333 - 341
10.1021/acs.est.3c04340
Characterization of anaerobic biotransformation of hexachlorocyclohexanes by novel microbial consortia enriched from channel and river sediments
J. Hazard. Mater. 476 , art. 135198
10.1016/j.jhazmat.2024.135198
Assessing the effects of microwave heat disturbance on soil microbial communities in Australian agricultural environments: A microcosm study
Appl. Soil Ecol. 198 , art. 105386
10.1016/j.apsoil.2024.105386
Microbial mediated carbon and nitrogen cycling in the spatially heterogenous vadose zone: A modeling study
Vadose Zone J. 23 (2), e20315
10.1002/vzj2.20315
Preliminary planning and optimization approach for wastewater infrastructure for regions with low data availability
Water 16 (5), art. 694
10.3390/w16050694
Revealing taxonomy, activity, and substrate assimilation in mixed bacterial communities by GroEL-proteotyping-based stable isotope probing
iScience 27 (12), art. 111249
10.1016/j.isci.2024.111249
Isolation and characterization of bacteriophages specific to Streptococcus equi subspecies zooepidemicus and evaluation of efficacy ex vivo
Front. Microbiol. 15 , art. 1448958
10.3389/fmicb.2024.1448958
Comment on “Adsorption of uranium (VI) complexes with polymer-based spherical activated carbon”, published by Y.-A. Boussouga et al. [Water Research 249 (2024) 120825]
Water Res. 261 , art. 122031
10.1016/j.watres.2024.122031
Correspondence on "Effects of temperature and DC electric fields on perfluorooctanoic acid sorption kinetics to activated carbon"
Environ. Sci. Technol. 58 (44), 19902 - 19903
10.1021/acs.est.4c07601
Results for pseudo-3D Stokes simulations with a geometry-informed drag term formulation for porous media with varying apertures
DaRUS
10.18419/darus-4347
Code and benchmarks for geometry-informed drag term computation for pseudo-3D Stokes simulations with varying apertures
DaRUS
10.18419/darus-4313
Burning questions: Exploring the limits of microbial electrochemical technology for industrial biotechnological applications
Microb. Biotechnol. 17 (1), e14370
10.1111/1751-7915.14370
Field and laboratory evidence for manganese redox cycling controlling iron and arsenic retention in household sand filters
ACS ES&T Water 4 (1), 33 - 43
10.1021/acsestwater.3c00245
Electricity production landscape of run-of-river power plants in Germany
Resources 13 (12), art. 174
10.3390/resources13120174
In 50 shades of orange: Germany's photovoltaic power generation landscape
Energies 17 (16), art. 3871
10.3390/en17163871
Hydrogen isotope labeling unravels origin of soil-bound organic contaminant residues in biodegradability testing
Nat. Commun. 15 , art. 9178
10.1038/s41467-024-53478-w
Hydrogen isotope labeling unravels origin of soil-bound organic contaminant residues in biodegradability testing [Dataset]
figshare
10.6084/m9.figshare.25954396.v1
Revealing cellular (poly)sulphide storage in electrochemically active sulphide oxidising bacteria using rotating disc electrodes
Bioelectrochemistry 158 , art. 108710
10.1016/j.bioelechem.2024.108710
Dataset accompanying "Revealing cellular (poly)sulphide storage in electrochemically active sulphide oxidising bacteria using rotating disc electrodes"
4TU.ResearchData
10.4121/a2279322-c37c-418e-8776-694f10f31d84.v1
Unraveling the effects of acrylonitrile butadiene styrene (ABS) microplastic ageing on the sorption and toxicity of ionic liquids with 2,4-D and glyphosate herbicides
Chemosphere 364 , art. 143271
10.1016/j.chemosphere.2024.143271
Effect of microplastic on sorption, toxicity, and mineralization of 2,4-dichlorophenoxyacetic acid ionic liquids
Appl. Microbiol. Biotechnol. 108 , art. 523
10.1007/s00253-024-13353-6
Direct phototransformation of sulfamethoxazole characterized by four-dimensional element compound specific isotope analysis
Environ. Sci. Technol. 58 (23), 10322 - 10333
10.1021/acs.est.4c02666
Tracking the transformation of persistent organic pollutants in food webs using multi element isotope and enantiomer fractionation
J. Hazard. Mater. 469 , art. 134046
10.1016/j.jhazmat.2024.134046
Novel stable isotope concepts to track antibiotics in wetland systems
J. Environ. Sci. 146 , 298 - 303
10.1016/j.jes.2024.02.005
A novel sulfatase for acesulfame degradation in wastewater treatment plants as evidenced from Shinella strains
Environ. Sci. Technol. 58 (42), 18892 - 18902
10.1021/acs.est.4c02283
Anaerobic dihydrogen consumption of nutrient-limited aquifer sediment microbial communities examined by stable isotope analysis
Isot. Environ. Health Stud. 60 (2), 103 - 121
10.1080/10256016.2024.2306146
Energy stored in soil organic matter is influenced by litter quality and the degree of transformation – A combustion calorimetry study
Geoderma 443 , art. 116846
10.1016/j.geoderma.2024.116846
Space aquatic chemistry: A roadmap for drinking water treatment in microgravity
Environ. Sci. Ecotechnol. 19 , art. 100344
10.1016/j.ese.2023.100344
Advancements in energy storage: Combining hollow iron cobalt selenide spheres with nickel cobalt layered double hydroxide nanosheets
J. Energy Storage 85 , art. 111079
10.1016/j.est.2024.111079
Source differentiation of BTEX compounds in groundwater contaminated due to refinery activities
J. Environ. Manage. 366 , art. 121893
10.1016/j.jenvman.2024.121893
Nieto GC-FID [Data set]
Zenodo
10.5281/zenodo.12220242
DNA stable isotope probing reveals the impact of trophic interactions on bioaugmentation of soils with different pollution histories
Microbiome 12 , art. 146
10.1186/s40168-024-01865-2
Changes in arsenic mobility and speciation across a 2000-year-old paddy soil chronosequence
Sci. Total Environ. 908 , art. 168351
10.1016/j.scitotenv.2023.168351
MuDoGeR: Multi-Domain Genome recovery from metagenomes made easy
Mol. Ecol. Resour. 24 (2), e13904
10.1111/1755-0998.13904
Simulation of 69 microbial communities indicates sequencing depth and false positives are major drivers of bias in prokaryotic metagenome-assembled genome recovery
PLoS Comput. Biol. 20 (10), e1012530
10.1371/journal.pcbi.1012530
Tuberculosis and HIV/AIDS coinfection in patients attending Directly Observed Treatment Short-course (DOTS) centers in Anambra State, Nigeria: A retrospective study
Health Sci Rep. 7 (6), e2201
10.1002/hsr2.2201
Unravelling a latent pathobiome across coral reef biotopes
Environ. Microbiol. 26 (12), e70008
10.1111/1462-2920.70008
Migrating ripples create streambed heterogeneity altering microbial diversity and metabolic activity
Limnol. Oceanogr. 69 (8), 1882 - 1899
10.1002/lno.12631
Natural attenuation of sulfonamides and metabolites in contaminated groundwater – Review, advantages and challenges of current documentation techniques
Water Res. 254 , art. 121416
10.1016/j.watres.2024.121416
Three-domain microbial communities in the gut of Pachnoda marginata larvae: A comparative study revealing opposing trends in gut compartments
Environ. Microbiol. Rep. 16 (4), e13324
10.1111/1758-2229.13324
Modern-day green strategies for the removal of chromium from wastewater
J. Xenobiotics 14 (4), 670 - 1696
10.3390/jox14040089
Critical evaluation of the performance of rhamnolipids as surfactants for (phyto)extraction of Cd, Cu, Fe, Pb and Zn from copper smelter-affected soil
Sci. Total Environ. 912 , art. 168382
10.1016/j.scitotenv.2023.168382
Disentangling effects of multiple agricultural stressors on benthic and hyporheic nitrate uptake
Biogeochemistry 167 (3), 287 - 299
10.1007/s10533-024-01130-6
Anaerobic glucose uptake in Pseudomonas putida KT2440 in a bioelectrochemical system
Microb. Biotechnol. 17 (1), e14375
10.1111/1751-7915.14375
Beneficial applications of biofilms
Nat. Rev. Microbiol. 22 (5), 276 - 290
10.1038/s41579-023-00985-0
Vitamin B12 as a source of variability in isotope effects for chloroform biotransformation by Dehalobacter
MicrobiologyOpen 13 (4), e1433
10.1002/mbo3.1433
A deep insight into perfluorooctanoic acid photodegradation using metal ion-exchanged zeolites
ACS ES&T Eng. 4 (3), 748 - 757
10.1021/acsestengg.3c00462
Correlative ageing analysis of thermally treated and rejuvenated bitumen and asphalt
Case Stud. Constr. Mater. 21 , e03788
10.1016/j.cscm.2024.e03788
Small decentralized technologies for high-strength wastewater treatment and reuse in arid and semi-arid regions
Environments 11 (7), art. 142
10.3390/environments11070142
Monitoring of hepatitis E virus in wastewater can identify clinically relevant variants
Liver Int. 44 (3), 637 - 643
10.1111/liv.15842
Electron leaks in biophotovoltaics: A multi-disciplinary perspective
ChemCatChem 16 (18), e202400639
10.1002/cctc.202400639
Oxygen in the mix: Is oxic microbial electrosynthesis a potential alternative for biomass production?
ChemElectroChem 11 (20), e202400397
10.1002/celc.202400397
Two-stage conversion of syngas and pyrolysis aqueous condensate into L-malate
Biotechnol. Biofuels Bioprod. 17 , art. 85
10.1186/s13068-024-02532-2
Acetate shock loads enhance CO uptake rates of anaerobic microbiomes
Microb. Biotechnol. 17 (12), e70063
10.1111/1751-7915.70063
Potential deterioration of chemical water quality due to trace metal adsorption onto tire and road wear particles -Environmentally representative experiments
Environ. Pollut. 359 , art. 124571
10.1016/j.envpol.2024.124571
Sustainability, circular economy and bioeconomy: A conceptual review and integration into the notion of sustainable circular bioeconomy
New Medit 23 (2), 3 - 22
10.30682/nm2402a
Electrolysis of medium chain carboxylic acids to aviation fuel at technical scale
Fuel 356 , art. 129590
10.1016/j.fuel.2023.129590
A FAIR comparison of activated carbon, biochar, cyclodextrins, polymers, resins, and metal organic frameworks for the adsorption of per- and polyfluorinated substances
Chem. Eng. J. 498 , art. 155456
10.1016/j.cej.2024.155456
Oxidation of organic pollutants over MnO2 in cold water assisted by peroxydisulfate
Chem. Eng. J. 479 , art. 147170
10.1016/j.cej.2023.147170
Pysewer: A Python library for sewer network generation in data scarce regions
Version: v0.1.20 Zenodo
10.5281/zenodo.14355668
Delineating organizational principles of the endogenous L-A virus by cryo-EM and computational analysis of native cell extracts
Commun. Biol. 7 , art. 557
10.1038/s42003-024-06204-7
The efflux system CdfX exports zinc that cannot be transported by ZntA in Cupriavidus metallidurans
J. Bacteriol. 206 (11), e00299-24
10.1128/jb.00299-24
Effects of temperature and DC electric fields on perfluorooctanoic acid sorption kinetics to activated carbon
Environ. Sci. Technol. 58 (13), 5987 - 5995
10.1021/acs.est.3c10590
Mechanisms of heating-electrokinetic co-driven perfluorooctanoic acid (PFOA) adsorption on zeolite
J. Environ. Sci. 146 , 264 - 271
10.1016/j.jes.2023.10.024
Trends and social aspects in the management and conversion of agricultural residues into valuable resources: A comprehensive approach to counter environmental degradation, food security, and climate change
Bioresour. Technol. 394 , art. 130258
10.1016/j.biortech.2023.130258
Place-based knowledge transfer in a local-to-global and knowledge-to-action context: key steps and facilitative factors
Ecol. Soc. 29 (3), art. 8
10.5751/ES-15024-290308
Unveiling emerging opportunistic fish pathogens in aquaculture: A comprehensive seasonal study of microbial composition in Mediterranean fish hatcheries
Microorganisms 12 (11), art. 2281
10.3390/microorganisms12112281
MecE, MecB, and MecC proteins orchestrate methyl group transfer during dichloromethane fermentation
Appl. Environ. Microb. 90 (10), e00978-24
10.1128/aem.00978-24
Microbiological toxicity tests using standardized ISO/OECD methods-current state and outlook
Appl. Microbiol. Biotechnol. 108 , art. 454
10.1007/s00253-024-13286-0
Identification of the bacterial community that degrades phenanthrene sorbed to polystyrene nanoplastics using DNA-based stable isotope probing
Sci. Rep. 14 , art. 5229
10.1038/s41598-024-55825-9
Draft genome of Bacillus velezensis CMRP6330, a suitable biocontrol agent for disease management in crops
Microbiol. Resour. Ann. 13 (12), e00657-24
10.1128/mra.00657-24
Microbial electrodes
Nat. Rev. Method. Prim. 4 , art. 60
10.1038/s43586-024-00332-4
Enlighting electron routes in oxyfunctionalizing Synechocystis sp. PCC 6803
ChemBioChem 25 (6), e202300475
10.1002/cbic.202300475
Medium-chain carboxylates production from plant waste: kinetic study and effect of an enriched microbiome
Biotechnol. Biofuels Bioprod. 17 , art. 79
10.1186/s13068-024-02528-y
Enriching electroactive microorganisms from ferruginous lake waters – Mind the sulfate reducers!
Bioelectrochemistry 157 , art. 108661
10.1016/j.bioelechem.2024.108661
Dual C and Cl compound-specific isotope analysis and metagenomic insights into the degradation of the pesticide methoxychlor
J. Hazard. Mater. 480 , art. 135929
10.1016/j.jhazmat.2024.135929
Novel extraction methods and compound-specific isotope analysis of methoxychlor in environmental water and aquifer slurry samples
Sci. Total Environ. 931 , art. 172858
10.1016/j.scitotenv.2024.172858
Biological recovery of phosphorus (BioP-Rec) from wastewater streams using brewer’s yeast on pilot-scale
Eng. Life Sci. 24 (2), e2300208
10.1002/elsc.202300208
Editorial: thematic issue on microbial ecotoxicology
FEMS Microbiol. Ecol. 100 (8), fiae097
10.1093/femsec/fiae097
Carbon and energy balance of biotechnological glycolate production from microalgae in a pre-industrial scale flat panel photobioreactor
Biotechnol. Biofuels Bioprod. 17 , art. 42
10.1186/s13068-024-02479-4
Electrogenic sulfur oxidation mediated by cable bacteria and its ecological effects
Environ. Sci. Ecotechnol. 20 , art. 100371
10.1016/j.ese.2023.100371
Comparative in vitro toxicological effects of water-soluble and insoluble components of atmospheric PM2.5 on human lung cells
Toxicol. Vitro 98 , art. 105828
10.1016/j.tiv.2024.105828
Systems biology of electrogenic Pseudomonas putida - multi-omics insights and metabolic engineering for enhanced 2-ketogluconate production
Microb. Cell. Fact. 23 , art. 246
10.1186/s12934-024-02509-8
The impact of liquids and saturated salt solutions on polymer-coated fiber optic sensors for distributed strain and temperature measurement
Sensors 24 (14), art. 4659
10.3390/s24144659
Modular chip-based nanoSFC–MS for ultrafast separations
Anal. Chem. 96 (34), 13888 - 13896
10.1021/acs.analchem.4c01958
Changes of composition and antibiotic resistance of fecal coliform bacteria in municipal wastewater treatment plant
J. Environ. Sci. 146 , 241 - 250
10.1016/j.jes.2023.09.012
Removal of antibiotic resistance genes during swine manure composting is strongly impaired by high levels of doxycycline residues
Waste Manage. 177 , 76 - 85
10.1016/j.wasman.2024.01.037
Community coalescence and plant host filtering determine the spread of tetracycline resistance genes from pig manure into the microbiome continuum of the soil–plant system
Microbiol. Res. 284 , art. 127734
10.1016/j.micres.2024.127734
Priority establishment of soil bacteria in rhizosphere limited the spread of tetracycline resistance genes from pig manure to soil-plant systems based on synthetic communities approach
Environ. Int. 187 , art. 108732
10.1016/j.envint.2024.108732
Weather dynamics affect the long-term thermal and hydrological performance of different green roof designs
Sci. Total Environ. 957 , art. 177376
10.1016/j.scitotenv.2024.177376
In situ grown single-atom cobalt on carbon nanofibers for efficient adsorptive removal of antibiotics: Performance and mechanisms understanding
Chem. Eng. J. 499 , art. 156594
10.1016/j.cej.2024.156594
Stable isotopes and nanoSIMS single-cell imaging reveals soil plastisphere colonizers able to assimilate sulfamethoxazole
Environ. Pollut. 355 , art. 124197
10.1016/j.envpol.2024.124197
Enhancing insights: exploring the information content of calorespirometric ratio in dynamic soil microbial growth processes through calorimetry
Front. Microbiol. 15 , art. 1321059
10.3389/fmicb.2024.1321059
Residual cells and nutrient availability guide wound healing in bacterial biofilms
Soft Matter 20 (5), 1047 - 1060
10.1039/D3SM01032E
Should transformation products change the way we manage chemicals?
Environ. Sci. Technol. 58 (18), 7710 - 7718
10.1021/acs.est.4c00125
Co4(PW9O34)2 polyoxmetalate cluster intercalated in layered double hydroxides as catalyst for the oxidation of p-arsanilic acid and subsequent immobilization of arsenic-containing byproducts
ACS Appl. Nano Mater. 7 (19), 23008 - 23017
10.1021/acsanm.4c04245
MnFe layered double hydroxides confined MnOx for peroxymonosulfate activation: A novel manner for the selective production of singlet oxygen
Environ. Pollut. 348 , art. 123865
10.1016/j.envpol.2024.123865
Viral communities contribute more to the lysis of antibiotic-resistant bacteria than the transduction of antibiotic resistance genes in anaerobic digestion revealed by metagenomics
Environ. Sci. Technol. 58 (5), 2346 - 2359
10.1021/acs.est.3c07664
Anaerobic biotransformation of hexachlorocyclohexane isomers in aqueous condition: dual C-Cl isotope fractionation and impact on microbial community compositions
Water Res. 254 , art. 121389
10.1016/j.watres.2024.121389
Interspecies mobility of organohalide respiration gene clusters enables genetic bioaugmentation
Environ. Sci. Technol. 58 (9), 4214 - 4225
10.1021/acs.est.3c09171
Multi-element (2H, 13C, 37Cl) isotope analysis to characterize reductive transformation of α-, β-, γ-, and δ-HCH isomers by cobalamin and Fe0 nanoparticles
J. Hazard. Mater. 480 , art. 135932
10.1016/j.jhazmat.2024.135932
Time-dependent regulation of soil aggregates on fertilizer N retention and the influence of straw mulching
Soil Biol. Biochem. 198 , art. 109551
10.1016/j.soilbio.2024.1095512023 (154)
Combining flow cytometry and metagenomics improves recovery of metagenome-assembled genomes in a cell culture from activated sludge
Microorganisms 11 (1), art. 175
10.3390/microorganisms11010175
Hypertonic stress induced changes of Pseudomonas fluorescens adhesion towards soil minerals studied by AFM
Sci. Rep. 13 , art. 17146
10.1038/s41598-023-44256-7
Soybean (Glycine max) cropland suitability analysis in subtropical desert climate through GIS-based multicriteria analysis and Sentinel-2 multispectral imaging
Land 12 (11), art. 2034
10.3390/land12112034
Microbe-assisted rhizoremediation of hydrocarbons and growth promotion of chickpea plants in petroleum hydrocarbons-contaminated soil
Sustainability 15 (7), art. 6081
10.3390/su15076081
Marine fungi select and transport aerobic and anaerobic bacterial populations from polycyclic aromatic hydrocarbon-contaminated sediments
mBio 14 (2), e02761-22
10.1128/mbio.02761-22
rcolpo/pgp_reconstruction: First public release
Version: v0.0.4-beta Zenodo
10.5281/zenodo.8205880
Yeast gene KTI13 (alias DPH8) operates in the initiation step of diphthamide synthesis on elongation factor 2
Microb. Cell 10 (9), 195 - 203
10.15698/mic2023.09.804
Fate of glyphosate and its degradation products AMPA, glycine and sarcosine in an agricultural soil: Implications for environmental risk assessment
J. Hazard. Mater. 447 , art. 130847
10.1016/j.jhazmat.2023.130847
Is sorption technology fit for the removal of persistent and mobile organic contaminants from water?
Sci. Total Environ. 880 , art. 163343
10.1016/j.scitotenv.2023.163343
The AnimalAssociatedMetagenomeDB reveals a bias towards livestock and developed countries and blind spots in functional-potential studies of animal-associated microbiomes
Animal Microbiome 5 , art. 48
10.1186/s42523-023-00267-3
Bottom-up synthesis of de-functionalized and dispersible carbon spheres as colloidal adsorbent
Int. J. Mol. Sci. 24 (4), art. 3831
10.3390/ijms24043831
Mixotrophic chain elongation with syngas and lactate as electron donors
Microb. Biotechnol. 16 (2), 322 - 336
10.1111/1751-7915.14163
Formate-induced CO tolerance and methanogenesis inhibition in fermentation of syngas and plant biomass for carboxylate production
Biotechnol. Biofuels Bioprod. 16 , art. 26
10.1186/s13068-023-02271-w
Characterization of phage vB_EcoS-EE09 infecting E. coli DSM613 isolated from wastewater treatment plant effluent and comparativepProteomics of the infected and non-infected host
Microorganisms 11 (11), art. 2688
10.3390/microorganisms11112688
Environmental and anthropogenic factors shape the skin bacterial communities of a semi-arid amphibian species
Microb. Ecol. 86 (2), 1393 - 1404
10.1007/s00248-022-02130-5
Metagenomic analysis of anaerobic microbial communities degrading short-chain fatty acids as sole carbon sources
Microorganisms 11 (2), art. 420
10.3390/microorganisms11020420
Adaptation of the metolachlor-degrading fungus Trichoderma harzianum to the simultaneous presence of low-density polyethylene (LDPE) microplastics
Ecotox. Environ. Safe. 267 , art. 115656
10.1016/j.ecoenv.2023.115656
Recently evolved combination of unique sulfatase and amidase genes enables bacterial degradation of the wastewater micropollutant acesulfame worldwide
Front. Microbiol. 14 , art. 1223838
10.3389/fmicb.2023.1223838
The media composition as a crucial element in high-throughput metabolic network reconstruction
Interface Focus 13 (2), art. 20220070
10.1098/rsfs.2022.0070
Data associated with publication "The media composition as a crucial element in high-throughput metabolic network reconstruction"
Zenodo
10.5281/zenodo.7515886
Microbial electrosynthesis with Clostridium ljungdahlii benefits from hydrogen electron mediation and permits a greater variety of products
Green Chem. 25 (11), 4375 - 4386
10.1039/D3GC00471F
Spatial organization and proteome of a dual-species cyanobacterial biofilm alter among N2-fixing and non-fixing conditions
mSystems 8 (3), art. 00302-23
10.1128/msystems.00302-23
Quantifying energy expenditure in Göttingen Minipigs with the 13C-bicarbonate method under basal and drug-treated conditions
Clin. Nutr. ESPEN 58 , 388 - 396
10.1016/j.clnesp.2023.10.041
A long-term passive sampling approach for wastewater-based monitoring of SARS-CoV-2 in Leipzig, Germany
Sci. Total Environ. 887 , art. 164143
10.1016/j.scitotenv.2023.164143
Meeting report: The first soil viral workshop 2022
Virus Res. 331 , art. 199121
10.1016/j.virusres.2023.199121
Assessment of new and genome-reduced Pseudomonas strains regarding their robustness as chassis in biotechnological applications
Microorganisms 11 (4), art. 837
10.3390/microorganisms11040837
Environmental persistence assessment of heterocyclic polyaromatic hydrocarbons – Ultimate and primary biodegradability using adapted and non-adapted microbial communities
J. Hazard. Mater. 460 , art. 132370
10.1016/j.jhazmat.2023.132370
StandEnA: a customizable workflow for standardized annotation and generating a presence–absence matrix of proteins
Bioinform. Adv. 3 (1), vbad069
10.1093/bioadv/vbad069
Integrated electrosynthesis and biosynthesis for the production of adipic acid from lignin-derived phenols
Green Chem. 25 (12), 4662 - 4666
10.1039/D3GC01105D
Electrochemical cellobiose valorization: Anodic oxidation to cellobionic acid and cathodic reduction to cellobitol
ChemistrySelect 8 (27), e202301823
10.1002/slct.202301823
Does pre-enrichment of anodes with acetate to select for Geobacter spp. enhance performance of microbial fuel cells when switched to more complex substrates?
Front. Microbiol. 14 , art. 1199286
10.3389/fmicb.2023.1199286
Live tracking metabolic networks and physiological responses within microbial assemblages at single-cell level
PNAS Nexus 2 (3), pgad006
10.1093/pnasnexus/pgad006
Improving the performance of bioelectrochemical sulfate removal by applying flow mode
Microb. Biotechnol. 16 (3), 595 - 604
10.1111/1751-7915.14157
Tracking deuterium uptake in hydroponically grown maize roots using correlative helium ion microscopy and Raman micro-spectroscopy
Plant Methods 19 , art. 71
10.1186/s13007-023-01040-y
Draft genome sequence of the plant growth promoter and biocontrol agent Bacillus velezensis strain BIB0110
Microbiol. Resour. Ann. 12 (6), e00231-23
10.1128/mra.00231-23
A unified and simple medium for growing model methanogens
Front. Microbiol. 13 , art. 1046260
10.3389/fmicb.2022.1046260
Combining Geobacter spp. dominated biofilms and anaerobic digestion effluents─The effect of effluent composition and electrode potential on biofilm activity and stability
Environ. Sci. Technol. 57 (6), 2584 - 2594
10.1021/acs.est.2c07574
The heterogeneity–diversity–system performance nexus
Natl. Sci. Rev. 10 (7), nwad109
10.1093/nsr/nwad109
Modernizing persistence–bioaccumulation–toxicity (PBT) assessment with high throughput animal-free methods
Arch. Toxicol. 97 (5), 1267 - 1283
10.1007/s00204-023-03485-5
"OCTOPUS" principle reduces wastewater management costs through network optimization and clustering
One Earth 6 (9), 1227 - 1234
10.1016/j.oneear.2023.08.005
Rapid prototyping of microfluidic chips enabling controlled biotechnology applications in microspace
Curr. Opin. Biotechnol. 81 , art. 102948
10.1016/j.copbio.2023.102948
Cryo-printed microfluidics enable rapid prototyping for optical-cell analysis
Microfluid. Nanofluid. 27 , art. 5
10.1007/s10404-022-02613-4
Fe-zeolites for the adsorption and oxidative degradation of nitroaromatic compounds in water
J. Hazard. Mater. 459 , art. 132125
10.1016/j.jhazmat.2023.132125
Fe-zeolite as on-site regenerable adsorber for chlorohydrocarbons in groundwater – from laboratory to pilot test
Chem. Ing. Tech. 95 (12), 1999 - 2007
10.1002/cite.202300096
Distinct life history strategies underpin clear patterns of succession in microparasite communities infecting a wild mammalian host
Mol. Ecol. 32 (13), 3733 - 3746
10.1111/mec.16949
Effect of alkaline and mechanical pretreatment of wheat straw on methanogenic enrichment cultures from Pachnoda marginata larva gut
Fermentation 9 (1), art. 60
10.3390/fermentation9010060
Superior anodic electro-fermentation by enhancing capacity for extracellular electron transfer
Bioresour. Technol. 389 , art. 129813
10.1016/j.biortech.2023.129813
Labor division of electroactive and carbon degrading microorganisms in bioelectrochemical laminar flow reactors
J. Environ. Chem. Eng. 11 (5), art. 111074
10.1016/j.jece.2023.111074
Diurnal variation in the atmospheric electric field with respect to aerosol and meteorological parameters at Islamabad, Pakistan
J. Earth Syst. Sci. 132 (3), art. 134
10.1007/s12040-023-02151-9
Antibiotic resistance indicator genes in biofilm and planktonic microbial communities after wastewater discharge
Front. Microbiol. 14 , art. 1252870
10.3389/fmicb.2023.1252870
The fate of sulfonamide resistance genes and anthropogenic pollution marker intI1 after discharge of wastewater into a pristine river stream
Front. Microbiol. 14 , art. 1058350
10.3389/fmicb.2023.1058350
Application potential of wastewater fertigated Short Rotation Coppice systems in a selected region (Aligarh, UP, India)
Recycling 8 (5), art. 75
10.3390/recycling8050075
Triple‐element stable isotope analysis of chloromethane emitted by royal fern and degraded by club moss
J. Geophys. Res.-Biogeosci. 128 (5), e2022JG007256
10.1029/2022JG007256
Assessment of meteorological and air quality drivers of elevated ambient ozone in Beijing via machine learning approach
Environ. Sci. Pollut. Res. 30 (47), 104086 - 104099
10.1007/s11356-023-29665-5
A review of particulate pollution over Himalaya region: Characteristics and salient factors contributing ambient PM pollution
Atmos. Environ. 294 , art. 119472
10.1016/j.atmosenv.2022.119472
Dehalococcoides mccartyi strain CBDB1 takes up protons from the cytoplasm to reductively dehalogenate organohalides indicating a new modus of proton motive force generation
Front. Microbiol. 14 , art. 1305108
10.3389/fmicb.2023.1305108
An efficient and scalable method for the production of immunogenic SARS-CoV-2 virus-like particles (VLP) from a mammalian suspension cell line
Vaccines 11 (9), art. 1469
10.3390/vaccines11091469
Design and construction of a new reactor for flexible biomethanation of hydrogen
Fermentation 9 (8), art. 774
10.3390/fermentation9080774
Roadmap for focused ion beam technologies
Appl. Phys. Rev. 10 (4), art. 041311
10.1063/5.0162597
Regenerierung von Trockenmitteln für Wasserstoff durch dielektrische Erwärmung mit Radiowellen. Regeneration of desiccants for hydrogen by dielectric heating with radio waves
Chem. Ing. Tech. 95 (11), 1834 - 1843
10.1002/cite.202300040
Changes of the bacterial composition in duodenal fluid from patients with liver cirrhosis and molecular bacterascites
Sci. Rep. 13 , art. 23001
10.1038/s41598-023-49505-3
On the stability of electrochemical CO2 reduction reaction to formate at indium electrodes at biocompatible conditions
Electrochim. Acta 462 , art. 142733
10.1016/j.electacta.2023.142733
Beyond pathogenesis: Detecting the full spectrum of ecological interactions in the virosphere
PLoS Biol. 21 (5), e3002109
10.1371/journal.pbio.3002109
Liquid chromatorgraphy Fourier transform ion cyclotron resonance mass spectrometry (LC-FT-ICR MS) data of dissolved organic matter (DOM) from soil solution samples of climate and cadmium manipulated soils
Data Investigation Portal UFZ
10.48758/ufz.14199
Identification of huge phages from wastewater metagenomes
Viruses 15 (12), art. 2330
10.3390/v15122330
Continuous operation of fungal wheel reactor based on solid-state fermentation for the removal of pharmaceutical and personal care products
J. Environ. Manage. 331 , art. 117316
10.1016/j.jenvman.2023.117316
High salt electrolyte solutions challenge the electrochemical CO2 reduction reaction to formate at indium and tin cathodes
ChemElectroChem 10 (23), e202300311
10.1002/celc.202300311
Front cover: High salt electrolyte solutions challenge the electrochemical CO2 reduction reaction to formate at indium and tin cathodes (ChemElectroChem 23/2023)
ChemElectroChem 10 (23), e202300656
10.1002/celc.202300656
Cover profile: High salt electrolyte solutions challenge the electrochemical CO2 reduction reaction to formate at indium and tin cathodes
ChemElectroChem 10 (23), e202300655
10.1002/celc.202300655
MAGs, ARGs, and VFs from the gSpreadComp work
Data Investigation Portal UFZ
10.48758/ufz.14212
Evaluating scaling of capillary photo‐biofilm reactors for high cell density cultivation of mixed trophies artificial microbial consortia
Eng. Life Sci. 23 (9), e2300014
10.1002/elsc.202300014
Degradation of emerging pollutants on bifunctional ZnFeV LDH@graphite felt cathode through prominent catalytic activity in heterogeneous electrocatalytic processes
J. Environ. Manage. 342 , art. 118090
10.1016/j.jenvman.2023.118090
Enhanced generation of reactive radicals and electrocatalytic oxidation of levofloxacin using a trimetallic CuFeV layered double hydroxide-containing electrode
Chemosphere 340 , art. 139817
10.1016/j.chemosphere.2023.139817
Mycelial nutrient transfer promotes bacterial co-metabolic organochlorine pesticide degradation in nutrient-deprived environments
ISME J. 17 (4), 570 - 578
10.1038/s41396-023-01371-7
Proteomics data of Escherichia phage vB_EcoS-EE09 isolated from wastewater treatment plant effluent and its infected and non-infected host E. coli DSM613. Project PXD046455 [Data set]
PRoteomics IDEntifications Database (PRIDE)
10.6019/PXD046455
GroEL-proteotyping of bacterial communities using tandem mass spectrometry
Int. J. Mol. Sci. 24 (21), art. 15692
10.3390/ijms242115692
GR2L: A robust dual-layer green roof water balance model to assess multifunctionality aspects under climate variability
Front. Clim. 5 , art. 1115595
10.3389/fclim.2023.1115595
Identification of antibiotic resistance gene hosts in treatment wetlands using a single-cell based high-throughput approach
Water 15 (13), art. 2432
10.3390/w15132432
Green extractants in assisting recovery of REEs: A case study
Molecules 28 (3), art. 965
10.3390/molecules28030965
Comparing theoretical and practical biomass yields calls for revisiting thermodynamic growth models for electroactive microorganisms
Water Res. 242 , art. 120279
10.1016/j.watres.2023.120279
Exploiting synergies between microbial electrochemical technologies and synthetic biology
Microb. Biotechnol. 16 (3), 485 - 488
10.1111/1751-7915.14208
Improved recovery and annotation of genes in metagenomes through the prediction of fungal introns
Mol. Ecol. Resour. 23 (8), 1800 - 1811
10.1111/1755-0998.13852
Ecological forces dictate microbial community assembly processes in bioreactor systems
Curr. Opin. Biotechnol. 81 , art. 102917
10.1016/j.copbio.2023.102917
Understanding and predicting physical clogging at managed aquifer recharge systems: A field-based modeling approach
Adv. Water Resour. 177 , art. 104462
10.1016/j.advwatres.2023.104462
Application of physical clogging models to Managed Aquifer Recharge: a review of modelling approaches from engineering fields
Acque Sotter. 12 (3), 9 - 20
10.7343/as-2023-681
Sorption of ionic liquids in soil enriched with polystyrene microplastic reveals independent behavior of cations and anions
Chemosphere 341 , art. 139927
10.1016/j.chemosphere.2023.139927
Functional redundancy secures resilience of chain elongation communities upon pH shifts in closed bioreactor ecosystems
Environ. Sci. Technol. 57 (46), 18350 - 18361
10.1021/acs.est.2c09573
Uptake and transformation of hexachlorocyclohexane isomers (HCHs) in tree growth rings at a contaminated field site
Environ. Sci. Technol. 57 (23), 8776 - 8784
10.1021/acs.est.3c01929
Determination of stable hydrogen isotopic composition and isotope enrichment factor at low hydrogen concentration
Anal. Chem. 95 (44), 16272 - 16278
10.1021/acs.analchem.3c03214
scMAR-Seq: a novel workflow for targeted single-cell genomics of microorganisms using radioactive labeling
mSystems 8 (6), e00998-23
10.1128/msystems.00998-23
The microbiology of Power-to-X applications
FEMS Microbiol. Rev. 47 (2), fuad013
10.1093/femsre/fuad013
Development of an automated online flow cytometry method to quantify cell density and fingerprint bacterial communities
Cells 12 (12), art. 1559
10.3390/cells12121559
Women in microbial physiology and metabolism: 2022. Editorial
Front. Microbiol. 14 , art. 1268568
10.3389/fmicb.2023.1268568
Interlaboratory reproducibility in growth and reporter expression in the cyanobacterium Synechocystis sp. PCC 6803
ACS Synth. Biol. 12 (6), 1823 - 1835
10.1021/acssynbio.3c00150
Metagenome-assembled genomes indicate that antimicrobial resistance genes are highly prevalent among urban bacteria and multidrug and glycopeptide resistances are ubiquitous in most taxa
Front. Microbiol. 14 , art. 1037845
10.3389/fmicb.2023.1037845
Recent developments in microplastic contaminated water treatment: Progress and prospects of carbon-based two-dimensional materials for membranes separation
Chemosphere 316 , art. 137704
10.1016/j.chemosphere.2022.137704
Neglected atmospheric microplastic pollution in South Asia reflects a wider failure
Ecol. Inform. 73 , art. 101949
10.1016/j.ecoinf.2022.101949
Chemical composition of monsoon bulk precipitation in the Salalah area, Oman
Chem. Geol. 635 , art. 121621
10.1016/j.chemgeo.2023.121621
Humic substance photosensitized degradation of phthalate characterized by 2H and 13C isotope fractionation
Environ. Sci. Technol. 57 (5), 1930 - 1939
10.1021/acs.est.2c06783
Carbon isotope fractionation of di-(2-ethylhexyl)-phthalate during photosensitized degradation by •OH and SO4·- for characterization of reaction mechanisms
Chem. Eng. J. 475 , art. 145950
10.1016/j.cej.2023.145950
Carbon and hydrogen isotope fractionation of phthalates during photocatalysis reactions in aqueous solution containing Fe(III) complexes or iron minerals
Water Res. 247 , art. 120740
10.1016/j.watres.2023.120740
Responses of canopy hydrometorological parameters to oak dieback in the Mediterranean sparse forest, Iran
Agric. For. Meteorol. 343 , art. 109784
10.1016/j.agrformet.2023.109784
Membrane-processed honey samples for pollen characterization with health benefits
Chemosphere 319 , art. 137994
10.1016/j.chemosphere.2023.137994
Improvement of treatment performance of the conventional wastewater treatment plant: A case study of the Central Wastewater Treatment Plant in Ulaanbaatar, Mongolia
Sustainability 15 (5), art. 4528
10.3390/su15054528
Towards a synthetic hydrogen sensor in cyanobacteria: Functional production of an oxygen-tolerant regulatory hydrogenase in Synechocystis sp. PCC 6803
Front. Microbiol. 14 , art. 1122078
10.3389/fmicb.2023.1122078
Carbon and hydrogen stable isotope fractionation of sulfamethoxazole during anaerobic transformation catalyzed by Desulfovibrio vulgaris Hildenborough
Chemosphere 311, Part 2 , art. 136923
10.1016/j.chemosphere.2022.136923
A coculture of photoautotrophs and hydrolytic heterotrophs enables efficient upcycling of starch from wastewater toward biomass-derived products: Synergistic interactions impacting metabolism of the consortium
Environ. Sci. Technol. 57 (41), 15523 - 15532
10.1021/acs.est.3c05321
Basic principles for biosurfactant-assisted (bio)remediation of soils contaminated by heavy metals and petroleum hydrocarbons – A critical evaluation of the performance of rhamnolipids
J. Hazard. Mater. 443, Part A , art. 130171
10.1016/j.jhazmat.2022.130171
Can ionic liquids exist in the soil environment? Effect of quaternary ammonium cations on glyphosate sorption, mobility and toxicity in the selected herbicidal ionic liquids
J. Mol. Liq. 370 , art. 120981
10.1016/j.molliq.2022.120981
A multi-functional nature-based solution (NBS) for greywater treatment and reuse at the same plot
Ecol. Eng. 191 , art. 106952
10.1016/j.ecoleng.2023.106952
Effect of hydraulic loading rate on treatment performance of a pilot wetland roof treating greywater from a household
Water 15 (9), art. 3375
10.3390/w15193375
Effects of zinc-enriched amino acids on rice plants (Oryza sativa L.) for adaptation in saline-sodic soil conditions: Growth, nutrient uptake and biofortification of zinc
S. Afr. J. Bot. 162 , 370 - 380
10.1016/j.sajb.2023.09.011
Continuous cultivation of Dehalococcoides mccartyi with brominated tyrosine avoids toxic byproducts and gives tight reactor control
Water Res. 229 , art. 119396
10.1016/j.watres.2022.119396
COVID-19 alters human microbiomes: a meta-analysis
Front. Cell. Infect. Microbiol. 13 , art. 1211348
10.3389/fcimb.2023.1211348
Universal drivers of cheese microbiomes
iScience 26 (1), art. 105744
10.1016/j.isci.2022.105744
Cost-effective selective hydrogen sensor based on the combination of catalytic spillover effect and impedance measurement
Int. J. Hydrog. Energy 48 (96), 37550 - 37562
10.1016/j.ijhydene.2022.12.302
Exploring the potential molecular mechanisms of interactions between a probiotic consortium and its coral host
mSystems 8 (1), e00921-22
10.1128/msystems.00921-22
Electrosorption of organic compounds: State of the art, challenges, performance, and perspectives
Chem. Eng. J. 471 , art. 144354
10.1016/j.cej.2023.144354
Recovery of 197 eukaryotic bins reveals major challenges for eukaryote genome reconstruction from terrestrial metagenomes
Mol. Ecol. Resour. 23 (5), 1066 - 1076
10.1111/1755-0998.13776
Microbial single-cell mass spectrometry: status, challenges, and prospects
Curr. Opin. Biotechnol. 83 , art. 102977
10.1016/j.copbio.2023.102977
Interference of electron transfer chain inhibitors in bioelectrochemical systems
Electrochem. Commun. 152 , art. 107527
10.1016/j.elecom.2023.107527
Sulfate reduction and homoacetogenesis at various hypersaline conditions: Implications for H2 underground gas storage
Front. Energy Res. 11 , art. 1125619
10.3389/fenrg.2023.1125619
Production of (hydroxy)benzoate-derived polyketides by engineered Pseudomonas with in situ extraction
Bioresour. Technol. 388 , art. 129741
10.1016/j.biortech.2023.129741
Bridging the gap in African biodiversity genomics and bioinformatics
Nat. Biotechnol. 41 (9), 1348 - 1354
10.1038/s41587-023-01933-2
Natural product biosynthetic potential reflects macroevolutionary diversification within a widely distributed bacterial taxon
mSystems 8 (6), e00643-23
10.1128/msystems.00643-23
Cost-effective method for estimation of tree crown density in urban settings using a smartphone
Blue-Green Syst. 5 (2), 121 - 134
10.2166/bgs.2023.029
Assessing the growth kinetics and stoichiometry of Escherichia coli at the single-cell level
Eng. Life Sci. 23 (1), e2100157
10.1002/elsc.202100157
Respiratory protein interactions in Dehalobacter sp. strain 8M revealed through genomic and native proteomic analyses
Environ. Microbiol. 25 (11), 2604 - 2620
10.1111/1462-2920.16464
Application of gas diffusion electrodes in bioeconomy: An update
Biotechnol. Bioeng. 120 (6), 1465 - 1477
10.1002/bit.28383
Holistic exploitation of pulsed electric field (PEF)-treated and lipid extracted microalgae Auxenochlorella protothecoides, utilizing anaerobic digestion (AD)
Algal Res. 69 , art. 102950
10.1016/j.algal.2022.102950
Toward the future of OECD/ISO biodegradability testing-new approaches and developments
Appl. Microbiol. Biotechnol. 107 (7-8), 2073 - 2095
10.1007/s00253-023-12406-6
Using a microbial fuel cell to balance the carbon‑nitrogen mismatch in submerged fixed-bed reactors for the resilient treatment of mariculture wastewater
J. Water Process Eng. 53 , art. 103629
10.1016/j.jwpe.2023.103629
Photosynthesis driven continuous hydrogen production by diazotrophic cyanobacteria in high cell density capillary photobiofilm reactors
Bioresour. Technol. 373 , art. 128703
10.1016/j.biortech.2023.128703
Cyanobacteria as whole-cell factories: current status and future prospectives
Curr. Opin. Biotechnol. 80 , art. 102892
10.1016/j.copbio.2023.102892
Light‐driven redox biocatalysis on gram‐scale in Synechocystis sp. PCC 6803 via an in vivo cascade
Plant Biotechnol. J. 21 (10), 2074 - 2083
10.1111/pbi.14113
Effect of biochar and compost addition on mitigating salinity stress and improving fruit quality of tomato
Agronomy-Basel 13 (9), art. 2197
10.3390/agronomy13092197
Effects of reducing, stabilizing, and antibiotic agents on “Candidatus Kuenenia stuttgartiensis”
Appl. Microbiol. Biotechnol. 107 (5-6), 1829 - 1843
10.1007/s00253-023-12375-w
Development of embodied capital: diet composition, foraging skills, and botanical knowledge of forager children in the Congo Basin
Front. Ecol. Evol. 11 , art. 935987
10.3389/fevo.2023.935987
Carbon and hydrogen stable isotope fractionation due to monooxygenation of short-chain alkanes by butane monooxygenase of Thauera butanivorans Bu-B1211
Front. Microbiol. 14 , art. 1250308
10.3389/fmicb.2023.1250308
Structure-function and engineering of plant UDP-glycosyltransferase
Comp. Struct. Biotechnol. J. 21 , 5358 - 5371
10.1016/j.csbj.2023.10.046
Proteogenomics of the novel Dehalobacterium formicoaceticum strain EZ94 highlights a key role of methyltransferases during anaerobic dichloromethane degradation
Environ. Sci. Pollut. Res. 30 (33), 80602 - 80612
10.1007/s11356-023-28144-1
Fate of horizontal-gene-transfer markers and beta-lactamase genes during thermophilic composting of human excreta
Microorganisms 11 (2), art. 308
10.3390/microorganisms11020308
Glyphosate versus glyphosate based ionic liquids: Effect of cation on glyphosate biodegradation, soxA and phnJ genes abundance and microbial populations changes during soil bioaugmentation
Chemosphere 316 , art. 137717
10.1016/j.chemosphere.2022.137717
2,4-D versus 2,4-D based ionic liquids: Effect of cation on herbicide biodegradation, tfdA genes abundance and microbiome changes during soil bioaugmentation
J. Hazard. Mater. 452 , art. 131209
10.1016/j.jhazmat.2023.131209
Temperature and soil moisture change microbial allocation of pesticide-derived carbon
Eur. J. Soil Sci. 74 (5), e13417
10.1111/ejss.13417
Multi-country metabolic signature discovery for chicken health classification
Metabolomics 19 (2), art. 9
10.1007/s11306-023-01973-4
New insights into the mechanism for 1O2-Dominated peroxymonosulfate activation in saline solution: In-situ generation of H2O2 to inhibit the AOX formation
Chem. Eng. J. 474 , art. 145698
10.1016/j.cej.2023.145698
Improve niche colonization and microbial interactions for organohalide-respiring-bacteria-mediated remediation of chloroethene-contaminated sites
Environ. Sci. Technol. 57 (45), 17338 - 17352
10.1021/acs.est.3c05932
Response of prokaryotic, eukaryotic and algal communities to heavy rainfall in a reservoir supplied with reclaimed water
J. Environ. Manage. 334 , art. 117394
10.1016/j.jenvman.2023.117394
Enhancing Insights: Exploring the Information Content of Calorespirometric Measurements in Dynamic Soil Processes (Version 1.0)
Data Investigation Portal UFZ
10.48758/UFZ.14030
Water safety consideration of the dual nature of virus in global urban water cycle: from source to reuse
ACS ES&T Water 3 (8), 1980 - 1983
10.1021/acsestwater.3c00222
Mechanistic insight into the Dehalococcoides-mediated reductive dechlorination of polychlorinated biphenyls
Phys. Chem. Chem. Phys. 25 (22), 15193 - 15199
10.1039/d3cp01055d
Insight into the mechanism underlying Dehalococcoides mccartyi strain CBDB1-mediated B12-dependent aromatic reductive dehalogenation
Environ. Sci. Technol. 57 (29), 10773 - 10781
10.1021/acs.est.3c00364
Turnover of bacterial biomass to soil organic matter via fungal biomass and its metabolic implications
Soil Biol. Biochem. 180 , art. 108995
10.1016/j.soilbio.2023.1089952022 (160)
The oxygen dilemma: The challenge of the anode reaction for microbial electrosynthesis from CO2
Front. Microbiol. 13 , art. 947550
10.3389/fmicb.2022.947550
Thiourea leaching of gold from processed municipal solid waste incineration residues
J. Mater. Cycles Waste Manag. 24 (6), 2243 - 2254
10.1007/s10163-022-01476-9
Efficient carbon and nitrogen transfer from marine diatom aggregates to colonizing bacterial groups
Sci. Rep. 12 , art. 14949
10.1038/s41598-022-18915-0
Changes in composition and diversity of epiphytic microorganisms on field pea seeds, partial crop peas, and whole crop peas during maturation and ensiling with or without lactic acid bacteria inoculant
Microbiol. Spectr. 10 (4), e00953-22
10.1128/spectrum.00953-22
Uniform and dispersible carbonaceous microspheres as quasi-liquid sorbent
Chemosphere 307, Part 4 , art. 136079
10.1016/j.chemosphere.2022.136079
Recirculation of H2, CO2, and ethylene improves carbon fixation and carboxylate yields in anaerobic fermentation
ACS Sustain. Chem. Eng. 10 (13), 4073 - 4081
10.1021/acssuschemeng.1c05133
Genome mining reveals high biosynthetic potential of biocontrol agent Bacillus velezensis B.BV10
Genes 13 (11), art. 1984
10.3390/genes13111984
Effect of temperature on microbial reductive dehalogenation of chlorinated ethenes: a review
FEMS Microbiol. Ecol. 98 (9), fiac081
10.1093/femsec/fiac081
Sulfidic acetate mineralization at 45°C by an aquifer microbial community: key players and effects of heat changes on activity and community structure
Environ. Microbiol. 24 (1), 370 - 389
10.1111/1462-2920.15852
Fluorescence lifetime activated droplet sorting (FLADS) for label-free sorting of Synechocystis sp. PCC6803
Lab Chip 22 (8), 1604 - 1614
10.1039/d2lc00032f
Exploiting unconventional prokaryotic hosts for industrial biotechnology
Trends Biotechnol. 40 (4), 385 - 397
10.1016/j.tibtech.2021.08.003
The sRNA NsiR4 fine-tunes arginine synthesis in the cyanobacterium Synechocystis sp. PCC 6803 by post-transcriptional regulation of PirA
RNA Biol. 19 (1), 811 - 818
10.1080/15476286.2022.2082147
The transcriptional regulator RbcR controls ribulose-1,5-bisphosphate carboxylase/oxygenase (RuBisCO) genes in the cyanobacterium Synechocystis sp. PCC 6803
New Phytol. 235 (2), 432 - 445
10.1111/nph.18139
Information theory for biological sequence classification: A novel feature extraction technique based on Tsallis entropy
Entropy 24 (10), art. 1398
10.3390/e24101398
BioAutoML: automated feature engineering and metalearning to predict noncoding RNAs in bacteria
Brief. Bioinform. 23 (4), bbac218
10.1093/bib/bbac218
Whole-genome sequence of the filamentous diazotrophic cyanobacterium Tolypothrix sp. PCC 7712 and its comparison with non-diazotrophic Tolypothrix sp. PCC 7601
Front. Microbiol. 13 , art. 1042437
10.3389/fmicb.2022.1042437
Evaluation of self-sustaining cyanobacterial biofilms for technical applications
Biofilm 4 , art. 100073
10.1016/j.bioflm.2022.100073
Rational orthologous pathway and biochemical process engineering for adipic acid production using Pseudomonas taiwanensis VLB120
Metab. Eng. 70 , 206 - 217
10.1016/j.ymben.2022.01.014
Integrated wastewater management for the protection of vulnerable water resources in the north of Jordan
Sustainability 14 (6), art. 3574
10.3390/su14063574
Automatic, fast, hierarchical, and non-overlapping gating of flow cytometric data with flowEMMi v2
Comp. Struct. Biotechnol. J. 20 , 6473 - 6489
10.1016/j.csbj.2022.11.033
From modular decomposition trees to rooted median graphs
Discrete Appl. Math. 310 , 1 - 9
10.1016/j.dam.2021.12.017
Expanding the calibration range of compound-specific chlorine isotope analysis by the preparation of a 37Cl-enriched tetrachloroethylene
Rapid Commun. Mass Spectrom. 36 (21), e9378
10.1002/rcm.9378
Green citric acid in the sorption process of rare earth elements
Chem. Eng. J. 437, Part 2 , art. 135366
10.1016/j.cej.2022.135366
Succession in the caecal microbiota of developing broilers colonised by extended-spectrum β-lactamase-producing Escherichia coli
Animal Microbiome 4 , art. 51
10.1186/s42523-022-00199-4
New paradigms for familiar diseases: Lessons learned on circulatory bacterial signatures in cardiometabolic diseases
Exp. Clin. Endocrinol. Diabet. 130 (5), 313 - 326
10.1055/a-1756-4509
Gaseous NO2 induces various envelope alterations in Pseudomonas fluorescens MFAF76a
Sci. Rep. 12 , art. 8528
10.1038/s41598-022-11606-w
Genome and proteome analyses show the gaseous alkane degrader Desulfosarcina sp. strain
Environ. Microbiol. 24 (4), 1964 - 1976
10.1111/1462-2920.15956
Deciphering the fate of sulfate in one- and two-chamber bioelectrochemical systems
Electrochim. Acta 408 , art. 139942
10.1016/j.electacta.2022.139942
A method proposal for throughfall measurement in grassland at plot scale in temperate climate: ‘Interception tubes’
Front. Earth Sci. 10 , art. 799419
10.3389/feart.2022.799419
Metallomics of the quinone-free respiration system of Dehalococcoides mccartyi indicates the presence of molybdenum, nickel, iron and cobalt in the respiratory complex
Biochim. Biophys. Acta-Bioenerg. 1863 (Suppl.), art. 148768
10.1016/j.bbabio.2022.148768
Applicability and information value of biocalorimetry for the monitoring of fungal solid-state fermentation of lignocellulosic agricultural by-products
New Biotech. 66 , 97 - 106
10.1016/j.nbt.2021.11.001
Fungal lignocellulose utilization strategies from a bioenergetic perspective: Quantification of related functional traits using biocalorimetry
Microorganisms 10 (8), art. 1675
10.3390/microorganisms10081675
Structure and functional capacity of a benzene‐mineralizing, nitrate‐reducing microbial community
J. Appl. Microbiol. 132 (4), 2795 - 2811
10.1111/jam.15443
Redox mediators in microbial electrochemical systems
ChemElectroChem 9 (13), e202200216
10.1002/celc.202200216
Pore-scale heterogeneities improve the degradation of a self-inhibiting substrate: Insights from reactive transport modeling
Environ. Sci. Technol. 56 (18), 13008 - 13018
10.1021/acs.est.2c01433
amirgolp/P3D-BRNS: v0.1.0-beta
Zenodo
10.5281/zenodo.6301317
Enrichment of anaerobic microbial communities from midgut and hindgut of sun beetle larvae (Pachnoda marginata) on wheat straw: effect of inoculum preparation
Microorganisms 10 (4), art. 761
10.3390/microorganisms10040761
Heterologous lactate synthesis in Synechocystis sp. strain PCC 6803 causes a growth condition-dependent carbon sink effect
Appl. Environ. Microb. 88 (8), e00063-22
10.1128/aem.00063-22
Absolute_GeneCopyNumbers_qPCR [Dataset]
figshare
10.6084/m9.figshare.20310003.v1
The role of microbes in the increase of organic phosphorus availability in the rhizosheath of cover crops
Plant Soil 476 (1-2), 353 - 373
10.1007/s11104-022-05340-5
Lockdown amid COVID-19 ascendancy over ambient particulate matter pollution anomaly
Int. J. Environ. Res. Public Health 19 (20), art. 13540
10.3390/ijerph192013540
The role of abiotic variables in an emerging global amphibian fungal disease in mountains
Sci. Total Environ. 815 , art. 152735
10.1016/j.scitotenv.2021.152735
Editorial: Current and future trends in adsorption for environmental separations
J. Hazard. Mater. 433 , art. 128776
10.1016/j.jhazmat.2022.128776
Key factors controlling microbial distribution on a DNAPL source area
Environ. Sci. Pollut. Res. 29 (1), 1508 - 1520
10.1007/s11356-021-15635-2
Power-to-methane – Design and optimization of two new bubble column reactors
Chem. Ing. Tech. 94 (9), 1323 - 1323
10.1002/cite.202255250
Integrated genomic surveillance enables tracing of person-to-person SARS-CoV-2 transmission chains during community transmission and reveals extensive onward transmission of travel-imported infections, Germany, June to July 2021
Eurosurveillance 27 (43), art. 2101089
10.2807/1560-7917.ES.2022.27.43.2101089
Valorisation of microalgae residues after lipid extraction: Pyrolysis characteristics for biofuel production
Biochem. Eng. J. 179 , art. 108330
10.1016/j.bej.2021.108330
Soil conditioners improve rhizodegradation of aged petroleum hydrocarbons and enhance the growth of Lolium multiflorum
Environ. Sci. Pollut. Res. 29 (6), 9097 - 9109
10.1007/s11356-021-16149-7
Morpho-physiological response of barley to assess genotypic differences of salinity tolerance under hyper arid climate
Agric. Water Manage. 272 , art. 107832
10.1016/j.agwat.2022.107832
An annotated inventory of Tanzanian medicinal plants traditionally used for the treatment of respiratory bacterial infections
Plants 11 (7), art. 931
10.3390/plants11070931
Microbial | electrochemical CO2 reduction: To integrate or not to integrate?
Joule 6 (5), 935 - 940
10.1016/j.joule.2022.04.005
What is the role of individual species within bidirectional electroactive microbial biofilms: A case study on Desulfarculus baarsii and Desulfurivibrio alkaliphilus
ChemElectroChem 9 (2), e202101116
10.1002/celc.202101116
From gut to mud: dissemination of antimicrobial resistance between animal and agricultural niches
Environ. Microbiol. 24 (8), 3290 - 3306
10.1111/1462-2920.15927
Eggerthella lenta DSM 2243 alleviates bile acid stress response in Clostridium ramosum and Anaerostipes caccae by transformation of bile acids
Microorganisms 10 (10), art. 2025
10.3390/microorganisms10102025
Microcosm test for pesticide fate assessment in planted water filters: 13C,15N-labeled glyphosate as an example
Water Res. 226 , art. 119211
10.1016/j.watres.2022.119211
Effects of sewage sludge hydrochar on emissions of the climate-relevant trace gases N2O and CO2 from loamy sand soil
Heliyon 8 (10), e10855
10.1016/j.heliyon.2022.e10855
The community ecology perspective of omics data
Microbiome 10 , art. 225
10.1186/s40168-022-01423-8
Potential of microbiome-based solutions for agrifood systems
Nat. Food 3 (8), 557 - 560
10.1038/s43016-022-00576-x
MarineMetagenomeDB: a public repository for curated and standardized metadata for marine metagenomes
Environ. Microbiome 17 , art. 57
10.1186/s40793-022-00449-7
Development and validation of a simple, selective, and accurate reversed-phase liquid chromatographic method with diode array detection (RP-HPLC/DAD) for the simultaneous analysis of 18 free amino acids in topical formulations
Chromatographia 85 (7), 665 - 676
10.1007/s10337-022-04160-0
Lagrangian profiles of riverine autotrophy, organic matter transformation, and micropollutants at extreme drought
Sci. Total Environ. 828 , art. 154243
10.1016/j.scitotenv.2022.154243
Extracellular vesicles of mesenchymal stromal cells can be taken up by microglial cells and partially prevent the stimulation induced by β-amyloid
Stem Cell Rev. Rep. 18 (3), 1113 - 1126
10.1007/s12015-021-10261-4
Water stress-driven changes in bacterial cell surface properties
Appl. Environ. Microb. 88 (21), e00732-22
10.1128/aem.00732-22
Metagenomics-resolved genomics provides novel insights into chitin turnover, metabolic specialization, and niche partitioning in the octocoral microbiome
Microbiome 10 , art. 151
10.1186/s40168-022-01343-7
Phase-specific stable isotope fractionation effects during combined gas-liquid phase exchange and biodegradation
Environ. Pollut. 309 , art. 119737
10.1016/j.envpol.2022.119737
Draft genome sequences of two Sphingobium species associated with hexachlorocyclohexane (HCH) degradation isolated from an HCH-contaminated soil
Microbiol. Resour. Ann. 11 (3), e00886-21
10.1128/mra.00886-21
Should we worry about surficial dynamics when assessing nutrient cycling in the groundwater?
Front. Water 4 , art. 780297
10.3389/frwa.2022.780297
Predicting the impact of spatial heterogeneity on microbially mediated nutrient cycling in the subsurface
Biogeosciences 19 (3), 665 - 688
10.5194/bg-19-665-2022
Editorial: Thematic issue on anaerobic biological dehalogenation
FEMS Microbiol. Ecol. 98 (11), fiac108
10.1093/femsec/fiac108
Cellular stress affects the fate of microbial resistance to folate inhibitors in treatment wetlands
Sci. Total Environ. 845 , art. 157318
10.1016/j.scitotenv.2022.157318
Functional stability of novel homogeneous and heterogeneous cation exchange membranes for abiotic and microbial electrochemical technologies
J. Membr. Sci. 658 , art. 120705
10.1016/j.memsci.2022.120705
Electrochemical and microbial dissection of electrified biotrickling filters
Front. Microbiol. 13 , art. 869474
10.3389/fmicb.2022.869474
The meristem-associated endosymbiont Methylorubrum extorquens DSM13060 reprograms development and stress responses of pine seedlings
Tree Physiol. 42 (2), 391 - 410
10.1093/treephys/tpab102
MAIT cell activation is reduced by direct and microbiota-mediated exposure to bisphenols
Environ. Int. 158 , art. 106985
10.1016/j.envint.2021.106985
Electrochemical microwell plate to study electroactive microorganisms in parallel and real-time
Front. Bioeng. Biotechnol. 10 , art. 821734
10.3389/fbioe.2021.821734
Design and construction of 3D printed devices to investigate active and passive bacterial dispersal on hydrated surfaces
BMC Biol. 20 , art. 203
10.1186/s12915-022-01406-z
Editorial: Electrobiotechnology towards sustainable bioeconomy: Fundamental, optimization and applications
Front. Bioeng. Biotechnol. 10 , art. 901072
10.3389/fbioe.2022.901072
Environmental risk of arsenic mobilization from disposed sand filter materials
Environ. Sci. Technol. 56 (23), 16822 - 16830
10.1021/acs.est.2c04915
Enhancing bioenergy production from the raw and defatted microalgal biomass using wastewater as the cultivation medium
Bioengineering-Basel 9 (11), art. 637
10.3390/bioengineering9110637
Cultivation of microalgae in adjusted wastewater to enhance biofuel production and reduce environmental impact: Pyrolysis performances and life cycle assessment
J. Clean Prod. 355 , art. 131768
10.1016/j.jclepro.2022.131768
Stabilizing microbial communities by looped mass transfer
Proc. Natl. Acad. Sci. U.S.A. 119 (17), e2117814119
10.1073/pnas.2117814119
The impact of the antibiotic fosfomycin on wastewater communities measured by flow cytometry
Front. Microbiol. 12 , art. 737831
10.3389/fmicb.2021.737831
Acetyl-CoA-Carboxylase 1-mediated de novo fatty acid synthesis sustains Lgr5+ intestinal stem cell function
Nat. Commun. 13 , art. 3998
10.1038/s41467-022-31725-2
Machine learning-assisted identification of bioindicators predicts medium-chain carboxylate production performance of an anaerobic mixed culture
Microbiome 10 , art. 48
10.1186/s40168-021-01219-2
Stable isotope fractionation associated with the synthesis of hexachlorocyclohexane isomers for characterizing sources
Chemosphere 296 , art. 133938
10.1016/j.chemosphere.2022.133938
Uptake and metabolization of HCH isomers in trees examined over an annual growth period by compound-specific isotope analysis and enantiomer fractionation
Environ. Sci. Technol. 56 (14), 10120 - 10130
10.1021/acs.est.2c02697
Characterization of hexachlorocyclohexane isomer dehydrochlorination by LinA1 and LinA2 using multi-element compound-specific stable isotope analysis
Environ. Sci. Technol. 56 (23), 16848 - 16856
10.1021/acs.est.2c05334
IncP-type plasmids carrying genes for antibiotic resistance or for aromatic compound degradation are prevalent in sequenced Aromatoleum and Thauera strains
Environ. Microbiol. 24 (12), 6411 - 6425
10.1111/1462-2920.16262
Stable hydrogen isotope fractionation of hydrogen in a field injection experiment: Simulation of a gaseous H2 leakage
ACS Earth Space Chem. 6 (3), 631 - 641
10.1021/acsearthspacechem.1c00254
Effect of inoculum microbial diversity in ex situ biomethanation of hydrogen
Bioengineering-Basel 9 (11), art. 678
10.3390/bioengineering9110678
Physiological effects of 2-bromoethanesulfonate on hydrogenotrophic pure and mixed cultures
Microorganisms 10 (2), art. 355
10.3390/microorganisms10020355
Global distribution of carbohydrate utilization potential in the prokaryotic tree of life
mSystems 7 (6), e00829-22
10.1128/msystems.00829-22
Dual character of methane production improvement and antibiotic resistance genes reduction by nano-Fe2O3 addition during anaerobic digestion of swine manure
J. Clean Prod. 376 , art. 134240
10.1016/j.jclepro.2022.134240
Coupled mechanism of enhanced and inhibitory effects of nanoscale zero-valent iron on methane production and antibiotic resistance genes in anaerobic digestion of swine manure
Bioresour. Technol. 360 , art. 127635
10.1016/j.biortech.2022.127635
Biodiversity loss and climate extremes — study the feedbacks
Nature 612 (7938), 30 - 32
10.1038/d41586-022-04152-y
Analysis of carbon and hydrogen stable isotope ratios of phenolic compounds: method development and biodegradation applications
ACS ES&T Water 2 (1), 32 - 39
10.1021/acsestwater.1c00218
Template synthesis of luminescent oligoperoxide coated YBO3 nanoparticles doped with Ce3+, Tb3+ and Eu3+ ions
Opt. Mater. 124 , art. 112008
10.1016/j.optmat.2022.112008
Controlling microbial co-culture based on substrate pulsing can lead to stability through differential fitness advantages
PLoS Comput. Biol. 18 (10), e1010674
10.1371/journal.pcbi.1010674
Spatial patterns of microbial diversity in Fe-Mn deposits and associated sediments in the Atlantic and Pacific oceans
Sci. Total Environ. 837 , art. 155792
10.1016/j.scitotenv.2022.155792
Compound-specific isotopic analysis to characterize the photocatalytic reaction of TiO2 nanoparticles with diethyl phthalate
Chemosphere 307, Part 4 , art. 135892
10.1016/j.chemosphere.2022.135892
Isotope fractionation of diethyl phthalate during oxidation degradation by persulfate activated with zero-valent iron
Chem. Eng. J. 435, Part 1 , art. 132132
10.1016/j.cej.2021.132132
Microbial community composition and glyphosate degraders of two soils under the influence of temperature, total organic carbon and pH
Environ. Pollut. 297 , art. 118790
10.1016/j.envpol.2022.118790
Next-generation graphene oxide additives composite membranes for emerging organic micropollutants removal: Separation, adsorption and degradation
Chemosphere 308, Part 3 , art. 136333
10.1016/j.chemosphere.2022.136333
Microbial ecology of sulfur biogeochemical cycling at a mesothermal hot spring atop Northern Himalayas, India
Front. Microbiol. 13 , art 848010
10.3389/fmicb.2022.848010
Hetero-coupling of bio-based medium chain carboxylic acids by Kolbe electrolysis enables high fuel yield and efficiency
ChemSusChem 15 (21), e202201426
10.1002/cssc.202201426
Spatial characterization of microbial sulfur cycling in horizontal-flow constructed wetland models
Chemosphere 309, Part 1 , art. 136605
10.1016/j.chemosphere.2022.136605
Evapotranspiration dynamics in aerated and non-aerated subsurface flow treatment wetlands
Sci. Total Environ. 843 , art. 156605
10.1016/j.scitotenv.2022.156605
PredicTF: prediction of bacterial transcription factors in complex microbial communities using deep learning
Environ. Microbiome 17 , art. 7
10.1186/s40793-021-00394-x
Generation of synthetic shuttle vectors enabling modular genetic engineering of cyanobacteria
ACS Synth. Biol. 11 (5), 1758 - 1771
10.1021/acssynbio.1c00605
Compound specific isotope analysis in hydrogeology
J. Hydrol. 615, Part A , art. 128588
10.1016/j.jhydrol.2022.128588
Investigation of active site amino acid influence on carbon and chlorine isotope fractionation during reductive dechlorination
FEMS Microbiol. Ecol. 98 (8), fiac072
10.1093/femsec/fiac072
Widespread ability of ligninolytic fungi to degrade hazardous organic pollutants as the basis for the self-purification ability of natural ecosystems and for mycoremediation technologies
Appl. Sci. 12 (4), art. 2164
10.3390/app12042164
Extracellular degradation of a polyurethane oligomer involving outer membrane vesicles and further insights on the degradation of 2,4-diaminotoluene in Pseudomonas capeferrum TDA1
Sci. Rep. 12 , art. 2666
10.1038/s41598-022-06558-0
Enhanced degradation of perfluorooctanoic acid by heat-activated persulfate in the presence of zeolites
Chem. Eng. J. 429 , art. 132500
10.1016/j.cej.2021.132500
Exploring the extent of phosphorus and heavy metal uptake by single cells of Saccharomyces cerevisiae and their effects on intrinsic elements by SC-ICP-TOF-MS
Front. Microbiol. 13 , art. 870931
10.3389/fmicb.2022.870931
Adaptation and resistance: How Bacteroides thetaiotaomicron copes with the bisphenol A substitute bisphenol F
Microorganisms 10 (8), art. 1610
10.3390/microorganisms10081610
Co-fermenting pyrolysis aqueous condensate and pyrolysis syngas with anaerobic microbial communities enables L-malate production in a secondary fermentative stage
Fermentation 8 (10), art. 512
10.3390/fermentation8100512
Long-range catalytic hydrodechlorination of preadsorbed DDT at ambient temperature
Appl. Catal. B-Environ. 304 , art. 120966
10.1016/j.apcatb.2021.120966
Some mistakes and misinterpretations in the analysis of thermodynamic adsorption data
J. Mol. Liq. 352 , art. 118762
10.1016/j.molliq.2022.118762
Thickness and roughness of transparent gold-palladium anodes have no impact on growth kinetics and yield coefficients of early-stage Geobacter sulfurreducens biofilms
Bioelectrochemistry 144 , art. 108043
10.1016/j.bioelechem.2021.108043
Towards real-time determination of yield coefficients of early-stage electroactive biofilms using optical microscopy
Front. Energy Res. 10 , art. 920266
10.3389/fenrg.2022.920266
Scientists' warning of threats to mountains
Sci. Total Environ. 853 , art. 158611
10.1016/j.scitotenv.2022.158611
The EU chemicals strategy for sustainability: an opportunity to develop new approaches for hazard and risk assessment
Arch. Toxicol. 96 (8), 2381 - 2386
10.1007/s00204-022-03313-2
Beyond demonstrators — tackling fundamental problems in amplifying nature-based solutions for the post-COVID-19 world
npj Urban Sustain. 2 , art. 4
10.1038/s42949-022-00047-z
Polyphasic analysis reveals potential petroleum hydrocarbon degradation and biosurfactant production by rare biosphere thermophilic bacteria from Deception Island, an active Antarctic volcano
Front. Microbiol. 13 , art. 885557
10.3389/fmicb.2022.885557
Structural analysis of microbiomes from salt caverns used for underground gas storage
Int. J. Hydrog. Energy 47 (47), 20684 - 20694
10.1016/j.ijhydene.2022.04.170
Spatial control of microbial pesticide degradation in soil: A model-based scenario analysis
Environ. Sci. Technol. 56 (20), 14427 - 14438
10.1021/acs.est.2c03397
Borohydride and metallic copper as a robust dehalogenation system: Selectivity assessment and system optimization
Sci. Total Environ. 810 , art. 152065
10.1016/j.scitotenv.2021.152065
An in vitro reconstitution system to monitor iron transfer to the active site during the maturation of [NiFe]-hydrogenase
J. Biol. Chem. 298 (9), art. 102291
10.1016/j.jbc.2022.102291
Impact of various aeration strategies on the removal of micropollutants and biological effects in aerated horizontal flow treatment wetlands
Sci. Total Environ. 828 , art. 154423
10.1016/j.scitotenv.2022.154423
Detecting thresholds of ecological change in the anthropocene
Annu. Rev. Environ. Resour. 47 , 797 - 821
10.1146/annurev-environ-112420-015910
Opposite sides of Pantoea agglomerans and its associated commercial outlook
Microorganisms 10 (10), art. 2072
10.3390/microorganisms10102072
Heterogeneous activation of persulfate by FeS – Surface influence on selectivity
Chem. Eng. J. 450, Part 3 , art. 138192
10.1016/j.cej.2022.138192
Toward improved bioremediation strategies: Response of BAM-degradation activity to concentration and flow changes in an inoculated bench-scale sediment tank
Environ. Sci. Technol. 56 (7), 4050 - 4061
10.1021/acs.est.1c05259
Iron corrosion by methanogenic archaea characterized by stable isotope effects and crust mineralogy
Environ. Microbiol. 24 (2), 583 - 595
10.1111/1462-2920.15658
Upgrading Kolbe electrolysis – Highly efficient production of green fuels and solvents by coupling biosynthesis and electrosynthesis
Angew. Chem.-Int. Edit. 61 (50), e202210596
10.1002/anie.202210596
Exploitation of hetero- and phototrophic metabolic modules for redox-intensive whole-cell biocatalysis
Front. Bioeng. Biotechnol. 10 , art. 855715
10.3389/fbioe.2022.855715
Critical evaluation of the microbial turnover to biomass approach for the estimation of biogenic non-extractable residues (NER)
Environ. Sci. Eur. 34 , art. 15
10.1186/s12302-022-00592-5
Insights into the syntrophic microbial electrochemical oxidation of toluene: a combined chemical, electrochemical, taxonomical, functional gene-based, and metaproteomic approach
Sci. Total Environ. 850 , art. 157919
10.1016/j.scitotenv.2022.157919
Syntrophy drives the microbial electrochemical oxidation of toluene in a continuous-flow “bioelectric well”
J. Environ. Chem. Eng. 10 (3), art. 107799
10.1016/j.jece.2022.107799
Ensiling parameters in vertical columns and multiple kinetic models evaluation of biomethane potential of ensiled sugar beet leaves
Biofuels-UK 13 (8), 995 - 1005
10.1080/17597269.2022.2059964
Nutritional inter-dependencies and a carbazole-dioxygenase are key elements of a bacterial consortium relying on a Sphingomonas for the degradation of the fungicide thiabendazole
Environ. Microbiol. 24 (11), 5105 - 5122
10.1111/1462-2920.16116
Characterization of severe acute respiratory syndrome coronavirus 2 (SARS-CoV-2) infection clusters based on integrated genomic surveillance, outbreak analysis and contact tracing in an urban setting
Clin. Infect. Dis. 74 (6), 1039 - 1046
10.1093/cid/ciab588
Enhanced perchloroethene dechlorination by humic acids via increasing the dehalogenase activity of Dehalococcoides strains
FEMS Microbiol. Ecol. 98 (4), fiac034
10.1093/femsec/fiac034
Thermophilic composting of human feces: Development of bacterial community composition and antimicrobial resistance gene pool
Front. Microbiol. 13 , art. 824834
10.3389/fmicb.2022.824834
Metagenomic insights into the changes of antibiotic resistance and pathogenicity factor pools upon thermophilic composting of human excreta
Front. Microbiol. 13 , art. 826071
10.3389/fmicb.2022.826071
Quantification of biocatalytic transformations by single microbial cells enabled by tailored integration of droplet microfluidics and mass spectrometry
Angew. Chem.-Int. Edit. 61 (29), e202204098
10.1002/anie.202204098
Impact of fungal hyphae on growth and dispersal of obligate anaerobic bacteria in aerated habitats
mBio 13 (3), e00769-22
10.1128/mbio.00769-22
pH distribution along growing fungal hyphae at microscale
J. Fungi 8 (6), art. 599
10.3390/jof8060599
Transport of marine tracer phage particles in soil
Sci. Total Environ. 814 , art. 152704
10.1016/j.scitotenv.2021.152704
Phage co-transport with hyphal-riding bacteria fuels bacterial invasion in a water-unsaturated microbial model system
ISME J. 16 (5), 1275 - 1283
10.1038/s41396-021-01155-x
Mycelia-assisted isolation of non-host bacteria able to co-transport phages
Viruses 14 (2), art. 195
10.3390/v14020195
Mechanistic details of the actinobacterial lyase-catalyzed degradation reaction of 2-hydroxyisobutyryl-CoA
J. Biol. Chem. 298 (1), art. 101522
10.1016/j.jbc.2021.101522
Translational fidelity and growth of Arabidopsis require stress-sensitive diphthamide biosynthesis
Nat. Commun. 13 , art. 4009
10.1038/s41467-022-31712-7
Ferric chloride further simplified the horizontal gene transfer network of antibiotic resistance genes in anaerobic digestion
Sci. Total Environ. 844 , art. 157054
10.1016/j.scitotenv.2022.157054
“Potentially toxic element”─Something that means everything means nothing
Environ. Sci. Technol. 56 (17), 11922 - 11925
10.1021/acs.est.2c03056
Diversity of organohalide respiring bacteria and reductive dehalogenases that detoxify polybrominated diphenyl ethers in E-waste recycling sites
ISME J. 16 (9), 2123 - 2131
10.1038/s41396-022-01257-0
Efficient removal of trifluoroacetic acid from water using surface-modified activated carbon and electro-assisted desorption
J. Hazard. Mater. 436 , art. 129051
10.1016/j.jhazmat.2022.129051
Electro-assisted removal of polar and ionic organic compounds from water using activated carbon felts
Chem. Eng. J. 433, Part 2 , art. 133544
10.1016/j.cej.2021.133544
Core–shell polydopamine/Cu nanometer rods efficiently deactivate microbes by mimicking chloride-activated peroxidases
ACS Omega 7 (34), 29984 - 29994
10.1021/acsomega.2c029862021 (135)
Quality control of direct cell-mineral adhesion measurements in air and liquid using inverse AFM imaging
RSC Advances 11 (10), 5384 - 5392
10.1039/d1ra00110h
Fungi in PAH-contaminated marine sediments: Cultivable diversity and tolerance capacity towards PAH
Mar. Pollut. Bull. 164 , art. 112082
10.1016/j.marpolbul.2021.112082
Disease severity-specific neutrophil signatures in blood transcriptomes stratify COVID-19 patients
Genome Med. 13 , art. 7
10.1186/s13073-020-00823-5
Effect of oxygen contamination on propionate and caproate formation in anaerobic fermentation
Front. Bioeng. Biotechnol. 9 , art. 725443
10.3389/fbioe.2021.725443
Hydrogen as a co-electron donor for chain elongation with complex communities
Front. Bioeng. Biotechnol. 9 , art. 650631
10.3389/fbioe.2021.650631
Microbial identification, high-resolution microscopy and spectrometry of the rhizosphere in its native spatial context
Front. Plant Sci. 12 , art. 668929
10.3389/fpls.2021.668929
Towards robust Pseudomonas cell factories to harbour novel biosynthetic pathways
Essays Biochem. 65 (2), 319 - 336
10.1042/EBC20200173
The novel PII-interacting protein PirA controls flux into the cyanobacterial ornithine-ammonia cycle
mBio 12 (2), e00229-21
10.1128/mBio.00229-21
A downstream processing cascade for separation of caproic and caprylic acid from maize silage-based fermentation broth
Front. Bioeng. Biotechnol. 9 , art. 725578
10.3389/fbioe.2021.725578
Characterization of different biocatalyst formats for BVMO‐catalyzed cyclohexanone oxidation
Biotechnol. Bioeng. 118 (7), 2719 - 2733
10.1002/bit.27791
One-pot synthesis of 6-aminohexanoic acid from cyclohexane using mixed-species cultures
Microb. Biotechnol. 14 (3), 1011 - 1025
10.1111/1751-7915.13744
Characterization of membrane-bound metalloproteins in the anaerobic ammonium-oxidizing bacterium “Candidatus Kuenenia stuttgartiensis” strain CSTR1
Talanta 223 (Part 2), art. 121711
10.1016/j.talanta.2020.121711
Viability and stress state of bacteria associated with primary production or zooplankton-derived suspended particulate matter in summer along a transect in Baffin Bay (Arctic Ocean)
Sci. Total Environ. 770 , art. 145252
10.1016/j.scitotenv.2021.145252
Retention and distribution of pesticides in planted filter microcosms designed for treatment of agricultural surface runoff
Sci. Total Environ. 778 , art. 146114
10.1016/j.scitotenv.2021.146114
Metabolic history and metabolic fitness as drivers of anabolic heterogeneity in isogenic microbial populations
Environ. Microbiol. 23 (11), 6764 - 6776
10.1111/1462-2920.15756
An optimized method for RNA extraction from the polyurethane oligomer degrading strain Pseudomonas capeferrum TDA1 growing on aromatic substrates such as phenol and 2,4-diaminotoluene
PLOS One 16 (11), e0260002
10.1371/journal.pone.0260002
Electro-bioremediation of nitrate and arsenite polluted groundwater
Water Res. 190 , art. 116748
10.1016/j.watres.2020.116748
Circulating bacterial signature is linked to metabolic disease and shifts with metabolic alleviation after bariatric surgery
Genome Med. 13 , art. 105
10.1186/s13073-021-00919-6
Novel clades of soil biphenyl degraders revealed by integrating isotope probing, multi-omics, and single-cell analyses
ISME J. 15 (12), 3508 - 3521
10.1038/s41396-021-01022-9
Mechanistic insights into fast adsorption of perfluoroalkyl substances on carbonate-layered double hydroxides
J. Hazard. Mater. 408 , art. 124815
10.1016/j.jhazmat.2020.124815
General statistical scaling laws for stability in ecological systems
Ecol. Lett. 24 (7), 1474 - 1486
10.1111/ele.13760
Community and single cell analyses reveal complex predatory interactions between bacteria in high diversity systems
Nat. Commun. 12 , art. 5481
10.1038/s41467-021-25824-9
Impact of surface properties of porous SiOC‐based materials on the performance of Geobacter biofilm anodes
ChemElectroChem 8 (5), 850 - 857
10.1002/celc.202001568
Effects of combined tannic acid/fluoride on sulfur transformations and methanogenic pathways in swine manure
PLOS One 16 (9), e0257759
10.1371/journal.pone.0257759
Subcellular architecture and metabolic connection in the planktonic photosymbiosis between Collodaria (radiolarians) and their microalgae
Environ. Microbiol. 23 (11), 6569 - 6586
10.1111/1462-2920.15766
Evaluation of two methods to concentrate SARS-CoV-2 from untreated wastewater
Pathogens 10 (2), art. 195
10.3390/pathogens10020195
The metabolic flux probe (MFP)—Secreted protein as a non-disruptive information carrier for 13C-based metabolic flux analysis
Int. J. Mol. Sci. 22 (17), art. 9438
10.3390/ijms22179438
Benefits of age–Improved resistance of mature electroactive biofilm anodes in anaerobic digestion
Environ. Sci. Technol. 55 (12), 8258 - 8266
10.1021/acs.est.0c07320
Anaerobic benzene mineralization by natural microbial communities from Niger Delta
Biodegradation 32 (1), 37 - 52
10.1007/s10532-020-09922-x
Coating of solid substrates with carbon via hydrothermal carbonization
Mater. Lett. 288 , art. 129315
10.1016/j.matlet.2021.129315
Numerical heat flow and transport simulation as a development tool for the design of isothermal microcalorimeters
Thermochim. Acta 706 , art. 179070
10.1016/j.tca.2021.179070
Direct analysis of fulvic acids adsorbed onto capped gold nanoparticles by laser desorption ionization Fourier-transform ion cyclotron resonance mass spectrometry
Environ. Sci.-Nano 8 (8), 2336 - 2346
10.1039/d0en01253j
Multi-element isotopic evidence for monochlorobenzene and benzene degradation under anaerobic conditions in contaminated sediments
Water Res. 207 , art. 117809
10.1016/j.watres.2021.117809
Pore-scale modeling of microbial activity: What we have and what we need
Vadose Zone J. 20 (1), e20087
10.1002/vzj2.20087
Compost fungi allow for effective dispersal of putative PGP bacteria
Agronomy-Basel 11 (8), art. 1567
10.3390/agronomy11081567
New thermodynamic activity-based approach allows predicting the feasibility of glycolysis
Sci. Rep. 11 , art. 6125
10.1038/s41598-021-85594-8
Tracking, targeting, and conserving soil biodiversity - A monitoring and indicator system can inform policy
Science 371 (6526), 239 - 241
10.1126/science.abd7926
Hydrogen from water is more than a fuel: Hydrogenations and hydrodeoxygenations for a biobased economy
Chem. Rec. 21 (9), 2277 - 2289
10.1002/tcr.202100034
First settlers persist
Joule 5 (6), 1316 - 1319
10.1016/j.joule.2021.05.022
Coupling droplet microfluidics with ion mobility spectrometry for monitoring chemical conversions at nanoliter scale
Anal. Chem. 93 (40), 13615 - 13623
10.1021/acs.analchem.1c02883
Evidence for lignocellulose-decomposing enzymes in the genome and transcriptome of the aquatic hyphomycete Clavariopsis aquatica
J. Fungi 7 (10), art. 854
10.3390/jof7100854
Wearable sensors for human environmental exposure in urban settings
Curr. Pollut. Rep. 7 (3), 417 - 433
10.1007/s40726-021-00186-4
The role of ecotones in the dehalogenation of chloroethenes in alluvial fan aquifers
Environ. Sci. Pollut. Res. 28 (21), 26871 - 26884
10.1007/s11356-021-12538-0
Pseudomonas taiwanensis biofilms for continuous conversion of cyclohexanone in drip flow and rotating bed reactors
Eng. Life Sci. 21 (3-4), 258 - 269
10.1002/elsc.202000072
Predicting the presence and abundance of bacterial taxa in environmental communities through flow cytometric fingerprinting
mSystems 6 (5), e00551-21
10.1128/mSystems.00551-21
Beyond nitrogen: phosphorus - estimating the minimum niche dimensionality for resource competition between phytoplankton
Ecol. Lett. 24 (4), 761 - 771
10.1111/ele.13695
Superabsorbent polymer as a supplement substrate of constructed wetland to retain pesticides from agricultural runoff
Water Res. 207 , art. 117776
10.1016/j.watres.2021.117776
Free amino acid contents of selected Ethiopian plant and fungi species: a search for alternative natural free amino acid sources for cosmeceutical applications
Amino Acids 53 (7), 1105 - 1122
10.1007/s00726-021-03008-5
HumanMetagenomeDB: a public repository of curated and standardized metadata for human metagenomes
Nucleic Acids Res. 49 (D1), D743 - D750
10.1093/nar/gkaa1031
Microbial necromass in soils—Linking microbes to soil processes and carbon turnover
Front. Environ. Sci. 9 , art. 756378
10.3389/fenvs.2021.756378
Monitoring of the effects of a temporally limited heat stress on microbial communities in a shallow aquifer
Sci. Total Environ. 781 , art. 146377
10.1016/j.scitotenv.2021.146377
Metagenomic insights into the taxonomy, function, and dysbiosis of prokaryotic communities in octocorals
Microbiome 9 , art. 72
10.1186/s40168-021-01031-y
Draft genome sequence of Fusarium equiseti K3, a fungal species isolated from hexachlorocyclohexane-contaminated soil
Microbiol. Resour. Ann. 10 (47), e00885-21
10.1128/MRA.00885-21
Data reduced method for cost comparison of wastewater management scenarios - case study for two settlements in Jordan and Oman
Front. Environ. Sci. 9 , art. 626634
10.3389/fenvs.2021.626634
Wastewater treatment and wood production of willow system in cold climate
Water 13 (12), art. 1630
10.3390/w13121630
Management of Urban STormwater at Block-level (MUST-B): A new approach for potential analysis of decentralized stormwater management systems
Water 13 (3), art. 378
10.3390/w13030378
Integrative analysis of the salt stress response in cyanobacteria
Biol. Direct 16 , art. 26
10.1186/s13062-021-00316-4
Energy structure and luminescence of CeF3 crystals
Materials 14 (15), art. 4243
10.3390/ma14154243
Environmental-economic assessment of the pressure swing adsorption biogas upgrading technology
BioEnergy Res. 14 (3), 901 - 909
10.1007/s12155-020-10205-9
Comments on “Highly selective removal of perfluorinated contaminants by adsorption on all-silica zeolite Beta”
Angew. Chem.-Int. Edit. 60 (25), 13708 - 13709
10.1002/anie.202100231
Comment on “Thermal stability and decomposition of perfluoroalkyl substances on spent granular activated carbon”
Environ. Sci. Technol. Lett. 8 (4), 362 - 363
10.1021/acs.estlett.0c00742
Precious data from tiny samples: Revealing the correlation between energy content and the chemical oxygen demand of municipal wastewater using micro-bomb combustion calorimetry
Front. Energy Res. 9 , art. 705800
10.3389/fenrg.2021.705800
Microfluidic device for concentration and SERS‐based detection of bacteria in drinking water
Electrophoresis 42 (1-2), 86 - 94
10.1002/elps.202000048
Early IFN-α signatures and persistent dysfunction are distinguishing features of NK cells in severe COVID-19
Immunity 54 (11), 2650 - 2669.e14
10.1016/j.immuni.2021.09.002
Electrochemical impedance spectroscopy on biofilm electrodes – conclusive or euphonious?
Curr. Opin. Electrochem. 29 , art. 100757
10.1016/j.coelec.2021.100757
Interspecies metabolite transfer and aggregate formation in a co-culture of Dehalococcoides and Sulfurospirillum dehalogenating tetrachloroethene to ethene
ISME J. 15 (6), 1794 - 1809
10.1038/s41396-020-00887-6
Inside front cover image, Volume 118, Number 7, July 2021
Biotechnol. Bioeng. 118 (7), ii - ii
10.1002/bit.27411
Technical-scale biophotovoltaics for long-term photo-current generation from Synechocystis sp. PCC6803
Biotechnol. Bioeng. 118 (7), 2637 - 2648
10.1002/bit.27784
How to go beyond C1 products with electrochemical reduction of CO2
Sustain. Energ. Fuels 5 (23), 5893 - 5914
10.1039/d1se00861g
Pesticides are the dominant stressors for vulnerable insects in lowland streams
Water Res. 201 , art. 117262
10.1016/j.watres.2021.117262
Uptake of α-HCH by wheat from the gas phase and translocation to soil analyzed by a stable carbon isotope labeling experiment
Chemosphere 264 (Part 2), art. 128489
10.1016/j.chemosphere.2020.128489
Soil from a hexachlorocyclohexane contaminated field site inoculates wheat in a pot experiment to facilitate the microbial transformation of β-hexachlorocyclohexane examined by compound-specific isotope analysis
Environ. Sci. Technol. 55 (20), 13812 - 13821
10.1021/acs.est.1c03322
Characterizing the biotransformation of hexachlorocyclohexanes in wheat using compound-specific stable isotope analysis and enantiomer fraction analysis
J. Hazard. Mater. 406 , art. 124301
10.1016/j.jhazmat.2020.124301
Microbial communities in flexible biomethanation of hydrogen are functionally resilient upon starvation
Front. Microbiol. 12 , art. 619632
10.3389/fmicb.2021.619632
Rewiring cyanobacterial photosynthesis by the implementation of an oxygen-tolerant hydrogenase
Metab. Eng. 68 , 199 - 209
10.1016/j.ymben.2021.10.006
Extending the dimensions of personal exposure assessment: A methodological discussion on perceived and measured noise and air pollution in traffic
J. Transp. Geogr. 93 , art. 103085
10.1016/j.jtrangeo.2021.103085
The MALINA oceanographic expedition: how do changes in ice cover, permafrost and UV radiation impact biodiversity and biogeochemical fluxes in the Arctic Ocean?
Earth Syst. Sci. Data 13 (4), 1561 - 1592
10.5194/essd-13-1561-2021
High biodiversity in a benzene-degrading nitrate-reducing culture is sustained by a few primary consumers
Commun. Biol. 4 , art. 530
10.1038/s42003-021-01948-y
Temperature management potentially affects carbon mineralization capacity and microbial community composition of a shallow aquifer
FEMS Microbiol. Ecol. 97 (2), fiaa261
10.1093/femsec/fiaa261
Compound specific isotope analysis to characterize degradation mechanisms of p-chloroaniline by persulfate at ambient temperature
Chem. Eng. J. 419 , art. 129526
10.1016/j.cej.2021.129526
The effect of allicin on the proteome of SARS-CoV-2 infected Calu-3 cells
Front. Microbiol. 12 , art. 746795
10.3389/fmicb.2021.746795
Benzene degradation in contaminated aquifers: Enhancing natural attenuation by injecting nitrate
J. Contam. Hydrol. 238 , art. 103759
10.1016/j.jconhyd.2020.103759
Making sense of gas measurements: quantification of multicomponent gas mixtures in biological and chemical laboratory experiments
ChemTexts 7 (4), art. 27
10.1007/s40828-021-00151-0
Platinized titanium as alternative cost-effective anodes for the efficient Kolbe electrolysis in aqueous electrolyte solutions
ChemSusChem 14 (15), 3097 - 3109
10.1002/cssc.202100854
The anoxic electrode-driven fructose catabolism of Pseudomonas putida KT2440
Microb. Biotechnol. 14 (4), 1784 - 1796
10.1111/1751-7915.13862
Characterization of putative circular plasmids in sponge‐associated bacterial communities using a selective multiply‐primed rolling circle amplification
Mol. Ecol. Resour. 21 (1), 110 - 121
10.1111/1755-0998.13248
Anaerobic transformation and detoxification of sulfamethoxazole by sulfate-reducing enrichments and Desulfovibrio vulgaris
Environ. Sci. Technol. 55 (1), 271 - 282
10.1021/acs.est.0c03407
A biogeochemical–hydrological framework for the role of redox-active compounds in aquatic systems
Nat. Geosci. 14 (5), 264 - 272
10.1038/s41561-021-00742-z
Electrifying biotrickling filters for the treatment of aquaponics wastewater
Bioresour. Technol. 319 , art. 124221
10.1016/j.biortech.2020.124221
Photodegradation of perfluorooctanesulfonic acid on Fe-zeolites in water
Environ. Sci. Technol. 55 (1), 614 - 622
10.1021/acs.est.0c04558
Determination of elemental distribution and evaluation of elemental concentration in single Saccharomyces cerevisiae cells using single cell-inductively coupled plasma mass spectrometry
Metallomics 13 (6), mfab032
10.1093/mtomcs/mfab032
Electroactive microorganisms in mouse feces
Electrochim. Acta 365 , art. 137326
10.1016/j.electacta.2020.137326
Impact of the nitrifying community dynamics on the partial nitritation process performed by an AOB-enriched culture in a granular sludge airlift reactor
J. Environ. Chem. Eng. 9 (6), art. 106691
10.1016/j.jece.2021.106691
Redox potential heterogeneity in fixed bed electrodes leads to microbial stratification and inhomogeneous performance
ChemSusChem 14 (4), 1155 - 1165
10.1002/cssc.202002611
Evolutionary relationships of Ljungan virus variants circulating in multi-host systems across Europe
Viruses 13 (7), art. 1317
10.3390/v13071317
Microbes trading electricity in consortia of environmental and biotechnological significance
Curr. Opin. Biotechnol. 67 , 119 - 129
10.1016/j.copbio.2021.01.014
Conditioning film and early biofilm succession on plastic surfaces
Environ. Sci. Technol. 55 (16), 11006 - 11018
10.1021/acs.est.0c07875
What is specific in adsorption of perfluoroalkyl acids on carbon materials?
Chemosphere 273 , art. 128520
10.1016/j.chemosphere.2020.128520
Controlling adsorption of perfluoroalkyl acids on activated carbon felt by means of electrical potentials
Chem. Eng. J. 416 , art. 129070
10.1016/j.cej.2021.129070
Whole-cell biocatalysis using the Acidovorax sp. CHX100 Δ6HX for the production of ω-hydroxycarboxylic acids from cycloalkanes
New Biotech. 60 , 200 - 206
10.1016/j.nbt.2020.10.009
How comparable are microbial electrochemical systems around the globe? An electrochemical and microbiological cross‐laboratory study
ChemSusChem 14 (11), 2313 - 2330
10.1002/cssc.202100294
Cover profile: How comparable are microbial electrochemical systems around the globe? An electrochemical and microbiological cross‐laboratory study
ChemSusChem 14 (11), 2267 - 2267
10.1002/cssc.202100824
OrtSuite: from genomes to prediction of microbial interactions within targeted ecosystem processes
Life Sci. Alliance 4 (12), e202101167
10.26508/lsa.202101167
Mining synergistic microbial interactions: a roadmap on how to integrate multi-omics data
Microorganisms 9 (4), art. 840
10.3390/microorganisms9040840
The electrode potential determines the yield coefficients of early-stage Geobacter sulfurreducens biofilm anodes
Bioelectrochemistry 140 , art. 107752
10.1016/j.bioelechem.2021.107752
Perspectives of individual-worn sensors assessing personal environmental exposure
Engineering 7 (3), 285 - 289
10.1016/j.eng.2020.07.023
Antibacterial effect of a brominated self-etch adhesive on carious dentin - An in vivo study
J. Dent. 105 , art. 103555
10.1016/j.jdent.2020.103555
Bio-imaging with the helium-ion microscope: A review
Beilstein J. Nanotechnol. 12 , 1 - 23
10.3762/bjnano.12.1
New provisional function of OmpA from Acinetobacter sp. strain SA01 based on environmental challenges
mSystems 6 (1), e01175-20
10.1128/mSystems.01175-20
Comparative proteomics unravelled the hexachlorocyclohexane (HCH) isomers specific responses in an archetypical HCH degrading bacterium Sphingobium indicum B90A
Environ. Sci. Pollut. Res. 28 (30), 41380 - 41395
10.1007/s11356-021-13073-8
Removal of micropollutants and biological effects by conventional and intensified constructed wetlands treating municipal wastewater
Water Res. 201 , art. 117349
10.1016/j.watres.2021.117349
A curve-shift technique for the use of non-conservative organic tracers in constructed wetlands
Sci. Total Environ. 752 , art. 141818
10.1016/j.scitotenv.2020.141818
Electron inventory of the iron-sulfur scaffold complex HypCD essential in [NiFe]-hydrogenase cofactor assembly
Biochem. J. 478 (17), 3281 - 3295
10.1042/BCJ20210224
Evidence of heterogeneous degradation of PFOA by activated persulfate – FeS as adsorber and activator
Chem. Eng. J. 423 , art. 130102
10.1016/j.cej.2021.130102
Mass-transfer-limited biodegradation at low concentrations—Evidence from reactive transport modeling of isotope profiles in a bench-scale aquifer
Environ. Sci. Technol. 55 (11), 7386 - 7397
10.1021/acs.est.0c08566
Magnitude of diffusion- and transverse dispersion-induced isotope fractionation of organic compounds in aqueous systems
Environ. Sci. Technol. 55 (8), 4772 - 4782
10.1021/acs.est.0c06741
Complementary roles of wood-inhabiting fungi and bacteria facilitate deadwood decomposition
mSystems 6 (1), e01078-20
10.1128/mSystems.01078-20
Metagenomes, metatranscriptomes and microbiomes of naturally decomposing deadwood
Sci. Data 8 , art. 198
10.1038/s41597-021-00987-8
Genome sequence, proteome profile, and identification of a multiprotein reductive dehalogenase complex in Dehalogenimonas alkenigignens strain BRE15M
J. Proteome Res. 20 (1), 613 - 623
10.1021/acs.jproteome.0c00569
Simultaneous removal of hydrocarbons and sulfate from groundwater using a “bioelectric well”
Electrochim. Acta 388 , art. 138636
10.1016/j.electacta.2021.138636
Cytoklepty in the plankton: A host strategy to optimize the bioenergetic machinery of endosymbiotic algae
Proc. Natl. Acad. Sci. U.S.A. 118 (27), e2025252118
10.1073/pnas.2025252118
Enzymatic degradation of polyethylene terephthalate nanoplastics analyzed in real time by isothermal titration calorimetry
Sci. Total Environ. 773 , art. 145111
10.1016/j.scitotenv.2021.145111
Phage strategies facilitate bacterial coexistence under environmental variability
PeerJ 9 , e12194
10.7717/peerj.12194
New developments in biological phosphorus accessibility and recovery approaches from soil and waste streams
Eng. Life Sci. 21 (3-4), 77 - 86
10.1002/elsc.202000076
A framework for P-cycle assessment in wastewater treatment plants
Sci. Total Environ. 760 , art. 143392
10.1016/j.scitotenv.2020.143392
Technologies and perspectives for achieving carbon neutrality
The Innovation 2 (4), art. 100180
10.1016/j.xinn.2021.100180
Microbial activity and metamitron degrading microbial communities differ between soil and water-sediment systems
J. Hazard. Mater. 408 , art. 124293
10.1016/j.jhazmat.2020.124293
Swarm Learning for decentralized and confidential clinical machine learning
Nature 594 (7862), 265 - 270
10.1038/s41586-021-03583-3
Extracellular and intracellular lanthanide accumulation in the methylotrophic Beijerinckiaceae bacterium RH AL1
Appl. Environ. Microb. 87 (13), e03144-20
10.1128/AEM.03144-20
Disentangling multiple chemical and non-chemical stressors in a lotic ecosystem using a longitudinal approach
Sci. Total Environ. 769 , art. 144324
10.1016/j.scitotenv.2020.144324
Figures of merit for photocatalysis: Comparison of NiO/La-NaTaO3 and Synechocystis sp. PCC 6803 as a semiconductor and a bio-photocatalyst for water splitting
Catalysts 11 (11), art. 1415
10.3390/catal11111415
Carbon, hydrogen and nitrogen stable isotope fractionation allow characterizing the reaction mechanisms of 1H-benzotriazole aqueous phototransformation
Water Res. 203 , art. 117519
10.1016/j.watres.2021.117519
Outer-sphere electron transfer does not underpin B12-dependent olefinic reductive dehalogenation in anaerobes
Phys. Chem. Chem. Phys. 23 (48), 27520 - 27524
10.1039/d1cp04632b
Identification of reductive dehalogenases that mediate complete debromination of penta- and tetrabrominated diphenyl ethers in Dehalococcoides spp.
Appl. Environ. Microb. 87 (17), e00602-21
10.1128/AEM.00602-21
Adsorption of polar and ionic organic compounds on activated carbon: Surface chemistry matters
Sci. Total Environ. 794 , art. 148508
10.1016/j.scitotenv.2021.1485082020 (152)
A new approach for repeated tip-sample relocation for AFM imaging of nano and micro sized particles and cells in liquid environment
Ultramicroscopy 211 , art. 112945
10.1016/j.ultramic.2020.112945
A survey of extended-spectrum beta-lactamase-producing Enterobacteriaceae in urban wetlands in southwestern Nigeria as a step towards generating prevalence maps of antimicrobial resistance
PLOS One 15 (3), e0229451
10.1371/journal.pone.0229451
Combined application of Bacillus sp. MN-54 and phosphorus improved growth and reduced lead uptake by maize in the lead-contaminated soil
Environ. Sci. Pollut. Res. 27 (35), 44528 - 44539
10.1007/s11356-020-10372-4
Enhanced remediation of Cr6+ in bacterial‐assisted floating wetlands
Water Environ. J. 34 (51), 970 - 978
10.1111/wej.12551
Enhanced growth of mungbean and remediation of petroleum hydrocarbons by Enterobacter sp. MN17 and biochar addition in diesel contaminated soil
Appl. Sci. 10 (23), art. 8548
10.3390/app10238548
A practical step towards sustainability: decentralised wastewater management in Oman
Desalin. Water Treat. 176 , 360 - 369
10.5004/dwt.2020.25545
Investigating community dynamics and performance during microbial electrochemical degradation of whey
ChemElectroChem 7 (4), 989 - 997
10.1002/celc.201902109
Warming the phycosphere: Differential effect of temperature on the use of diatom‐derived carbon by two copiotrophic bacterial taxa
Environ. Microbiol. 22 (4), 1381 - 1396
10.1111/1462-2920.14954
Novel multifunctional ion exchangers for metal ions removal in the presence of citric acid
Chemosphere 251 , art. 126331
10.1016/j.chemosphere.2020.126331
Coupling an electroactive Pseudomonas putida KT2440 with bioelectrochemical rhamnolipid production
Microorganisms 8 (12), art. 1959
10.3390/microorganisms8121959
Microbial degradation of hydrocarbons—basic principles for bioremediation: A review
Molecules 25 (4), art. 856
10.3390/molecules25040856
Evolutionary engineering of E. coli MG1655 for tolerance against isoprenol
Biotechnol. Biofuels 13 , art. 183
10.1186/s13068-020-01825-6
Increasing ibuprofen degradation in constructed wetlands by bioaugmentation with gravel containing biofilms of an ibuprofen-degrading Sphingobium yanoikuyae
Eng. Life Sci. 20 (5-6), 160 - 167
10.1002/elsc.201900097
The role of nickel traces in fine chemicals for hydrodechlorination reactions with zero-valent iron
Chem. Eng. J. 388 , art. 124185
10.1016/j.cej.2020.124185
Prospects for integrating disturbances, biodiversity and ecosystem functioning using microbial systems
Front. Ecol. Evol. 8 , art. 21
10.3389/fevo.2020.00021
A modular metagenomics pipeline allowing for the inclusion of prior knowledge using the example of anaerobic digestion
Microorganisms 8 (5), art. 669
10.3390/microorganisms8050669
Early‐stage sustainability assessment of biotechnological processes: A case study of citric acid production
Eng. Life Sci. 20 (3-4), 90 - 103
10.1002/elsc.201800198
Surface cleaning and sample carrier for complementary high-resolution imaging techniques
Biointerphases 15 (2), art. 021005
10.1116/1.5143203
Longitudinal multi-omics analyses identify responses of megakaryocytes, erythroid cells, and plasmablasts as hallmarks of severe COVID-19
Immunity 53 (6), 1296 - 1314
10.1016/j.immuni.2020.11.017
Environmental factors and host microbiomes shape host–pathogen dynamics
Trends Parasitol. 36 (7), 616 - 633
10.1016/j.pt.2020.04.010
Effect of temperature on acetate mineralization kinetics and microbial community composition in a hydrocarbon-affected microbial community during a shift from microoxic to sulfidogenic conditions
Front. Microbiol. 11 , art. 606565
10.3389/fmicb.2020.606565
Genetic cell-surface modification for optimized foam fractionation
Front. Bioeng. Biotechnol. 8 , art. 572892
10.3389/fbioe.2020.572892
Chemoassay profiling of benzoates and salicylates to assess their skin sensitization potential
Naunyn-Schmiedebergs Arch. Pharmacol. 393 (Suppl. 1), 85 - 85
10.1007/s00210-020-01828-y
Do wastewater pollutants impact oxygen transfer in aerated horizontal flow wetlands?
Chem. Eng. J. 383 , art. 123173
10.1016/j.cej.2019.123173
TerrestrialMetagenomeDB: a public repository of curated and standardized metadata for terrestrial metagenomes
Nucleic Acids Res. 48 (D1), D626 - D632
10.1093/nar/gkz994
Small but smart: On the diverse role of small proteins in the regulation of cyanobacterial metabolism
Life 10 (12), art. 322
10.3390/life10120322
Towards biorecycling: Isolation of a soil bacterium that grows on a polyurethane oligomer and monomer
Front. Microbiol. 11 , art. 404
10.3389/fmicb.2020.00404
Biotransformation of phthalate plasticizers and bisphenol A by marine-derived, freshwater, and terrestrial fungi
Front. Microbiol. 11 , art. 317
10.3389/fmicb.2020.00317
Keystone species and modularity in microbial hydrocarbon degradation uncovered by network analysis and association rule mining
Microorganisms 8 (2), art. 190
10.3390/microorganisms8020190
Effect of energy deprivation on metabolite release by anaerobic marine naphthalene‐degrading sulfate‐reducing bacteria
Environ. Microbiol. 22 (9), 4057 - 4066
10.1111/1462-2920.15195
The Great Oxidation Event expanded the genetic repertoire of arsenic metabolism and cycling
Proc. Natl. Acad. Sci. U.S.A. 117 (19), 10414 - 10421
10.1073/pnas.2001063117
Bacterial mock communities as standards for reproducible cytometric microbiome analysis
Nat. Protoc. 15 , 2788 - 2812
10.1038/s41596-020-0362-0
How to accurately assess surfactant biodegradation-impact of sorption on the validity of results
Appl. Microbiol. Biotechnol. 104 (1), 1 - 12
10.1007/s00253-019-10202-9
Groundwater protection under water scarcity; from regional risk assessment to local wastewater treatment solutions in Jordan
Sci. Total Environ. 706 , art. 136066
10.1016/j.scitotenv.2019.136066
In situ pilot application of nZVI embedded in activated carbon for remediation of chlorinated ethene‑contaminated groundwater: effect on microbial communities
Environ. Sci. Eur. 32 , art. 154
10.1186/s12302-020-00434-2
Effect of tannic acid combined with fluoride and lignosulfonic acid on anaerobic digestion in the agricultural waste management chain
Bioresour. Technol. 307 , art. 123171
10.1016/j.biortech.2020.123171
High resolution microscopy to evaluate the efficiency of surface sterilization of Zea Mays seeds
PLOS One 15 (11), e0242247
10.1371/journal.pone.0242247
Subcellular chemical imaging: New avenues in cell biology
Trends Cell Biol. 30 (3), 173 - 188
10.1016/j.tcb.2019.12.007
Identification and characterization of a bacterial core methionine synthase
Sci. Rep. 10 , art. 2100
10.1038/s41598-020-58873-z
Comparative genomics and proteomics in "Candidatus Kuenenia stuttgartiensis" reveal high genomic plasticity in the overall genome structure, CRISPR loci and surface proteins
BMC Genomics 21 , art. 851
10.1186/s12864-020-07242-1
16S rRNA gene-based primer pair showed high specificity and quantification accuracy in detecting freshwater Brocadiales anammox bacteria
FEMS Microbiol. Ecol. 96 (3), fiaa013
10.1093/femsec/fiaa013
Microfluidic single-cell analysis in biotechnology: from monitoring towards understanding
Curr. Opin. Biotechnol. 63 , 26 - 33
10.1016/j.copbio.2019.11.001
Phragmites australis in combination with hydrocarbons degrading bacteria is a suitable option for remediation of diesel-contaminated water in floating wetlands
Chemosphere 240 , art. 124890
10.1016/j.chemosphere.2019.124890
Anaerobic digestion of co-ensiled cover crop and barley straw: Effect of co-ensiling ratios, manure addition and impact on microbial community structure
Ind. Crop. Prod. 144 , art. 112025
10.1016/j.indcrop.2019.112025
Beyond sugar and ethanol production: Value generation opportunities through sugarcane residues
Front. Energy Res. 8 , art. 579577
10.3389/fenrg.2020.579577
Dual element (C/Cl) isotope analysis indicates distinct mechanisms of reductive dehalogenation of chlorinated ethenes and dichloroethane in Dehalococcoides mccartyi strain BTF08 with defined reductive dehalogenase inventories
Front. Microbiol. 11 , art. 1507
10.3389/fmicb.2020.01507
How to speed up the detection of aerobic microbial contaminations by using isothermal microcalorimetry
J. Therm. Anal. Calorim. 142 (5), 1933 - 1949
10.1007/s10973-020-09986-0
Rapid culture‐based detection of Legionella pneumophila using isothermal microcalorimetry with an improved evaluation method
Microb. Biotechnol. 13 (4), 1262 - 1272
10.1111/1751-7915.13563
Microbial electrosynthesis – An inventory on technology readiness level and performance of different process variants
Biotechnol. J. 15 (10), art. 2000066
10.1002/biot.202000066
In-situ treatment of herbicide-contaminated groundwater–Feasibility study for the cases atrazine and bromacil using two novel nanoremediation-type materials
J. Hazard. Mater. 393 , art. 122470
10.1016/j.jhazmat.2020.122470
Requirements for chromium reactors for use in the determination of H isotopes in compound-specific stable isotope analysis cf chlorinated compounds
Anal. Chem. 92 (3), 2383 - 2387
10.1021/acs.analchem.9b04737
Standard Gibbs energy of metabolic reactions: VI. Glyceraldehyde 3-phosphate dehydrogenase reaction
Fluid Phase Equilib. 517 , art. 112597
10.1016/j.fluid.2020.112597
Standard Gibbs energy of metabolic reactions: V. Enolase reaction
BBA-Proteins Proteomics 1868 (4), art. 140365
10.1016/j.bbapap.2020.140365
Blind spots in global soil biodiversity and ecosystem function research
Nat. Commun. 11 (1), art. 3870
10.1038/s41467-020-17688-2
Photosynthesis‐driven methane production in oxic lake water as an important contributor to methane emission
Limnol. Oceanogr. 65 (12), 2853 - 2865
10.1002/lno.11557
The influence of periphyton on the migration and transformation of arsenic in the paddy soil: Rules and mechanisms
Environ. Pollut. 263, Part B , art. 114624
10.1016/j.envpol.2020.114624
Monitoring stratification of anode biofilms in bioelectrochemical laminar flow reactors using flow cytometry
Environ. Sci. Ecotechnol. 4 , art. 10062
10.1016/j.ese.2020.100062
Gastric bypass surgery in a rat model alters the community structure and functional composition of the intestinal microbiota independently of weight loss
Microbiome 8 , art. 13
10.1186/s40168-020-0788-1
Coupled electrochemical and microbial catalysis for the production of polymer bricks
ChemSusChem 13 (19), 5295 - 5300
10.1002/cssc.202001272
The impact of glass material on growth and biocatalytic performance of mixed-species biofilms in capillary reactors for continuous cyclohexanol production
Front. Bioeng. Biotechnol. 8 , art. 588729
10.3389/fbioe.2020.588729
Taxonomic and functional diversity of the microbiome in a jet fuel contaminated site as revealed by combined application of in situ microcosms with metagenomic analysis
Sci. Total Environ. 708 , art. 135152
10.1016/j.scitotenv.2019.135152
Reductive debromination by sponge-associated anaerobic bacteria coupled to carbon isotope fractionation
Int. Biodeterior. Biodegrad. 155 , art. 105093
10.1016/j.ibiod.2020.105093
Isotope fractionation (2H/1H, 13C/12C, 37Cl/35Cl) in trichloromethane and trichloroethene caused by partitioning between gas phase and water
Environ. Sci.-Process Impacts 22 (3), 617 - 626
10.1039/c9em00583h
Attachment efficiency of nanomaterials to algae as an important criterion for ecotoxicity and grouping
Nanomaterials 10 (6), art. 1021
10.3390/nano10061021
Aquatische Makrophyten als Indikatoren für die Elementverteilung im Fließgewässer Mulde (Mitteldeutschland) – Aquatic macrophytes as indicators for element distribution in river water in the Mulde River (central Germany)
Hydrol. Wasserbewirtsch. 64 (3), 127 - 140
10.5675/HyWa_2020.3_2
Biorefinery perspectives of microbial electrolysis cells (MECs) for hydrogen and valuable chemicals production through wastewater treatment
Biofuel Res. J. 25 , 1128 - 1142
10.18331/BRJ2020.7.1.5
Diversity and coexistence are influenced by time-dependent species interactions in a predator-prey system
Ecol. Lett. 23 (6), 983 - 993
10.1111/ele.13500
Chlorine isotope fractionation of the major chloromethane degradation processes in the environment
Environ. Sci. Technol. 54 (3), 1634 - 1645
10.1021/acs.est.9b06139
A Sporolactobacillus-, Clostridium-, and Paenibacillus-dominant microbial consortium improved anaerobic RDX detoxification by starch addition
J. Microbiol. Biotechnol. 30 (6), 839 - 847
10.4014/jmb.1910.10034
Distinct nitrogen cycling and steep chemical gradients in Trichodesmium colonies
ISME J. 14 (2), 399 - 412
10.1038/s41396-019-0514-9
Label‐free four‐dimensional visualization of anaerobically growing electroactive biofilms
Cytom. Part A 97 (7), 737 - 741
10.1002/cyto.a.24169
Assessing the life-cycle sustainability of algae and bacteria-based wastewater treatment systems: High-rate algae pond and sequencing batch reactor
J. Environ. Manage. 264 , art. 110459
10.1016/j.jenvman.2020.110459
Physical, chemical and biological effects on soil bacterial dynamics in microscale models
Front. Ecol. Evol. 8 , art. 53
10.3389/fevo.2020.00053
Comment to the article “Hydroxyl radical scavenging by solid mineral surfaces in oxidative treatment systems: Rate constants and implications” published by K. Rusevova Crincoli and S. G. Huling in Water Research 169, 2020, 115240
Water Res. 186 , art. 116308
10.1016/j.watres.2020.116308
H/D-isotope fractionation due to aqueous phase diffusion – Deuterated hydrocarbons revisited
Chemosphere 258 , art. 127357
10.1016/j.chemosphere.2020.127357
Letter: What are the active species in the photocatalytic disinfection of water?
Chem 6 (4), 806 - 807
10.1016/j.chempr.2020.03.008
Interaction of zero-valent iron and carbonaceous materials for reduction of DDT
Chemosphere 253 , art. 126712
10.1016/j.chemosphere.2020.126712
Determining incremental coulombic efficiency and physiological parameters of early stage Geobacter spp. enrichment biofilms
PLOS One 15 (6), e0234077
10.1371/journal.pone.0234077
Cover profile: Availability of hydrogen shapes the microbial abundance in biofilm anodes based on Geobacter enrichment
ChemElectroChem 7 (18), 3683 - 3683
10.1002/celc.202001006
Availability of hydrogen shapes the microbial abundance in biofilm anodes based on Geobacter enrichment
ChemElectroChem 7 (18), 3720 - 3724
10.1002/celc.202000731
Following the community development of SIHUMIx – a new intestinal in vitro model for bioreactor use
Gut Microbes 11 (4), 1116 - 1129
10.1080/19490976.2019.1702431
The activation of mucosal-associated invariant T (MAIT) cells is affected by microbial diversity and riboflavin utilization in vitro
Front. Microbiol. 11 , art. 755
10.3389/fmicb.2020.00755
Economic process evaluation and environmental life-cycle assessment of bio-aromatics production
Front. Bioeng. Biotechnol. 8 , art. 403
10.3389/fbioe.2020.00403
Simultaneous compound-specific analysis of δ33S and δ34S in organic compounds by GC-MC-ICPMS using medium- and low-mass-resolution modes
Anal. Chem. 92 (21), 14685 - 14692
10.1021/acs.analchem.0c03253
Cytochrome c reductase is a key enzyme involved in the extracellular electron transfer pathway towards transition metal complexes in Pseudomonas putida
ChemSusChem 13 (19), 5308 - 5317
10.1002/cssc.202001645
Biotransformation of hexachlorocyclohexanes contaminated biomass for energetic utilization demonstrated in continuous anaerobic digestion system
J. Hazard. Mater. 384 , art. 121448
10.1016/j.jhazmat.2019.121448
Microbial necromass on the rise: The growing focus on its role in soil organic matter development
Soil Biol. Biochem. 150 , art. 108000
10.1016/j.soilbio.2020.108000
Competition between butyrate fermenters and chain-elongating bacteria limits the efficiency of medium-chain carboxylate production
Front. Microbiol. 11 , art. 336
10.3389/fmicb.2020.00336
Three novel Clostridia isolates produce n-caproate and iso-butyrate from lactate: comparative genomics of chain-elongating bacteria
Microorganisms 8 (12), art. 1970
10.3390/microorganisms8121970
Draft genome sequences of three Clostridia isolates involved in lactate-based chain elongation
Microbiol. Resour. Ann. 9 (32), e00679-20
10.1128/MRA.00679-20
Transcriptomic and proteomic responses of the organohalide-respiring bacterium Desulfoluna spongiiphila to growth with 2,6-dibromophenol as the electron acceptor
Appl. Environ. Microb. 86 (5), e02146-19
10.1128/AEM.02146-19
Compound-specific isotope analysis and enantiomer fractionation to characterize the transformation of hexachlorocyclohexane isomers in a soil–wheat pot system
Environ. Sci. Technol. 54 (14), 8690 - 8698
10.1021/acs.est.9b07609
Dual C–Cl isotope analysis for characterizing the anaerobic transformation of α, β, γ, and δ-hexachlorocyclohexane in contaminated aquifers
Water Res. 184 , art. 116128
10.1016/j.watres.2020.116128
Dual C–Cl isotope analysis for characterizing the reductive dechlorination of α- and γ-hexachlorocyclohexane by two Dehalococcoides mccartyi strains and an enrichment culture
Environ. Sci. Technol. 54 (12), 7250 - 7260
10.1021/acs.est.9b06407
Bacterial community diversity dynamics highlight degrees of nestedness and turnover patterns
Cytom. Part A 97 (7), 742 - 748
10.1002/cyto.a.23965
Microbial resource management for ex situ biomethanation of hydrogen at alkaline pH
Microorganisms 8 , art. 614
10.3390/microorganisms8040614
Metagenomics and stable isotope probing reveal the complementary contribution of fungal and bacterial communities in the recycling of dead biomass in forest soil
Soil Biol. Biochem. 148 , art. 107875
10.1016/j.soilbio.2020.107875
Fate of pendimethalin in soil and characterization of non-extractable residues (NER)
Sci. Total Environ. 753 , art. 141870
10.1016/j.scitotenv.2020.141870
The planned and the perceived city: A comparison of cyclists' and decision-makers' views on cycling quality
J. Transp. Geogr. 82 , art. 102602
10.1016/j.jtrangeo.2019.102602
Metagenome-assembled genome sequences of three uncultured Planktomarina sp. strains from the Northeast Atlantic Ocean
Microbiol. Resour. Ann. 9 (12), e00127-20
10.1128/MRA.00127-20
Manganese-oxidizing bacteria form multiple cylindrospermopsin transformation products with reduced human liver cell toxicity
Sci. Total Environ. 729 , art. 138924
10.1016/j.scitotenv.2020.138924
Adipose tissue derived bacteria are associated with inflammation in obesity and type 2 diabetes
Gut 69 (10), 1796 - 1806
10.1136/gutjnl-2019-320118
Response‐surface‐optimized and scaled‐up microbial electrosynthesis of chiral alcohols
ChemSusChem 13 (7), 1808 - 1816
10.1002/cssc.201903428
Mucosal-associated invariant T-Cell (MAIT) activation is altered by chlorpyrifos- and glyphosate-treated commensal gut bacteria
J. Immunotoxicol. 17 (1), 10 - 20
10.1080/1547691X.2019.1706672
Benzylsuccinate synthase is post-transcriptionally regulated in the toluene-degrading denitrifier Magnetospirillum sp. strain 15-1
Microorganisms 8 (5), art. 681
10.3390/microorganisms8050681
Directed reaction engineering boosts succinate formation of Synechocystis sp. PCC 6803_Δsll1625
Biotechnol. J. 15 (11), art. 2000127
10.1002/biot.202000127
Does glucose affect the de-esterification of methyl ferulate by Lactobacillus buchneri?
MicrobiologyOpen 9 (2), e971
10.1002/mbo3.971
Microorganisms and their activities within microbial communities
Cytom. Part A 97 (7), 681 - 682
10.1002/cyto.a.24175
Degradation of glyphosate in a Colombian soil is influenced by temperature, total organic carbon content and pH
Environ. Pollut. 259 , art. 113767
10.1016/j.envpol.2019.113767
Identification of benzene-degrading Proteobacteria in a constructed wetland by employing in situ microcosms and RNA-stable isotope probing
Appl. Microbiol. Biotechnol. 104 (4), 1809 - 1820
10.1007/s00253-019-10323-1
The molecular study of microbial and functional diversity of resistant microbes in heavy metal contaminated soil
Environ. Technol. Innov. 17 , art. 100606
10.1016/j.eti.2020.100606
Plant litter enhances degradation of the herbicide MCPA and increases formation of biogenic non-extractable residues in soil
Environ. Int. 142 , art. 105867
10.1016/j.envint.2020.105867
Biotechnological utilization of animal gut microbiota for valorization of lignocellulosic biomass
Appl. Microbiol. Biotechnol. 104 (2), 489 - 508
10.1007/s00253-019-10239-w
Metagenomic- and cultivation-based exploration of anaerobic chloroform biotransformation in hypersaline sediments as natural source of chloromethanes
Microorganisms 8 (5), art. 665
10.3390/microorganisms8050665
Transformation of chlorofluorocarbons investigated via stable carbon compound-specific isotope analysis
Environ. Sci. Technol. 54 (2), 870 - 878
10.1021/acs.est.9b05746
μBialSim: Constraint-based dynamic simulation of complex microbiomes
Front. Bioeng. Biotechnol. 8 , art. 574
10.3389/fbioe.2020.00574
Degradation of perfluorooctanoic acid adsorbed on Fe-zeolites with molecular oxygen as oxidant under UV-A irradiation
Appl. Catal. B-Environ. 278 , art. 119283
10.1016/j.apcatb.2020.119283
Near streambed flow shapes microbial guilds within and across trophic levels in fluvial biofilms
Limnol. Oceanogr. 65 (10), 2261 - 2277
10.1002/lno.11451
Correlia: an ImageJ plug‐in to co‐register and visualise multi‐modal correlative micrographs
J. Microsc. 280 (1), 3 - 11
10.1111/jmi.12928
New structural insights into bacterial sulfoacetaldehyde and taurine metabolism
Biochem. J. 477 (8), 1367 - 1371
10.1042/BCJ20200079
Actinobacterial degradation of 2-hydroxyisobutyric acid proceeds via acetone and formyl-CoA by employing a thiamine-dependent lyase reaction
Front. Microbiol. 11 , art. 691
10.3389/fmicb.2020.00691
In vitro elucidation of suppression effects of composts to soil-borne pathogen Phytophthora nicotianae on pepper plants using 16S amplicon sequencing and metaproteomics
Renew. Agr. Food Syst. 35 (2), 206 - 214
10.1017/S1742170518000467
IL4I1 is a metabolic immune checkpoint that activates the AHR and promotes tumor progression
Cell 182 (5), 1252 - 1270.e34
10.1016/j.cell.2020.07.038
Understanding the effect of carbon surface chemistry on adsorption of perfluorinated alkyl substances
Chem. Eng. J. 381 , art. 122689
10.1016/j.cej.2019.122689
Rational engineering of a multi-step biocatalytic cascade for the conversion of cyclohexane to polycaprolactone monomers in Pseudomonas taiwanensis
Biotechnol. J. 15 (11), art. 2000091
10.1002/biot.202000091
Maximizing biocatalytic cyclohexane hydroxylation by modulating cytochrome P450 monooxygenase expression in P. taiwanensis VLB120
Front. Bioeng. Biotechnol. 8 , art. 140
10.3389/fbioe.2020.00140
Environmentally relevant concentration of bisphenol S shows slight effects on SIHUMIx
Microorganisms 8 (9), art. 1436
10.3390/microorganisms8091436
In vitro and in vivo lipidomics as a tool for probiotics evaluation
Appl. Microbiol. Biotechnol. 104 (20), 8937 - 8948
10.1007/s00253-020-10864-w
Conversion efficiencies of a few living microbial cells detected at a high throughput by droplet-based ESI-MS
Anal. Chem. 92 (15), 10700 - 10708
10.1021/acs.analchem.0c01839
Effect of a bioactive cement on the microbial community in carious dentin after selective caries removal – An in-vivo study
J. Dent. 92 , art. 103264
10.1016/j.jdent.2019.103264
Severe COVID-19 is marked by a dysregulated myeloid cell compartment
Cell 182 (6), 1419 - 1440
10.1016/j.cell.2020.08.001
Effects of electrokinetic phenomena on bacterial deposition monitored by quartz crystal microbalance with dissipation monitoring
Environ. Sci. Technol. 54 (21), 14036 - 14045
10.1021/acs.est.0c04347
Electrokinetic effects on the interaction of phenanthrene with geo-sorbents
Chemosphere 242 , art. 125161
10.1016/j.chemosphere.2019.125161
Resilience of micropollutant and biological effect removal in an aerated horizontal flow treatment wetland
Water 12 (11), art. 3050
10.3390/w12113050
Reagent or catalyst? – FeS as activator for persulfate in water
Chem. Eng. J. 387 , art. 123804
10.1016/j.cej.2019.123804
Dynamics of hydrocarbon mineralization characterized by isotopic analysis at a jet-fuel-contaminated site in subtropical climate
J. Contam. Hydrol. 234 , art. 103684
10.1016/j.jconhyd.2020.103684
Regulatory systems for gene expression control in cyanobacteria
Appl. Microbiol. Biotechnol. 104 (5), 1977 - 1991
10.1007/s00253-019-10344-w
Complexation by cysteine and iron mineral adsorption limit cadmium mobility during metabolic activity of Geobacter sulfurreducens
Environ. Sci.-Process Impacts 22 (9), 1877 - 1887
10.1039/d0em00244e
Groundwater nitrification and denitrification are not always strictly aerobic and anaerobic processes, respectively: an assessment of dual-nitrate isotopic and chemical evidence in a stratified alluvial aquifer
Biogeochemistry 147 (2), 211 - 223
10.1007/s10533-020-00637-y
Defined microbial mixed culture for utilization of polyurethane monomers
ACS Sustain. Chem. Eng. 8 (47), 17466 - 17474
10.1021/acssuschemeng.0c06019
Influence of cytosolic conditions on the reaction equilibrium and the reaction enthalpy of the enolase reaction accessed by calorimetry and van ‘t HOFF
Biochim. Biophys. Acta-Gen. Subj. 1864 (10), art. 129675
10.1016/j.bbagen.2020.129675
Application of irreversible thermodynamics to determine the influence of cell mimicking conditions on the kinetics of equilibrium reactions of the glycolysis
Biophys. J. 118 (3, Suppl. 1), 346a - 347a
10.1016/j.bpj.2019.11.2000
Thermodynamics and kinetics of glycolytic reactions. Part I: Kinetic modeling based on irreversible thermodynamics and validation by calorimetry
Int. J. Mol. Sci. 21 (21), art. 8341
10.3390/ijms21218341
Thermodynamics and kinetics of glycolytic reactions. Part II: Influence of cytosolic conditions on thermodynamic state variables and kinetic parameters
Int. J. Mol. Sci. 21 (21), art. 7921
10.3390/ijms21217921
Immobilization of metribuzin degrading bacterial consortium MB3R on biochar enhances bioremediation of potato vegetated soil and restores bacterial community structure
J. Hazard. Mater. 390 , art. 121493
10.1016/j.jhazmat.2019.121493
Resilience trinity: safeguarding ecosystem functioning and services across three different time horizons and decision contexts
Oikos 129 (4), 445 - 456
10.1111/oik.07213
Highly efficient access to (S)-sulfoxides utilizing a promiscuous flavoprotein monooxygenase in a whole-cell biocatalyst format
ChemCatChem 12 (17), 4664 - 4671
10.1002/cctc.201901894
Quantifying the mineralization of 13C-labeled cations and anions reveals differences in microbial biodegradation of herbicidal ionic liquids between water and soil
ACS Sustain. Chem. Eng. 8 (8), 3412 - 3426
10.1021/acssuschemeng.9b07598
Hydrodechlorination of hexachlorobenzene in a miniaturized nano-Pd(0) reaction system combined with the simultaneous extraction of all dechlorination products
Appl. Catal. B-Environ. 275 , art. 119100
10.1016/j.apcatb.2020.119100
Molecular and engineering aspects of biocatalysis
Biotechnol. J. 15 (11), art. 2000499
10.1002/biot.202000499
Dehalococcoides-mediated B12-dependent reductive dehalogenation of aromatics does not proceed through outer-sphere electron transfer
Environ. Sci. Technol. 54 (24), 15751 - 15758
10.1021/acs.est.0c04404
Turnover of gram-negative bacterial biomass-derived carbon through the microbial food web of an agricultural soil
Soil Biol. Biochem. 152 , art. 108070
10.1016/j.soilbio.2020.1080702019 (136)
Floating treatment wetlands as a suitable option for large-scale wastewater treatment
Nat. Sustain. 2 (9), 863 - 871
10.1038/s41893-019-0350-y
Anaerobic degradation of 2,4,5-trichlorophenoxyacetic acid by enrichment cultures from freshwater sediments
Environ. Sci. Pollut. Res. 26 (33), 34459 - 34467
10.1007/s11356-019-06584-y
RNA-Seq analysis of soft rush (Juncus effusus): transcriptome sequencing, de novo assembly, annotation, and polymorphism identification
BMC Genomics 20 , art. 489
10.1186/s12864-019-5886-8
Unveiling the efficiency of vermicompost derived from different biowastes on wheat (Triticum aestivum L.) plant growth and soil health
Agronomy-Basel 9 (12), art. 791
10.3390/agronomy9120791
Hydraulic study of a non-steady horizontal sub-surface flow constructed wetland during start-up
Sci. Total Environ. 646 , 880 - 892
10.1016/j.scitotenv.2018.07.324
Hydrogen production from crude glycerol in an alkaline microbial electrolysis cell
Int. J. Hydrog. Energy 44 (32), 17204 - 17213
10.1016/j.ijhydene.2019.03.193
Syngas-aided anaerobic fermentation for medium-chain carboxylate and alcohol production: the case for microbial communities
Appl. Microbiol. Biotechnol. 103 (21-22), 8689 - 8709
10.1007/s00253-019-10086-9
Identification of nanoparticles and their localization in algal biofilm by 3D-imaging secondary ion mass spectrometry
J. Anal. At. Spectrom. 34 (6), 1098 - 1108
10.1039/c8ja00439k
Determination of microbial maintenance in acetogenesis and methanogenesis by experimental and modeling techniques
Front. Microbiol. 10 , art. 166
10.3389/fmicb.2019.00166
Modeling the relationship of aeration, oxygen transfer and treatment performance in aerated horizontal flow treatment wetlands
Water Res. 157 , 321 - 334
10.1016/j.watres.2019.03.062
Modeling dynamics of organic carbon and nitrogen removal during aeration interruption in aerated horizontal flow treatment wetlands
Water Sci. Technol. 80 (3), 597 - 606
10.2166/wst.2019.304
Microbial community drivers of PK/NRP gene diversity in selected global soils
Microbiome 7 , art. 78
10.1186/s40168-019-0692-8
Organic matter resources fuelling food webs in a human-modified lowland river: importance of habitat and season
Hydrobiologia 841 (1), 121 - 131
10.1007/s10750-019-04011-4
Microbial turnover of glyphosate to biomass: utilization as nutrient source and formation of AMPA and biogenic NER in an OECD 308 test
Environ. Sci. Technol. 53 (10), 5838 - 5847
10.1021/acs.est.9b01259
The impact of species, respiration type, growth phase and genetic inventory on absolute metal content of intact bacterial cells
Metallomics 11 (5), 925 - 935
10.1039/C9MT00009G
Estimation of the water cycle related to shale gas production under high data uncertainties: Dutch perspective
J. Environ. Manage. 231 , 483 - 493
10.1016/j.jenvman.2018.10.066
Quantitation and comparison of phenotypic heterogeneity among single cells of monoclonal microbial populations
Front. Microbiol. 10 , art. 2814
10.3389/fmicb.2019.02814
Enrichment of anaerobic methanotrophs in biotrickling filters using different sulfur compounds as electron acceptor
Environ. Eng. Sci. 36 (4), 431 - 443
10.1089/ees.2018.0283
Anaerobic methane oxidation coupled to sulfate reduction in a biotrickling filter: Reactor performance and microbial community analysis
Chemosphere 236 , art. 124290
10.1016/j.chemosphere.2019.07.021
Anaerobic oxidation of ethane by archaea from a marine hydrocarbon seep
Nature 568 (7750), 108 - 111
10.1038/s41586-019-1063-0
Hybridization of sugar-carboxylate-syngas platforms for the production of bio-alcohols from lignocellulosic biomass (LCB) – A state-of-the-art review and recommendations
Energy Conv. Manag. 200 , art. 112111
10.1016/j.enconman.2019.112111
Bacteria and micro‐eukaryotes are differentially segregated in sympatric wastewater microhabitats
Environ. Microbiol. 21 (5), 1757 - 1770
10.1111/1462-2920.14548
Guidelines for the use of flow cytometry and cell sorting in immunological studies (second edition)
Eur. J. Immunol. 49 (10), 1457 - 1973
10.1002/eji.201970107
Microbial fuel cell-based biosensors
Biosensors 9 (3), art. 92
10.3390/bios9030092
An essential thioredoxin-type protein of Trypanosoma brucei acts as redox-regulated mitochondrial chaperone
PLoS Pathog. 15 (9), e1008065
10.1371/journal.ppat.1008065
Cyt‐Geist: Current and Future Challenges in Cytometry: Reports of the CYTO 2018 Conference Workshops
Cytom. Part A 95 (6), 598 - 644
10.1002/cyto.a.23777
Cellular physiology controls photoautotrophic production of 1,2‐propanediol from pools of CO2 and glycogen
Biotechnol. Bioeng. 116 (4), 882 - 892
10.1002/bit.26883
Algal remodeling in a ubiquitous planktonic photosymbiosis
Curr. Biol. 29 (6), 968 - 978.e4
10.1016/j.cub.2019.01.073
iDS372, a phenotypically reconciled model for the metabolism of Streptococcus pneumoniae strain R6
Front. Microbiol. 10 , art. 1283
10.3389/fmicb.2019.01283
Cytometry score: 23 to 4
Cytom. Part A 95 (3), 259 - 260
10.1002/cyto.a.23713
Quantifying a biocatalytic product from a few living microbial cells using microfluidic cultivation coupled to FT-ICR-MS
Anal. Chem. 91 (11), 7012 - 7018
10.1021/acs.analchem.9b00978
Causes of variability in male vibratory signals and the role of female choice in Mantophasmatodea
Behav. Processes 166 , art. 103907
10.1016/j.beproc.2019.103907
Quantification of outer membrane vesicles: a potential tool to compare response in Pseudomonas putida KT2440 to stress caused by alkanols
Appl. Microbiol. Biotechnol. 103 (10), 4193 - 4201
10.1007/s00253-019-09812-0
Deiodination in the presence of Dehalococcoides mccartyi strain CBDB1: comparison of the native enzyme and co-factor vitamin B12
Environ. Sci. Pollut. Res. 26 (31), 32636 - 32644
10.1007/s11356-019-06505-z
Abiotic reductive deiodination of iodinated organic compounds and X-ray contrast media catalyzed by free corrinoids
Chemosphere 221 , 212 - 218
10.1016/j.chemosphere.2019.01.003
Long-term behavior of defined mixed cultures of Geobacter sulfurreducens and Shewanella oneidensis in bioelectrochemical systems
Front. Bioeng. Biotechnol. 7 , art. 60
10.3389/fbioe.2019.00060
Rapid calorimetric detection of bacterial contamination: Influence of the cultivation technique
Front. Microbiol. 10 , art. 2530
10.3389/fmicb.2019.02530
Cytosine N4-methylation via M.Ssp6803II is involved in the regulation of transcription, fine-tuning of DNA replication and DNA repair in the cyanobacterium Synechocystis sp. PCC 6803
Front. Microbiol. 10 , art. 1233
10.3389/fmicb.2019.01233
Mycelial effects on phage retention during transport in a microfluidic platform
Environ. Sci. Technol. 53 (20), 11755 - 11763
10.1021/acs.est.9b03502
Intramolecular isotopic evidence for bacterial oxidation of propane in subsurface natural gas reservoirs
Proc. Natl. Acad. Sci. U.S.A. 116 (14), 6653 - 6658
10.1073/pnas.1817784116
Electron balancing under different sink conditions reveals positive effects on photon efficiency and metabolic activity of Synechocystis sp. PCC 6803
Biotechnol. Biofuels 12 , art. 43
10.1186/s13068-019-1378-y
AgNPs change microbial community structures of wastewater
Front. Microbiol. 9 , art. 3211
10.3389/fmicb.2018.03211
Tapping renewables: a new dawn for organic electrosynthesis in aqueous reaction media
ChemElectroChem 6 (16), 4126 - 4133
10.1002/celc.201900456
Engineering electrochemical CO2 reduction to formate under bioprocess‐compatible conditions to bioreactor scale
ChemElectroChem 6 (14), 3731 - 3735
10.1002/celc.201900526
Combined use of ISCR and biostimulation techniques in incomplete processes of reductive dehalogenation of chlorinated solvents
Sci. Total Environ. 648 , 819 - 829
10.1016/j.scitotenv.2018.08.184
Temperature and stoichiometric dependence of phytoplankton traits
Ecology 100 (12), e02875
10.1002/ecy.2875
Adsorbent regeneration by non‐thermal plasma for elimination of odorous compounds from indoor air
Chem. Eng. Technol. 42 (5), 1144 - 1152
10.1002/ceat.201800317
Isotopic characterization (2H, 13C, 37Cl, 81Br) of abiotic degradation of methyl bromide and methyl chloride in water and implications for future studies
Environ. Sci. Technol. 53 (15), 8813 - 8822
10.1021/acs.est.9b02165
Stabilization and scale‐up of photosynthesis‐driven ω‐hydroxylation of nonanoic acid methyl ester by two‐liquid phase whole‐cell biocatalysis
Biotechnol. Bioeng. 116 (8), 1887 - 1900
10.1002/bit.27006
Mixed-species biofilms for high-cell-density application of Synechocystis sp. PCC 6803 in capillary reactors for continuous cyclohexane oxidation to cyclohexanol
Bioresour. Technol. 282 , 171 - 178
10.1016/j.biortech.2019.02.093
Light‐dependent and aeration‐independent gram‐scale hydroxylation of cyclohexane to cyclohexanol by CYP450 harboring Synechocystis sp. PCC 6803
Biotechnol. J. 14 (8), art. 1800724
10.1002/biot.201800724
Suitability of fecal sludge from composting toilets as feedstock for carbonization
Journal of Water, Sanitation and Hygiene for Development 9 (4), 616 - 626
10.2166/washdev.2019.047
Removal of hexadecane by hydroponic root mats in partnership with alkane-degrading bacteria: bacterial augmentation enhances system’s performance
Int. J. Environ. Sci. Technol. 16 (8), 4611 - 4620
10.1007/s13762-018-2165-1
Remediation of textile bleaching effluent by bacterial augmented horizontal flow and vertical flow constructed wetlands: A comparison at pilot scale
Sci. Total Environ. 685 , 370 - 379
10.1016/j.scitotenv.2019.05.414
Pre-treatment of filter cake for anaerobic digestion in sugarcane biorefineries: Assessment of batch versus semi-continuous experiments
Renew. Energy 143 , 1416 - 1426
10.1016/j.renene.2019.05.029
Evaluation of sequencing library preparation protocols for viral metagenomic analysis from pristine aquifer groundwaters
Viruses 11 (6), art. 484
10.3390/v11060484
Complete genome sequence of Pseudoalteromonas virus vB_PspP-H6/1 that infects Pseudoalteromonas sp. strain H6
Mar. Genom. 47 , art. 100667
10.1016/j.margen.2019.03.002
Can alkaline hydrolysis of γ-HCH serve as a model reaction to study its aerobic enzymatic dehydrochlorination by LinA?
Int. J. Mol. Sci. 20 (23), art. 5955
10.3390/ijms20235955
Genomic blueprints of sponge-prokaryote symbiosis are shared by low abundant and cultivatable Alphaproteobacteria
Sci. Rep. 9 , art. 1999
10.1038/s41598-019-38737-x
Salt-regulated accumulation of the compatible solutes sucrose and glucosylglycerol in cyanobacteria and its biotechnological potential
Front. Microbiol. 10 , art. 2139
10.3389/fmicb.2019.02139
Sated by a zero-calorie sweetener: Wastewater bacteria can feed on acesulfame
Front. Microbiol. 10 , art. 2606
10.3389/fmicb.2019.02606
Crystal structure of dihydro-heme d1 dehydrogenase NirN from Pseudomonas aeruginosa reveals amino acid residues essential for catalysis
J. Mol. Biol. 431 (17), 3246 - 3260
10.1016/j.jmb.2019.05.046
Biodiversity impact of green roofs and constructed wetlands as progressive eco‐technologies in urban areas
Sustainability 11 (20), art. 5846
10.3390/su11205846
Trophic networks improve the performance of microbial anodes treating wastewater
npj Biofilms Microbiomes 5 , art. 27
10.1038/s41522-019-0100-y
Sulfate deprivation triggers high methane production in a disturbed and rewetted coastal peatland
Biogeosciences 16 (9), 1937 - 1953
10.5194/bg-16-1937-2019
Disturbance size can be compensated for by spatial fragmentation in soil microbial ecosystems
Front. Ecol. Evol. 7 , art. 290
10.3389/fevo.2019.00290
Biofouling of membranes in microbial electrochemical technologies: Causes, characterization methods and mitigation strategies
Bioresour. Technol. 279 , 327 - 338
10.1016/j.biortech.2019.02.001
Comment on "Re-evaluation of the century-old Langmuir isotherm for modeling adsorption phenomena in solution", published by Azizian et al. [Chemical physics 513 (2018) 99–104]
Chem. Phys. 517 , 265 - 267
10.1016/j.chemphys.2018.10.007
Spotlight on the energy harvest of electroactive microorganisms: The impact of the applied anode potential
Front. Microbiol. 10 , art. 1352
10.3389/fmicb.2019.01352
Corrigendum: Spotlight on the energy harvest of electroactive microorganisms: The impact of the applied anode potential
Front. Microbiol. 10 , art. 2744
10.3389/fmicb.2019.02744
Key sub‑community dynamics of medium‑chain carboxylate production
Microb. Cell. Fact. 18 , art. 92
10.1186/s12934-019-1143-8
2H and 13C isotope fractionation analysis of organophosphorus compounds for characterizing transformation reactions in biogas slurry: Potential for anaerobic treatment of contaminated biomass
Water Res. 163 , art. 114882
10.1016/j.watres.2019.114882
Quantitative assessment of microbial necromass contribution to soil organic matter
Glob. Change Biol. 25 (11), 3578 - 3590
10.1111/gcb.14781
Mechanistic dichotomy in bacterial trichloroethene dechlorination revealed by carbon and chlorine isotope effects
Environ. Sci. Technol. 53 (8), 4245 - 4254
10.1021/acs.est.8b06643
Toward improved accuracy in chlorine isotope analysis: Synthesis routes for in-house standards and characterization via complementary mass spectrometry methods
Anal. Chem. 91 , 12290 - 12297
10.1021/acs.analchem.9b02463
Enantiomer and carbon isotope fractionation of α-hexachlorocyclohexane by Sphingobium indicum strain B90A and the corresponding enzymes
Environ. Sci. Technol. 53 (15), 8715 - 8724
10.1021/acs.est.9b01233
Neutral mechanisms and niche differentiation in steady-state insular microbial communities revealed by single cell analysis
Environ. Microbiol. 21 (1), 164 - 181
10.1111/1462-2920.14437
H2 kinetic isotope fractionation superimposed by equilibrium isotope fractionation during hydrogenase activity of D. vulgaris strain Miyazaki
Front. Microbiol. 10 , art. 1545
10.3389/fmicb.2019.01545
flowEMMi: an automated model-based clustering tool for microbial cytometric data
BMC Bioinformatics 20 , art. 643
10.1186/s12859-019-3152-3
Microbial community shifts in biogas reactors upon complete or partial ammonia inhibition
Appl. Microbiol. Biotechnol. 103 (1), 519 - 533
10.1007/s00253-018-9444-0
Photocalorespirometry (Photo-CR): A novel method for access to photosynthetic energy conversion efficiency
Sci. Rep. 9 , art. 9298
10.1038/s41598-019-45296-8
Secondary structure of DNA released from purified capsids of human parvovirus B19 under moderate denaturing conditions
J. Gen. Virol. 100 (5), 812 - 827
10.1099/jgv.0.001253
Resting Escherichia coli as chassis for microbial electrosynthesis: production of chiral alcohols
ChemSusChem 12 (8), 1631 - 1634
10.1002/cssc.201900413
Front cover: Resting Escherichia coli as chassis for microbial electrosynthesis: production of chiral alcohols (ChemSusChem 8/2019)
ChemSusChem 12 (8), 1478, 1482
10.1002/cssc.201900931
Comparative life cycle assessment of HTC concepts valorizing sewage sludge for energetic and agricultural use
Energies 12 (5), art. 786
10.3390/en12050786
Co-composting of the biogas residues and spent mushroom substrate: Physicochemical properties and maturity assessment
Bioresour. Technol. 276 , 281 - 287
10.1016/j.biortech.2018.12.097
Photoautotrophic production of succinate via the oxidative branch of the tricarboxylic acid cycle influences glycogen accumulation in Synechocystis sp. PCC 6803
Algal Res. 43 , art. 101645
10.1016/j.algal.2019.101645
Investigation of architecture development and phosphate distribution in Chlorella biofilm by complementary microscopy techniques
FEMS Microbiol. Ecol. 95 (4), fiz029
10.1093/femsec/fiz029
Effect of temperature, pH and total organic carbon variations on microbial turnover of 13C315N-glyphosate in agricultural soil
Sci. Total Environ. 658 , 697 - 707
10.1016/j.scitotenv.2018.12.195
Removal of pharmaceuticals and personal care products using constructed wetlands: effective plant-bacteria synergism may enhance degradation efficiency
Environ. Sci. Pollut. Res. 26 (21), 21109 - 21126
10.1007/s11356-019-05320-w
Vertical flow constructed wetlands for decentralized wastewater treatment in Jordan: Optimization of total nitrogen removal
Sci. Total Environ. 671 , 495 - 504
10.1016/j.scitotenv.2019.03.376
Side-by-side comparison of 15 pilot-scale conventional and intensified subsurface flow wetlands for treatment of domestic wastewater
Sci. Total Environ. 658 , 1500 - 1513
10.1016/j.scitotenv.2018.12.165
Bioprocess development for lantibiotic ruminococcin-A production in Escherichia coli and kinetic insights into LanM enzymes catalysis
Front. Microbiol. 10 , art. 2133
10.3389/fmicb.2019.02133
Identification of dominant sulfamethoxazole-degraders in pig farm-impacted soil by DNA and protein stable isotope probing
Environ. Int. 126 , 118 - 126
10.1016/j.envint.2019.02.001
Hybrid electrochemical and biological treatment of herbicidal ionic liquids comprising the MCPA anion
Ecotox. Environ. Safe. 181 , 172 - 179
10.1016/j.ecoenv.2019.05.084
Assessment of hexachlorcyclohexane biodegradation in contaminated soil by compound-specific stable isotope analysis
Environ. Pollut. 254 (Part A), art. 113008
10.1016/j.envpol.2019.113008
Comparison of different label-free imaging high-throughput biosensing systems for aptamer binding measurements using thrombin aptamers
Anal. Biochem. 583 , art. 113323
10.1016/j.ab.2019.05.012
Floating treatment wetlands as biological buoyant filters for wastewater reclamation
Int. J. Phytoremediat. 21 (13), 1273 - 1289
10.1080/15226514.2019.1633253
Summer comes to the Southern Ocean: how phytoplankton shape bacterioplankton communities far into the deep dark sea
Ecosphere 10 (3), e02641
10.1002/ecs2.2641
Biogas production from submerged macrophytes—a case study of regional biomass potentials in Germany
Energy Sustain. Soc. 9 , art. 21
10.1186/s13705-019-0204-5
Integrating electrochemistry into bioreactors: effect of the upgrade kit on mass transfer, mixing time and sterilizability
Front. Energy Res. 7 , art. 98
10.3389/fenrg.2019.00098
Marine probiotics: increasing coral resistance to bleaching through microbiome manipulation
ISME J. 13 (4), 921 - 936
10.1038/s41396-018-0323-6
Phragmites australis — a helophytic grass — can establish successful partnership with phenol-degrading bacteria in a floating treatment wetland
Saudi J. Biol. Sci. 26 (6), 1179 - 1186
10.1016/j.sjbs.2018.01.014
The simplified human intestinal microbiota (SIHUMIx) shows high structural and functional resistance against changing transit times in in vitro bioreactors
Microorganisms 7 (12), art. 641
10.3390/microorganisms7120641
Microbe-driven chemical ecology: past, present and future
ISME J. 13 (11), 2656 - 2663
10.1038/s41396-019-0469-x
Draft genome sequence of Brevibacillus sp. Strain LEMMJ03, isolated from an Antarctic volcano
Microbiol. Resour. Ann. 8 (40), e00921-19
10.1128/mra.00921-19
Identification of Clostridium cochlearium as an electroactive microorganism from the mouse gut microbiome
Bioelectrochemistry 130 , art. 107334
10.1016/j.bioelechem.2019.107334
Drought modulates interactions between arbuscular mycorrhizal fungal diversity and barley genotype diversity
Sci. Rep. 9 , art. 9650
10.1038/s41598-019-45702-1
Potentialities of floating wetlands for the treatment of polluted water of river Ravi, Pakistan
Ecol. Eng. 133 , 167 - 176
10.1016/j.ecoleng.2019.04.022
Enhanced degradation of hydrocarbons by gamma ray induced mutant strain of Pseudomonas putida
Biotechnol. Lett. 41 (3), 391 - 399
10.1007/s10529-019-02644-y
On-site performance of floating treatment wetland macrocosms augmented with dye-degrading bacteria for the remediation of textile industry wastewater
J. Clean Prod. 217 , 541 - 548
10.1016/j.jclepro.2019.01.258
Individual stages of bacterial dichloromethane degradation mapped by stable carbon and chlorine isotope analysis
J. Environ. Sci. 78 , 147 - 160
10.1016/j.jes.2018.09.008
Biophotovoltaics: green power generation from sunlight and water
Front. Microbiol. 10 , art. 866
10.3389/fmicb.2019.00866
Thermal proteome profiling allows quantitative assessment of interactions between tetrachloroethene reductive dehalogenase and trichloroethene
J. Proteomics 192 , 10 - 17
10.1016/j.jprot.2018.05.018
Anaerobic C-H oxyfunctionalization: Coupling of nitrate reduction and quinoline hydroxylation in recombinant Pseudomonas putida
Biotechnol. J. 14 (8), art. 1800615
10.1002/biot.201800615
Changes in bacterial diversity and catabolic gene abundance during the removal of dimethylphenol isomers in laboratory scale constructed wetlands
Appl. Microbiol. Biotechnol. 103 (1), 505 - 517
10.1007/s00253-018-9479-2
Microbial electrosynthesis system with dual biocathode arrangement for simultaneous acetogenesis, solventogenesis and carbon chain elongation
Chem. Commun. 55 (30), 4351 - 4354
10.1039/c9cc00208a
Sulfidation of ZVI/AC composite leads to highly corrosion-resistant nanoremediation particles with extended life-time
Sci. Total Environ. 665 , 235 - 245
10.1016/j.scitotenv.2019.02.136
Acceleration of microiron-based dechlorination in water by contact with fibrous activated carbon
Sci. Total Environ. 660 , 1274 - 1282
10.1016/j.scitotenv.2019.01.070
Constitutively solvent-tolerant Pseudomonas taiwanensis VLB120ΔCΔttgV supports particularly high styrene epoxidation activities when grown under glucose excess conditions
Biotechnol. Bioeng. 116 (5), 1089 - 1101
10.1002/bit.26924
Optimizing the metribuzin degrading potential of a novel bacterial consortium based on Taguchi design of experiment
J. Hazard. Mater. 366 , 1 - 9
10.1016/j.jhazmat.2018.11.054
Environmental risk or benefit? Comprehensive risk assessment of groundwater treated with nano Fe0-based Carbo-Iron®
Sci. Total Environ. 677 , 156 - 166
10.1016/j.scitotenv.2019.04.360
Augmenting biogas process modeling by resolving intracellular metabolic activity
Front. Microbiol. 10 , art. 1095
10.3389/fmicb.2019.01095
Immune modulation to enhance bone healing—A new concept to induce bone using prostacyclin to locally modulate immunity
Front. Immunol. 10 , art. 713
10.3389/fimmu.2019.00713
Ecological functions of agricultural soil bacteria and microeukaryotes in chitin degradation: A case study
Front. Microbiol. 10 , art. 1293
10.3389/fmicb.2019.01293
Tracing organic carbon and microbial community structure in mineralogically different soils exposed to redox fluctuations
Biogeochemistry 143 (1), 31 - 54
10.1007/s10533-019-00548-7
Effect of bioaugmentation on long-term biodegradation of diesel/biodiesel blends in soil microcosms
Sci. Total Environ. 671 , 948 - 958
10.1016/j.scitotenv.2019.03.431
Associational effects in the microbial neighborhood
ISME J. 13 (9), 2143 - 2149
10.1038/s41396-019-0444-6
Isotope fractionation approach to characterize the reactive transport processes governing the fate of hexachlorocyclohexanes at a contaminated site in India
Environ. Int. 132 , art. 105036
10.1016/j.envint.2019.105036
A concept for studying the transformation reaction of Hexachlorocyclohexanes in food webs using multi-element compound-specific isotope analysis
Anal. Chim. Acta 1064 , 56 - 64
10.1016/j.aca.2019.03.030
Effect of reduced sulfur species on chemolithoautotrophic pyrite oxidation with nitrate
Geomicrobiol. J. 36 (1), 19 - 29
10.1080/01490451.2018.1489915
Structures of 2-Hydroxyisobutyric Acid-CoA ligase reveal determinants of substrate specificity and describe a multi-conformational catalytic cycle
J. Mol. Biol. 431 (15), 2747 - 2761
10.1016/j.jmb.2019.05.027
Helophyte mats (wetland roofs) with high evapotranspiration rates as a tool for decentralised rainwater management – process stability improved by simultaneous greywater treatment
Water Supply 19 (3), 808 - 814
10.2166/ws.2018.126
Wetland roofs as an attractive option for decentralized water management and air conditioning enhancement in growing cities—a review
Water 11 (9), art. 1845
10.3390/w11091845
Carbon and hydrogen isotopic fractionation during abiotic hydrolysis and aerobic biodegradation of phthalate esters
Sci. Total Environ. 660 , 559 - 566
10.1016/j.scitotenv.2019.01.003
Spatial separation of metabolic stages in a tube anaerobic baffled reactor: reactor performance and microbial community dynamics
Appl. Microbiol. Biotechnol. 103 (9), 3915 - 3929
10.1007/s00253-019-09767-2



